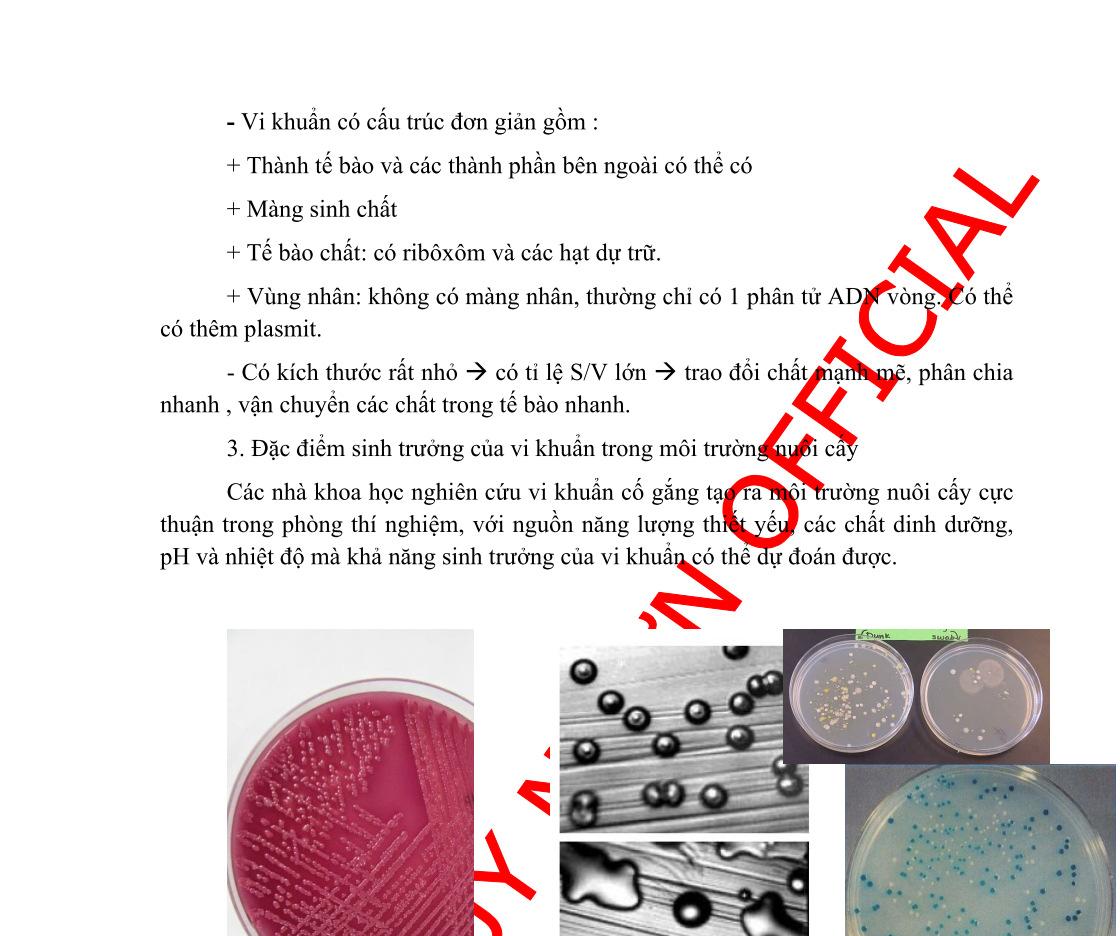

CHUYÊN ĐỀ MÔN SINH HỌC DUYÊN HẢI BẮC BỘ Ths Nguyễn Thanh Tú eBook Collection CÁC CHUYÊN ĐỀ MÔN SINH HỌC ĐẠT GIẢI TẠI HỘI THẢO CÁC TRƯỜNG CHUYÊN KHU VỰC DUYÊN HẢI BẮC BỘ NĂM 2022 Chuyên đề Một số nội dung tích hợp hóa sinh, vi sinh và di truyền WORD VERSION | 2023 EDITION ORDER NOW / CHUYỂN GIAO QUA EMAIL TAILIEUCHUANTHAMKHAO@GMAIL.COM Hỗ trợ trực tuyến Fb www.facebook.com/DayKemQuyNhon Mobi/Zalo 0905779594 Tài liệu chuẩn tham khảo Phát triển kênh bởi Ths Nguyễn Thanh Tú Đơn vị tài trợ / phát hành / chia sẻ học thuật : Nguyen Thanh Tu Group vectorstock com/28062415
CÁC CHUYÊN ĐỀ MÔN SINH HỌC ĐẠT GIẢI TẠI HỘI THẢO KHOA HỌC CÁC TRƯỜNG CHUYÊN KHU VỰC DUYÊN HẢI VÀ ĐỒNG BẰNG BẮC BỘ
NĂM 2022
- Giải Nhất: Chuyên đề Tích hợp di truyền hoá sinh vi sinh vật, tác giả Đỗ Thuỳ Dung, Trần Thị Loan, trường THPT Chuyên Lào Cai (trang 2 – 132)
- Giải Nhì: Chuyên đề Một số vấn đề Tích hợp Hóa sinh – vi sinh – di truyền học vi khuẩn, tác giả Nguyễn Thị Cúc, trường THPT Chuyên Biên Hòa, Hà Nam (trang 133 –234)
- Giải Nhì: Chuyên đề Tích hợp di truyền hóa vi sinh vật, tác giả Nguyễn Mạnh Quỳnh, Nguyễn Thị Thu Trang, trường THPT Chuyên Thái Nguyên, Thái Nguyên (trang 235 – 324)
- Giải Ba: Chuyên đề Một số nội dung tích hợp hóa sinh, vi sinh và di truyền, tác giả Nguyễn Thị Thu, trường THPT Chuyên Bắc Giang, Bắc Giang (trang 325 – 411)
- Giải Ba: Chuyên đề Tích hợp hóa sinh, vi sinh và di truyền, trường THPT Chuyên Hoàng Văn Thụ, Hòa Bình (trang 412 – 482)
- Giải Ba: Chuyên đề Hệ thống Lý thuyết và bài tập tích hợp hóa sinh, vi sinh, di truyền, trường THPT Chuyên Lê Khiết, Quảng Ngãi (trang 483 – hết)
DẠYKÈMQUYNHƠN
1
OFFICIAL
Chuyên đề
TÍCH HỢP DI TRUYỀN HOÁ SINH VI SINH VẬT Đỗ Thuỳ Dung, Trần Thị Loan - Trường THPT Chuyên Lào Cai Chuyên đề đạt giải Nhất
OFFICIAL
1. Lí do tiếp cận chuyên đề Vi sinh vật không phải là một khái niệm phân loại, các vi sinh vật có thể thuộc những nhóm phân loại rất xa nhau. Chúng thường có một số đặc điểm chung như có kích thước hiển vi, cơ thể đơn bào, sinh trưởng nhanh, phân bố rộng, thích ứng cao với môi trường. Thuộc nhóm Vi sinh vật có vi khuẩn (thuộc Giới Vi khuẩn), động vật nguyên sinh và vi tảo (thuộc Giới Nguyên sinh) và Vi nấm (thuộc Giới Nấm), vi sinh vật cổ (thuộc lãnh Giới Vi sinh cổ theo quan điểm phân chia 3 lãnh Giới). Ngoài ra, người ta còn xếp virut vào nhóm Vi sinh vật mặc dù hiện nay virut không được xem là cơ thể sống vì chúng không có cấu tạo tế bào và có đời sống kí sinh bắt buộc trong tế bào. Virut không tồn tại và sống trong môi trường tự nhiên khi ở ngoài tế bào. Vi sinh vật có vai trò quan trọng đối với hệ sinh thái cũng như đời sống con người. Việc nghiên cứu di truyền học trên các đối tượng vi sinh vật chưa được tiến hành cho mãi đến những năm 40. Tuy ra đời chậm nhưng di truyền học vi sinh vật đã đóng vai trò “cách mạng hoá” tạo ra những bước tiến nhảy vọt cho di truyền học nói riêng và sinh học nói chung về cả phương diện lí thuyết và ứng dụng thực tiễn. Các nghiên cứu di truyền được tiến hành một mặt trên các vi sinh vật nhân thực như nấm men, nấm mốc, vi tảo có sinh sản hữu tính, mặt khác trên các vi khuẩn và virut. Di truyền học của virut và vi khuẩn đã góp phần đáng kể cho sự ra đời của kĩ thuật tái tổ hợp DNA dẫn đến kĩ thuật di truyền làm bùng nổ Công nghệ sinh học.
Hoá sinh học là ngành khoa học nghiên cứu đến cấu trúc và quá trình hoá học diễn ra trong cơ thể sinh vật. Đây là nội dung có liên quan chặt chẽ với các kiến thức hoá học, sinh học, mà phần lớn là sinh học tế bào, sinh học phân tử và di truyền. Kiến thức phần hoá sinh học có ý nghĩa tiên quyết tạo nền tảng đi sâu vào giải quyết các vấn đề đặc biệt quan trọng trong y dược và công nghệ sinh học. Hoá sinh học được chia thành hai lĩnh vực chính: Hoá sinh tĩnh và hoá sinh động. Hoá sinh tĩnh nghiên cứu các vấn đề thuộc về enzyme và các hợp chất hữu cơ. Tế bào chính là đơn vị nhỏ nhất của sự sống - nơi diễn ra hoạt động hoá sinh to lớn được gọi là sự trao đổi chất. Đây là quá trình thay đổi hoá học và vật lí diễn ra liên tục trong sinh vật sống bao gồm quá trình xây dựng mô mới, thay thế mô cũ, chuyển đổi thức ăn thành năng lượng, xử lý chất thải, sinh sản, ...Để quá trình trao đổi chất được diễn ra thuận lợi thì vai trò của enzyme là không thể thiếu. Sự hoạt động của hợp chất có hoạt tính sinh học cao này giúp cho các phản ứng diễn ra trong quá trình trao đổi chất diễn ra dễ dàng và thuận lợi hơn, tạo thành một hệ thống hoàn chỉnh. Các phản ứng hoá học diễn ra trong tế bào có sự tham gia của các hợp chất hữu cơ: protein, cacbonhidrat, lipid và axit nucleic, ... Một khía cạnh khác của hoá sinh học là nghiên cứu về tính chất và các đặc tính sinh học của các đại phân tử đó. Đó là xác định các thành phần tạo nên những cấu trúc lơn hơn phân tử,
DẠYKÈMQUYNHƠN
2
mô tả cách lắp ráp, quan sát không gian ba chiều và mô tả vai trò của chúng trong sự sống sinh vật. Hoá sinh động nghiên cứu các quá trình trao đổi saccarit, lipit, tổng hợp DNA, RNA, protein. Một trong những dấu hiệu đặc trưng cơ bản của sinh vật sống là sự trao đổi chất và năng lượng. Như đã nói ở trên, hoá sinh động sẽ xem xét cách thức các tế bào sản xuất ra năng lượng từ các hợp chất hữu cơ. Thông qua nguyên tắc của sự biến đổi năng lượng trong tế bào, các con đường dị hoá phân tử glucose sẽ được mô tả trong sự có mặt hoặc vắng mặt oxi phân tử. Cùng với đó, vai trò của lipit trong cung cấp và dự trữ năng lượng cho sinh vật cũng được làm sáng tỏ, thông qua đó xây dựng mối quan hệ trong con đường trao đổi chất giữa lipit và saccarit. Trong tế bào, quá trình tổng hợp DNA, RNA, protein là yếu tố cơ bản cấu thành nên toàn hệ sinh vật. Hoá sinh động cũng đề cập đến những nét cơ bản của nhân đôi DNA, phiên mã, dịch mã. Nhân loại đang sống ở thời kì Công nghệ sinh học. Di truyền học đi sâu vào các vấn đề cơ bản của sự tồn tại và lưu truyền sự sống nên nó giữ một vị trí đặc biệt quan trọng, có người ví "Di truyền học là trái tim của Sinh học", vì không ít thì nhiều, nó liên quan và chi phối bất kì lĩnh vực nào của sinh học, từ các cơ chế phân tử của sự sống cho đến sự tiến hóa của toàn bộ thế giới sinh vật trên hành tinh của chúng ta Những phát minh lớn với số lượng tăng vọt của di truyền học đã có tác dụng cách mạng hóa sinh học, biến sinh học từ mô tả thành thực nghiệm chính xác. Hội nghị Di truyền học thế giới ở Toronto (Canada) năm 1988 đã nêu phương châm "Di truyền học hóa" Sinh học. Các đối tượng vi sinh vật đã góp phần chủ yếu vào các phát minh nền tảng không những của di truyền học phân tử, mà của sinh học phân tử và sinh học hiện đại nói chung.
OFFICIAL
Đối với các trường THPT Chuyên, việc lựa chọn, phát hiện và bồi dưỡng học sinh giỏi, học sinh năng khiếu là một trong những nhiệm vụ then chốt. Với nguồn học liệu dồi dào và mở như hiện nay, học sinh khối lớp Chuyên Sinh có thể tiếp cận được nguồn tri thức nhanh chóng và hiệu quả, tuy nhiên việc lựa chọn những nội dung kiến thức trọng tâm, có tính chất hệ thống làm cơ sở nền tảng phát huy khả năng tự học, tự đọc của học sinh vẫn đang là vấn đề cần được quan tâm đầu tư. Qua quá trình tự nghiên cứu, tôi tự nhận thấy mức độ tích hợp các nội dung kiến thức Sinh học trong các câu hỏi ở đề thi học sinh giỏi các cấp, đặc biệt là kì thi học sinh giỏi Quốc gia ngày càng tăng lên về số lượng và độ “khó”. Vì vậy, với mục đích bổ sung thêm nguồn học liệu có tính chất hệ thống, định hướng cho học sinh cách thức tiếp cận và tư duy logic đối với kiến thức phần Hoá sinh, vi sinh và di truyền, tôi lựa chọn và tiếp cận chuyên đề “Tích hợp di truyền hoá sinh vi sinh vật”
2. Mục đích của chuyên đề - Hệ thống hoá nội dung kiến thức phần hoá sinh, vi sinh và di truyền trên phương diện tiếp cận “sự tích hợp”.
DẠYKÈMQUYNHƠN
3
- Biên soạn chuyên đề để nâng cao hiệu quả tự học của cá nhân, cung cấp thêm nguồn tài liệu cho học sinh trong đội tuyển.
- Rèn luyện khả năng tự học, tự đọc tài liệu và khai thác kiến thức
- Hướng dẫn học sinh cách thức phân tích nội hàm trong các câu hỏi, tránh trả lời không đúng trọng tâm
3. Khái quát nội dung chuyên đề
Chuyên đề được biên soạn thành 2 phần: Phần A: Cơ sở lý thuyết và phần B: Câu hỏi, bài tập vận dụng.
Phần Cơ sở lí thuyết chuyên đề nghiên cứu các nội dung phần hoá sinh tế bào vi sinh vật và hiện tượng di truyền ở vi sinh vật.
Phần Câu hỏi, bài tập vận dụng sưu tầm chủ yếu trong các đề thi học sinh giỏi Quốc gia các năm, hướng dẫn phân tích kiến thức lí thuyết và trả lời.
OFFICIAL
DẠYKÈMQUYNHƠN
4
NỘI DUNG PHẦN A: CƠ SỞ LÝ THUYẾT
I. THÀNH PHẦN HOÁ SINH TẾ BÀO VI SINH VẬT
1. Enzyme
1.1. Cấu trúc enzyme
Enzyme có bản chất là protein (một số ít là RNA - ribozim), có tác dụng xúc tác, làm tăng tốc độ phản ứng một cách đặc hiệu. Enzyme có mặt trong tất cả các hoạt động sống của tế bào, có đầy đủ đặc tính lý hoá của một chất xúc tác.
- Tính đặc hiệu cao: enzyme thường đặc trưng cho một phản ứng nhất định. Ví dụ enzyme ureaza chỉ xúc tác phản ứng phân giải ure. Một số enzyme khác cũng có tính đặc hiệu tương đối, chẳng hạn enzyme lipase có khả năng phân huỷ nhiều loại este khác nhau.
- Hiệu suất xúc tác lớn: tốc độ phản ứng có thể tăng lên 105 - 107 lần so với khi không có chất xúc tác. Ví dụ enzyme catalase xúc tác phản ứng phân huỷ H2O2 -> H2O + O2 chỉ trong một giây nhưng với chất xúc tác là Fe thì cần đến 300 năm.
- Tác dụng xúc tác ở điều kiện bình thường: pH môi trường gần trung tính, áp suất và nhiệt độ bình thường.
Enzyme được chia thành 6 lớp dựa vào kiểu xúc tác (theo thống nhất của Hội hoá sinh học quốc tế năm 1961).
A - Oxidoreductase: xúc tác cho phản ứng oxi hoá khử (vận chuyển điện tử, các ion hydride hoặc nguyên tử hidro)
B - Transferase: xúc tác cho phản ứng chuyển vị các nhóm từ một phân tử này đến một phân tử khác.
C- Hydrolase: Xúc tác các phản ứng thuỷ phân (cũng là phản ứng vận chuyển các nhóm chức năng)
D - Lyase: xúc tác cho các phản ứng thêm các nhóm vào nối đôi, hoặc tạo thành nối đôi bằng cách loại các nhóm.
E - Isomerase: xúc tác cho các phản ứng đồng phân hoá, hoặc chuyển vị các nhóm trong nội bộ phân tử thành các dạng đồng phân.
F - Ligase: xúc tác cho các phản ứng tạo thành liên kết C-C, C-O, C-S và C-N bằng phản ứng ngưng tụ, kèm theo phản ứng cắt đứt các liên kết giàu năng lượng của các nucleoside triphotphate, thường dấu hiệu nhận biết của kiểu enzyme này với lyase có sự xuất hiện của ATP.
Cấu trúc enzyme: Enzyme là các đại phân tử có khối lượng phân tử từ 12000 đến hàng triệu đơn vị Dalton (Da). Cũng như các protein, về thành phần cấu tạo, enzyme chia thành 2 loại: enzyme một thành phần và enzyme hai thành phần. Enzyme
DẠYKÈMQUYNHƠN
5
OFFICIAL
một thành phần: chỉ có một thành phần duy nhất là protein như enzyme pepsin của dạ dày. Enzyme hai thành phần (haloenzyme) gồm 2 thành phần: phần protein gọi là apoenzyme, phần không phải protein là cofactor (hoặc coenzyme). Hầu hết phần ngoại protein có chức năng xúc tác apoenzyme. Coenzyme là các dẫn xuất của vitamin hoà tan trong nước (ví dụ NAD+) vì vậy khi thiếu một vitamin nào đó, gây nên những bệnh đặc trưng (chẳng hạn như bệnh pellagra, Scorbut, ...). Cofactor là các ion kim loại với hàm lượng nhỏ (các nguyên tố vi lượng như Cu2+ có trong cytocrom oxidase, carbonic anhydrase, alcohol dehydrogenaza chứa Zn2+, hexokinase, glucose - 6 - phosphatease, pyruvate kinase chứa Mg2+, ....)
Trung tâm hoạt động là một vùng đặc biệt của enzyme có tác dụng gắn với cơ chất để xúc tác cho phản ứng biến đổi cơ chất thành sản phẩm. Mỗi enzyme có thể có một hoặc hai hay nhiều trung tâm hoạt động. Tại đây sẽ chứa những nhóm hoá học và những liên kết tiếp xúc trực tiếp với cơ chất hoặc không tiếp xúc trực tiếp nhưng có chức năng trực tiếp trong quá trình xúc tác.
OFFICIAL
Về thành phần cấu tạo: Trung tâm hoạt động của enzyme thường bao gồm các axit amin có các nhóm hoá học có hoạt tính cao như serine (có nhóm -OH), cystein (có nhóm SH), glutamate có nhóm y-COO), lysine (có nhóm S-NH3 +) histidine có nhóm imidazol+, tryptophan có nhóm indol+, ... đây là những nhóm phân cực hoặc ion hoá, có khả năng tạo liên kết hidro hoặc ion với cơ chất.
Để mô tả sự liên kết giữa enzyme và cơ chất, đã có nhiều giả thuyết được đưa ra: Thuyết “mô hình cảm ứng không gian” được Koshland D đưa ra năm 1958 đã giải thích tính đặc hiệu tương đối của enzyme. Theo thuyết này, trung tâm hoạt động của enzyme có tính mềm dẻo và linh hoạt, có thể biến đổi về cấu hình không gian trong quá trình hoạt động tương tác với cơ chất sao cho phù hợp với cấu hình không gian của cơ chất, để có thể hình thành phức hợp enzyme cơ chất (ES).
Enzyme dị lập thể (Enzyme allosteric)
Đây là loại enzyme ngoài trung tâm hoạt động còn có một vài vị trí dị lập thể, trung tâm hoạt động tiếp nhận cơ chất để xúc tác cho phản ứng enzyme trong khi vị trí dị lập thể tiếp nhận yếu tố dị lập thể để điều chỉnh hoạt động xúc tác của enzyme. Phân tử enzyme dị lập thể có thể có thể có vị trí dị lập thể dương, vị trí lập thể âm hoặc chứa cả hai. Khi vị trí dị lập thể dương tiếp nhận yếu tố dị lập thể dương A (chất hoạt hóa) thì cấu hình enzyme thay đổi theo hướng có lợi hơn, enzyme được hoạt hóa, ái lực enzyme với cơ chất tăng lên, tăng tốc độ phản ứng. Khi vị trí dị lập thể âm tiếp nhận yếu tố dị lập thể âm (chất ức chế) thì cấu hình enzyme thay đổi theo hướng có hại, enzyme bị ức chế, ái lực enzyme với cơ chất giảm nên tốc độ phản ứng giảm đi. Thông thường, những chất hoạt hóa dị lập thể là những chất đứng trước cơ chất trong chuỗi phản ứng, trong khi những chất ức chế dị lập thể là những chất đứng sau chuỗi phản ứng hoặc là sản phẩm cuối cùng của chuỗi phản ứng. Chẳng hạn, trong con đường đường phân, enzyme phospho fructokinase là một enzyme dị lập thể được hoạt
DẠYKÈMQUYNHƠN
6
hóa bởi yếu tố dị lập thể dương là ADP và AMP, nhưng bị ức chế bởi yếu tố dị lập thể
âm là ATP và citrate.
1.2. Cơ chế tác động
Enzyme thực hiện chức năng xúc tác làm tăng tốc độ phản ứng bằng cách giảm năng lượng hoạt hóa gồm 2 giai đoạn chính:
- Tạo thành phức ES.
- Phân ly phức ES giải phóng E ở trạng thái ban đầu, giải phóng sản phẩm.
OFFICIAL
Hình 1: Cơ chế tác động của enzyme

Khi có mặt cơ chất, cơ chất cảm ứng sự định hướng không gian của các nhóm chức trong trung tâm hoạt động của E, tạo nên sự định hướng tương ứng thích hợp giữa các nhóm chức trong TTHĐ của E và các nhóm chức của cơ chất, dọn đường cho S kết hợp vào TTHĐ của E, tạo thành phức ES, đồng thời loại các phân tử nước ra ngoài. Tương tác giữa các gốc amino acid của E với cơ chất, thay đổi đám mây electron, giảm năng lượng hoạt hóa cần thiết để đưa đến trạng thái chuyển tiếp.
Hình 2: Enzyme làm giảm năng lượng hoạt hoá Phức ES sau khi tạo thành kém bền, chỉ tồn tại trong thời gian ngắn và nhanh chóng chuyển hóa thành sản phẩm và giải phóng E tự do, E lại quay vòng xúc tác như ban đầu.

DẠYKÈMQUYNHƠN
7
Năng lượng hoạt hóa là sự sai khác giữa mức năng lượng tự do của trạng thái cơ bản (ground state) và trạng thái chuyển tiếp (transition state), được hình thành do sự tiếp xúc, và chạm giữa các phân tử làm tăng tốc độ phản ứng.
1.3. Các yếu tố ảnh hưởng đến vận tốc của enzyme
1.3.1. Nhiệt độ
Mỗi enzyme hoạt động trong một khoảng nhiệt độ nhất định, đa số các enzyme tối ưu ở nhiệt độ 40 - 45°C. Khi cao hơn nhiệt độ tối ưu, tốc độ phản ứng giảm nhanh vì nhiệt độ cao làm enzyme biến tính, trung tâm hoạt động mất đi cấu hình chuẩn và không còn phù hợp được với cơ chất, vai trò xúc tác bị ảnh hưởng. Cá biệt có những enzyme chịu được nhiệt độ cao như amylase trong công nghiệp dệt chịu được nhiệt độ hơn 100°C. Loài cá băng ở Nam cực có enzyme hoạt động hiệu quả ở -2°C. 1.3.2. Độ pH Mỗi loại enzyme có một độ pH tối ưu, pH trên hay dưới ngưỡng tối ưu đều làm cho hoạt tính enzyme bị giảm hoặc mất hoạt tính. pH ảnh hưởng đến trạng thái ion hóa các gốc R của các gốc amino acid trong phân tử E, ion hóa các nhóm chức trong trung tâm hoạt động, ion hóa cơ chất, do đó ảnh hưởng đến hai tham số động học Km và V.

OFFICIAL
Hình 3: Ảnh hưởng của độ pH đến hoạt tính enzyme
1.3.3. Nồng độ cơ chất
Cơ chất là chất mà enzyme xúc tác. Sự thay đổi nồng độ cơ chất khác nhau sẽ ảnh hưởng rất lớn đến hoạt độ của enzyme. Khi nồng độ cơ chất thấp, nhiều phân tử enzyme có trung tâm hoạt động tự do và sự cung cấp hạn chế có chất sẽ xác định tốc độ phản ứng. Ngược lại nồng độ cơ chất cao, hầu hết các trung tâm hoạt động bị chiếm lĩnh do đó lúc này số lượng phân tử enzyme lại là yếu tố quyết định phản ứng. Trong hoạt động trao đổi chất của tế bào mối tương quan này có tầm quan trọng như những phương thức kiểm soát tốc độ phản ứng khác nhau.
DẠYKÈMQUYNHƠN
8
Hình 4: Mối liên hệ giữa tốc độ phản ứng và nồng độ cơ chất 1.3.4. Ảnh hưởng của chất kìm hãm Chất kiềm hãm (Inhibitor = I) là những chất làm giảm tốc độ phản ứng do enzyme xúc tác. Các chất này có thể là ion kim loại, chất hữu cơ hay vô cơ. Các chất kìm hãm có thể chia theo nhiều cách khác nhau: kìm hãm thuận nghịch hay kìm hãm không thuận nghịch.
a. Kìm hãm thuận nghịch
Kìm hãm thuận nghịch là kìm hãm enzyme bằng cách kết hợp với enzyme và tác động đến sự kết hợp của E với S.

* Kìm hãm cạnh tranh
Kìm hãm cạnh tranh: Chất ức chế liên kết vào trung tâm hoạt động của enzyme (cạnh tranh với cơ chất). Nhận biết: Km tăng (ái lực giảm) và Vmax không đổi.
* Kìm hãm không cạnh tranh
- Kìm hãm không cạnh tranh: Chất ức chế liên kết phức hợp enzyme có chất (không phải enzyme tự do) ở vị trí khác trung tâm hoạt động ảnh hưởng đến đến trung tâm hoạt động dẫn đến giảm hoạt tính xúc tác của enzyme. Nhận biết Km không thay đổi và Vmax giảm.
* Kìm hãm hỗn hợp
- Kìm hãm kiểu hỗn hợp: Chất ức chế đồng thời liên kết được vào cả tâm hoạt động và vị trí khác (enzyme tự do và phức hợp enzyme - cơ chất). Nhận biết: đồng thời Km tăng (hoặc ái lực giảm) và Vmax giảm.
b. Các chất kìm hãm không thuận nghịch
Các không thuận nghịch kết hợp với E tạo thành phức EI không hoạt động, không phân ly, hoặc rất khó phân ly, hoặc phân ly với vận tốc không đáng kể. Người ta ứng dụng các chất kìm hãm không thuận nghịch để nghiên cứu cơ chế phản ứng của enzyme.
DẠYKÈMQUYNHƠN
9
OFFICIAL
1.4. Điều hoà hoạt độ của enzyme
Hoạt độ của enzyme, cũng như hoạt độ của các protein có hoạt tính sinh học khác trong tế bào. Chúng phải được điều hòa nghiêm ngặt, tiến hành đúng chỗ, đúng lúc và với mức vừa đủ theo yêu cầu của cơ thể.

Hoạt độ của E được điều hòa cả về số lượng và hoạt độ phân tử. Gọi là điều hòa hoạt độ phân tử có nghĩa là số lượng phân tử protein E được tổng hợp là không thay đổi. Hoạt độ của enzyme có thể bị thay đổi bằng cách kết hợp với chất điều hòa (điều hòa allosteric); hoặc cải biến cộng hóa trị thuận nghịch; hoặc thay đổi tỷ lệ giữa các dạng phân tử enzyme có mức độ hoạt động khác nhau, ... 1.4.1. Điều hòa Allosteric Kiểu điều hòa này hoạt động dựa trên nhu cầu của tế bào. Khi lượng sản phẩm cuối cùng của chu trình đáp ứng đủ cho tế bào, nó sẽ quay ngược trở lại kìm hãm hoạt độ enzyme.
OFFICIAL
Hình 5: Mô hình điều hòa allosteric dưới tác dụng của sản phẩm cuối cùng khi nồng độ các chất này đã đáp ứng nhu cầu.
1.4. 2. Điều hòa tỷ lệ các dạng khác nhau của enzyme có hoạt độ khác nhau Isozyme (hay còn gọi là isoenzyme) là các enzyme khác nhau trong chuỗi amino acid nhưng xúc tác cho phản ứng hóa học tương tự. Các enzyme này thường hiển thị các thông số động học khác nhau (ví dụ các giá trị K và V khác nhau) hoặc các đặc tính điều chỉnh khác nhau. Sự tồn tại của isozyme cho phép tinh chỉnh sự trao đổi chất để đáp ứng nhu cầu cụ thể của một mô hoặc giai đoạn phát triển.
DẠYKÈMQUYNHƠN
10
Hình 6: Enzyme hexokinase xúc tác phản ứng
Enzyme hexokinase xúc tác cho phản ứng trên gồm 4 isoenzyme (kí hiệu I, II, III và IV). Khi nồng độ glucose trong mức bình thường, các isoenzyme III hoạt động với tốc độ cực đại, còn IV chỉ làm việc 25%.
1.4. 3. Cải biến cộng hóa trị Chủ yếu hoạt động cải biến hóa trị là kết hợp thuận nghịch với nhóm phosphate. Với các đặc điểm phổ biến:
- Phản ứng chuyển nhóm phosphoryl từ ATP đến enzyme do protein kinase xúc tác còn phản ứng tách phosphate khỏi enzyme do protein phosphatase xúc tác.
- Các gốc amino acid của enzyme kết hợp với nhóm phosphoryl là: Tyr, Ser, Thr, His.
- Việc kết hợp với nhóm phosphate có thể chuyển enzyme từ dạng có hoạt động thấp thành dạng có dạng hoạt động cao hay ngược lại. Ví dụ: Cơ chế điều hòa của glycogen phosphorylase. Protein kinase (PKA) có vai trò điều hòa hoạt độ enzyme bằng cách phosphoryl hóa. Với cách điều hòa này, tín hiệu điều hòa có thể khuếch đại nhiều lần vì protein kinase có thể tác dụng lên nhiều phân tử mục tiêu khác nhau.
2. Các hợp chất hữu cơ
2.1. Saccharide
Saccharide là một chất hữu cơ chứa 3 nguyên tử là carbon (C), oxy (O) và hydro (H). Các đơn vị cơ bản của saccaride được gọi là monosaccharide, ví dụ như glucose, galactose, và fructose. Công thức thu gọn tổng quát của một monosaccaride là (CH2O)n với n lớn hơn hoặc bằng 3; tuy nhiên, không phải tất cả saccharide đều tuân theo công thức này (như acid uronic), hoặc không phải tất cả các chất hóa học có công thức như trên thì được xếp vào nhóm saccharide. Monosaccharide có thể được liên kết với nhau để tạo thành polysaccharide (hay oligosaccharide) theo nhiều cách khác nhau. Saccharide giữ nhiều vai trò quan trọng trong cơ thể sống như:

- Chúng tồn tại ở dạng dự trữ năng lượng, nhiên liệu và chất trao đổi trung gian (glucose, glycogen, ...).
- Một số loại đường như ribose và deoxyribose tạo thành một phần trong cấu trúc của RNA và DNA (vật chất di truyền của hầu hết sinh vật trên Trái Đất).
DẠYKÈMQUYNHƠN
11
OFFICIAL
- Tham gia cấu tạo các thành phần cấu trúc của thành tế bào vi khuẩn và thực vật (cellulose).
- Saccharide liên kết với một số protein và lipid, các chất này có ý nghĩa trong việc tương tác gián tiếp giữa các tế bào và sự tương tác giữa các tế bào với các thành phần khác trong môi trường của tế bào (proteoglycan, glycoprotein, glycolipid, ...).
a. Đường đơn (Monosaccharide): là dẫn xuất của aldehyde, hoặc ketone và hai hay nhiều nhóm hydroxyl (-OH). Mỗi phân tử có từ 3 đến 7 cacbon và chia thành hai nhóm chính là đường aldose và ketose.

- Đường aldose: là đường chứa nhóm carbonyl là aldehyde (-CHO)
- Đường ketose: là đường chứa nhóm carbonyl là ketone (-CO-)
OFFICIAL
Hình 7: Đường aldose và ketose
- Tính chất: vị ngọt, tan nhiều trong nước, có tính khử mạnh, tham gia các phản ứng oxi hoá-khử
- Vai trò:
+ Cung cấp năng lượng cho tế bào, ví dụ đường glucose.
+ Là nguyên liệu để tạo đường đôi, đường đa; tham gia cấu tạo các thành phần của tế bào, ví dụ đường pentose tham gia cấu tạo DNA, RNA.
+ Dùng trong các sản phẩm chữa bệnh như xylitol hay chẩn đoán bệnh như xác định lượng glucose trong máu.
b. Đường đôi (Disaccharide)
Disaccharide được cấu tạo từ hai monosaccharide, ví dụ như sucrose và lactose. Chúng liên kết với nhau bằng một liên kết cộng hóa trị tạo thành từ phản ứng khử nước (hydrolase), theo đó sẽ tách ra một nguyên tử hydro của một monosaccharide và một nhóm hydroxyl của monosaccharide còn lại. Mặc dù có nhiều disaccharide, chỉ một số ít disaccharide là được chú ý.
DẠYKÈMQUYNHƠN
12
* Maltose:
- Cấu trúc từ một phân tử anpha-glucose (1->4) glucose
- Có tính khử nhưng yếu hơn so với glucose
- Đường chủ yếu là mạch nha, có ít ở thực vật bậc cao
- Bị thuỷ phân bởi maltase ở hoặc acid loãng nhiệt độ cao
* Lactose
- Cấu tạo từ beta-galactose (1-4) Beta-glucose.
- Đường chủ yếu của sữa, có một ít trong hoa
- Có tính khử
- Bị thuỷ phân bởi beta-galactoside
* Sucarose
OFFICIAL
- Cấu tạo từ anpha glucose (1->2) beta-fructose.
- Không có tính khử
- Có nhiều trong mía, củ cải đường
- Bị thuỷ phân bởi saccaraza, axit loãng c. Đường đa (Polysaccharide)
Polysaccharide là phân tử carbohydrate cao phân tử gồm chuỗi dài của đơn vị monosaccharide liên kết với nhau bằng liên kết glycosidic và thủy phân cung cấp cho các thành phần hoặc monosaccharide, oligosaccharide. Ví dụ polysaccharide lưu trữ như tinh bột và glycogen, và polysaccharide cấu trúc như cellulose và chitin.
Tinh bột
Glicogen Xenlulozo Amilozo Amilopectin Kích thước 50-500 Có thể lên đến 1 triệu 50000 15000
Liên kết Anpha (14) glicozit Anpha (1>4) glicozit
Anpha (1>6) glicozit
Anpha (1->4) glicozit Anpha (1->6) glicozit
Beta(1>4) glicozit Cấu trúc Không phân nhánh, xoắn kiểu lò xo, nhờ liên kết
Phân nhánh ở khoảng 20-30 gốc
Phân nhánh nhiều hơn Không phân nhánh, xếp thành bó sợi, có
DẠYKÈMQUYNHƠN
13
và
ức
2.2. Lipid Lipid là hợp chất sinh học bao gồm các acid béo và các dẫn xuất của chúng có trong tự nhiên.
a. Phân loại dựa theo thành phần cấu tạo
- Lipid đơn giản: là ester của alcohol và acid béo – triacylglycerol, sáp, steride
- Lipid phức tạp: ngoài các thành phần của lipid đơn giản còn chứa các gốc phosphoric, choline, saccharide.
Ví dụ glycolipid, glycerolglycolipid....
b. Tính chất vật lí – hóa học
- Không tan trong nước nhưng tan trong dung môi hữu cơ như benzen, acetone, …
- Mạch hydrocacbon càng dài, ít nối đôi, độ hòa tan trong nước càng kém, nhiệt độ nóng chảy càng cao do giữa chúng hình thành các tương tác Van der Waals làm bến cấu trúc ở mạch dài.
- Acid béo không no dạng cis thường bị uốn cong nên kém bền hơn so với dạng trans. Vì vậy khi dầu đã rán nhiều lần, lượng acid béo trans tăng cao làm cho lượng cholesterol tỉ trọng thấp (LDL) nhiều gây tăng nguy cơ tim mạch, làm yếu cấu trúc màng, dễ bị nhiễm khuẩn và Cis Trans hóa chất độc.
DẠYKÈMQUYNHƠN OFFICIAL 14
Enzyme
ỷ
Amilaza Amilaza Xenlulaza Chức năng Dự trữ năng lượng Dự trữ năng lượng Cấu trúc Bảng
ấu trúc
hidro giữa các nhóm OH nhiều liên kết hidro giữa các bó sợi Nơi tích luỹ chủ yếu Thực vật, mô dự trữ (hạt, củ) Tế bào gan động vật, vi khuẩn Thành tế bào thực vật bậc cao, vỏ ngoài cứng của một số động vật không xương sống
thu
phân
1: C
ch
năng polysaccharide
Hình 8: Cấu hình cis và trans của acid béo c. Chức năng
- Thành phần cơ bản của màng sinh học (phospholipid và cholesterol tham gia cấu trúc nên màng sinh học của hầu hết sinh vật trên Trái Đất).
- Là nguồn nguyên liệu dự trữ quan trọng cung cấp năng lượng cho các hoạt động sống của cơ thể (acid béo và glycerol là nguồn năng lượng cũng như chất dự trữ quan trọng cho con người và động vật).
- Là chất mang điện tử, sắc tố hấp thụ ánh sáng, thành phần cấu tạo hormone, chất truyền tin nội bào, hay bảo vệ (glycoprotein tham gia nhận biết đính trên mặt ngoài màng sinh chất; các hormone steroid vận chuyển các chất đến toàn bộ cơ thể).
2.3. Acid nucleic

2.3.1. Nucleotit - đơn phân của axit nucleic Mỗi nucleotit được cấu tạo từ 3 thành phần: một gốc base nitro gen, một gốc pentose và một gốc photphat. Nucleotit có vai trò tham gia vào cấu trúc nên các hợp chất sống hữu cơ (DNA, RNA), là thành phần cấu tạo của các coenzyme quan trọng như NAD+, cấu trúc nên phân tử ATP, ...
2.3.2. DNA Mô hình cấu trúc Theo J. Waston và F. Crick, phân tử DNA là chuỗi xoắn kép gồm hai mạch polinucleotit xoắn đều quanh một trục theo chiều từ trái sang phải như một thang dây xoắn, mà hai tay thang là các phân tử đường (C5H10O4) và axit photphoric sắp xếp xen kẽ nhau, còn mỗi bậc thang là một cặp bazo đối diện và liên kết với nhau bằng các liên kết hidro theo nguyên tắc bổ sung, nghĩa là một bazo lớn (A hoặc G) được bù bằng một base nhỏ (T hoặc X) hay ngược lại. Do đặc điểm cấu trúc, A liên kết với T bằng 2 liên kết hidro, G liên kết với X bằng 3 liên kết hidro. Do các cặp nucleotit liên kết với nhau theo nguyên tắc bổ sung đã đảm bảo cho chiều rộng của chuỗi xoắn kép bằng 20Ao, khoảng cách giữa các bậc thang trên chuối là 3,4Ao, phân tử DNA xoắn theo chu kì xoắn, mỗi chu kì xoắn có 10 cặp nucleotit có chiều cao 34Ao . Ở một số loài virus và
DẠYKÈMQUYNHƠN
15
OFFICIAL
thực khuẩn thể, DNA của lạp thể, ty thể lại có dạng vòng khép kín. Ngoài mô hình của Waston Crick cho đến nay người ta còn phát hiện ra 4 dạng khác nhau là A, C, D, Z. Các mô hình này khác với dạng B ở một vài chỉ số: số cặp nucleotit trong một chu kì xoắn, đường kính, chiều xoắn.
Thông tin trong axit nucleic được mã hóa bởi trình tự sắp xếp của các nucleotide dọc theo chuỗi polynucleotide, và trong DNA sợi đôi, trình tự của mỗi sợi xác định trình tự của chuỗi bổ sung phải như thế nào. Mức độ tương đồng về trình tự giữa các DNA từ các vi sinh vật khác nhau là tiêu chí nghiêm ngặt nhất để xác định mức độ liên quan chặt chẽ của chúng.
* Chức năng của DNA:
- Tự nhân đôi trong qúa trình phân chia tế bào, tạo thành 2 bản sao từ một phân tử DNA ban đầu
- Là khuôn để tạo thành các bản phiên mã khác nhau, các RNA, protein.
OFFICIAL
-> DNA là vật chất di truyền có chức năng lưu giữ, bảo quản và truyền đạt thông tin di truyền qua các thế hệ, đảm bảo cho sự di truyền giữa các thế hệ đời sau.
2.3.3. RNA
Những nghiên cứu cho thấy, các phân tử RNA xuất hiện sớm hơn DNA và protein trong lịch sử tiến hoá. Các phân tử RNA có nhiều điểm cấu trúc giống với DNA nhưng làm chức năng trung gian trong qúa trình sinh tổng hợp protein với ba dạng khác nhau (rRNA, tRNA, mRNA). Tuy nhiên, trong hai thập niên gần đây, nhiều loại RNA mới được phát hiện cho thấy vai trò đa dạng và quan trọng của chúng trong tế bào. Đáng chú ý có gRNA với vai trò dẫn đường được ứng dụng trong cơ chế chỉnh sửa hệ gen CRISPR/Cas 9 - một bước đột phá của kĩ thuật thao tác DNA bộ gen.
a. Thành phần hoá học và cấu trúc
Các RNA giống với DNA là cấu tạo theo nguyên tắc đa phân, đơn phân là các nucleotit khác nhau ở thành phần đường 5 (pentozo) là ribozo, 4 loại bazo nito là A, U, G, X. Tuy nhiên RNA có cấu trúc 1 mạch đơn thẳng, chiều dài ngắn hơn so với DNA RNA có thể hình thành các cấu trúc không gian như kẹp tóc, thuỳ tròn, ...đây là những cấu hình mạch kép do những đoạn nucleotit có trình tự bắt cặp bổ sung theo nguyên tắc G với X và A với U. b. Cấu trúc và chức năng của các loại RNA
Loại RNA Chức năng
mRN A RNA thông tin, mã hoá cho protein
rRNA RNA ribosome, tạo cấu trúc căn bản của ribosome và xúc tác
DẠYKÈMQUYNHƠN
16
tổng hợp protein tRNA RNA vận chuyển, làm cầu nối giữa mRNA và axit amin
snRN A(RNA bé của nhân)
Small nulear RNA có chức năng trong các quá trình ở nhân tế bào, gồm splicing (cắt nối) các tiền mRNA (pre-mRNA)
snoR NA RNA nhỏ hạch nhân (sno RNA - small nucleolar RNA) chế biến và biến đổi hoá học các rRNA miRN A Điều hoà biểu hiện gen, điển hình là ngăn dịch mã mRNA theo lựa chọn siRN A RNA nhỏ can thiệp (small interfering siRNA), đóng (dừng) sự biểu hiện gen bằng phân huỷ định hướng các mRNA theo chọn lọc và tạo cấu trúc chất nhiễm sắc cuộn chặt
RNA không mã hoá khác
OFFICIAL
Có nhiều chức năng trong tế bào như tạo đầu mút NST (telomerase), bất hoạt NST X, vận chuyển các protein vào lưới nội chất
Bảng 2: Cấu trúc và chức năng của các loại RNA
RNA ribosome (rRNA)
rRNA là thành phần cấu tạo, chiếm phân nửa khối lượng riboxom. Tế bào có số lượng lớn ribosome, nên rRNA chiếm tỉ lệ cao, có thể lên tới 75% của tổng số RNA tế bào. Đối với tế bào vi khuẩn, rRNA được tổng hợp ở tế bào chất, ở đây, nó kết hợp với protein thành các tiểu phần của riboxom. Các tiểu phần (rRNA) khác nhau được đánh giá và đặt tên theo hệ số lắng khi siêu li tâm là S (Svedberg - đơn vị đánh giá tốc độ lắng xuống đáy Sedimentation của ống li tâm, S = 1cm3 x 10-13) S càng lớn thì phân tử RNA càng dài. Các riboxom của lục lạp, ti thể và vi khuẩn đều là các riboxom có hệ số lắng li tâm là 70S, gồm hai tiểu đơn vị: Tiểu đơn vị lớn 50S có 1 rRNA 23S và 1 rRNA 5S; tiểu đơn vị nhỏ 30S chỉ có 1 rRNA 16S.
Các ribosome của sinh vật nhân chuẩn thuộc loại 80S, gồm 2 tiểu đơn vị: Tiểu đơn vị lớn 60S có 1 rRNA 28S, 1 rRNA 5,8S và 1rRNA 5S, tiểu đơn vị nhỏ 40S chỉ có 1 rRNA 18S
RNA vận chuyển (transfer RNA)
Trong tế bào có đến hơn 50 loại tRNA khác nhau và ít nhất mỗi loại RNA đặc hiệu cho mỗi loại axit amin. Các tRNA có cấu trúc chung: chiều dài khoảng 70-90 nucleotit, gồm một mạch cuộn lại nhu hình lá chẻ ba nhờ các bắt cặp bổ sung bên trong phân tử, đầu mút 3’ có trình tự kết thúc. Đầu 3’ là nơi gắn vào của axit amin, một thuỳ sẽ mang bộ ba đối mã (anti codon) khớp bổ sung với bộ ba mã hoá trên
DẠYKÈMQUYNHƠN
17
mRNA là. Bằng cách đó tRNA dịch ngôn ngữ (các codon) trên mRNA thành chuỗi axit amin của mạch polipeptit.
RNA thông tin (mRNA)
mRNA có kích thước rất khác nhau, thời gian sống ngắn, bị phân giải nhanh sau khi dịch mã. Chiều dài trung bình của phân tử mRNA vào khoảng 1,2kilobase. mRNA là một giai đoạn trung gian trong quá trình biểu hiện gen. Các trình tự trên DNA mã hoá cho protein được phiên mã quá tổng hợp phân tử mRNA. Enzyme RNApolymerase dựa vào mạch khuôn mã của DNA mã hoá tạo phân tử mRNA. Bản phiên mã sơ cấp của mRNA tế bào vi khuẩn và cả sinh vật nhân chuẩn chứa trình tự nucleotide nhiều hơn số bộ ba dùng mã hoá protein.
- mRNA vi khuẩn (nhân sơ) mang trình tự mã hoá nhiều gen, mà đầu mỗi đoạn gen có trình tự điển gắn với ribosome, còn gọi là shine-dalgRNAo, để bắt cặp với trình tự bổ sung trên RNA 16S và ở cuối sau dấu dừng có trình tự không mã hoá.
OFFICIAL
- mRNA trưởng thành của sinh vật nhân chuẩn có cấu trúc phức tạp hơn: đầu 5’ có mũ cap (methyl guanine triphosphate, tiếp theo là các đoạn mã hoá, sau tín hiệu kết thúc là đoạn 3’ không mã hoá, và cuối cùng là đuôi poly-A (150-200 đơn phân adenine). Cấu trúc phức tạp hơn của mRNA nhân chuẩn có lẽ liên quan đến thời gian tồn tại ngắn hay dài để biểu hiện gen Chức năng: Làm trung gian truyền đạt thông tin di truyền từ DNA đến protein. Xúc tác cho việc cắt đứt các liên kết phosphodieste của các axit nucleic (ribozim). Ngoài ra, ở virus, RNA còn là các vật chất di truyền.
2.4. Protein
- Thành phần hoá học: bao gồm các nguyên tố C, H, O, N và một số protein ó lượng nhỏ S. Ngoài các nguyên tố trên còn có một lượng rất ít các nguyên tố khác như Fe, Cu, Mn, Ca, …
- Cấu trúc đơn phân: Mỗi acid amin được cấu tạo từ 3 thành phần: Nhóm amino (-NH2), nhóm Carboxyl (-COOH), gốc hữu cơ (R-CH)
Cấu trúc không gian: Protein gồm 4 bậc cấu trúc, trong đó cấu trúc bậc III, bậc IV là các cấu trúc không gian
DẠYKÈMQUYNHƠN
18
*
Chính vì vậy, protein
rấ
ề
- Xúc
- Vận
thể - Vận
-
Chức năng Protein là cấu trúc sinh học rất đa dạng và linh hoạt nhất trong hệ thống sống.
có
t nhi
u chức năng quan trọng như sau:
tác: enzyme tham gia nhiều phản ứng xúc tác trong cơ thể
tải: hệ thống hemoglobin tham gia vận chuyển oxi, cung cấp cho toàn bộ cơ
động: actin và myosin đảm nhận vai trò vận động.
- Bảo vệ: interferon là một cấu trúc tuyệt vời trong việc nhận biết các tế bào ung thư.
- Dự trữ: casein trong sữa mẹ là nguồn cung cấp dinh dưỡng thiết yếu cho trẻ em.
- Điều hòa: hệ thống promoter giúp điều khiển quá trình tổng hợp protein.
* Các liên kết trong từng bậc
- Cấu trúc bậc 1 được tạo ra bởi liên kết peptide là liên kết cộng hóa trị
- Cấu trúc bậc 2 được hình thành chủ yếu nhờ liên kết hydro giữa các nguyên tử H với N hoặc O là thành phần của các liên kết peptide (khung polipeptide).
- Cấu trúc bậc 3 được hình thành chủ yếu nhờ tương tác kỵ nước giữa các nhóm R không phân cực và nhờ liên kết hydro giữa các nhóm R phân cực hoặc tích điện (các acid amin có tính kiềm và acid) của các acid amin.
OFFICIAL
- Cấu trúc bậc 4 phổ biến được hình thành chủ yếu do các tương tác Van der Waals giữa các tiểu phần (chuỗi polipeptide với nhau. Cầu disulfide (-S - S-) được hình thành giữa các acid amin cystein là thành phần của các protein có vai trò hình thành ổn định ở các cấu trúc bậc 3 hoặc 4 của các protein nhất định.
3. Các quá trình trao đổi chất
3.1. Trao đổi saccharide
Phân giải Saccharide
Có hai cách phân giải polysaccharide và disaccharide tạo thành monosaccharide; thủy phân và phosphoryl phân.
- Thủy phân là quá trình phân giải các chất nhờ sự có mặt của enzyme và có sự tham gia của nước tạo thành các phân tử nhỏ.
Amylase
Tinh bột + H2O glucose + dextrin
- Phosphoryl phân: acid phosphoric thay thế vai trò của nước trong quá trình thủy phân. Vai trò của phosphorylase là cắt liến kết glycoside của tinh bột hoặc glycogen.
a) Phân giải monosaccaride
Quá trình đường phân
Đường phân hay còn gọi là con đường Embden-Meyerhof xảy ra ở tất cả các sinh vật. Quá trình đường phân xảy ra trong bào tương, sử dụng nguồn nguyên liệu glucose tạo thành 2 phân tử acid pyruvic, tích lũy 2 NADH và kèm theo 2 ATP được giải phóng bằng cách oxy hóa phosphoryl hóa ở mức cơ chất.
Phương trình tổng quát: C6H12O6 + 2ADP + 2NAD+ + 2P -> 2C3H4O3 + 2ATP + 2H+ + 2H2O
DẠYKÈMQUYNHƠN
19
- Giai đoạn tiêu tốn năng lượng gồm 5 phản ứng:
+ Bước 1: là sự phosphoryl hóa glucose, tạo glucose-6-phosphate. Phản ứng cần ATP và Mg2+ tham gia.
+ Bước 2: là sự đổng phân hóa glucose-6-phosphate chuyển thành fructose-6phosphate.
+ Bước 3: là sự phosphoryl hóa lần thứ 2 giữa 2 dạng đường aldose và ketose

+ Bước 4: là phản ứng cắt mạch carbon, biến fructose 1,6-bisphosphate thành dihydroxyacetone phosphate và glyceraldehyde-3-phosphate
+ Bước 5: là phản ứng chuyển hóa nội phân tử giữa dihydroxyacetone phosphate và glyceraldehyde-3-phosphate. Kết quả tạo 2 phân tử glyceraldehyde-3phosphate
- Giai đoạn tái tạo năng lượng
OFFICIAL
+ Bưóc 6: phản ứng oxy hóa kèm theo sự phosphoryl hóa ở cơ chất biến glyceraldehyde-3- phosphate thành 1,3-bisphosphate.
+ Bước 7: là chuyển gốc phosphate cao năng cho ADP tạo thành 2ATP và 3phosphoglycerate
+ Bước 8: cũng là phản ứng đồng phân hóa, biến đổi 3-phosphoglycerate thành 2-phosphoglycerate
+ Bước 9 là phản ứng loại nước của 2-phosphoglycerate tạo thành phosphoenolpyruvate
+ Bước 10: là phản ứng tạo pyruvate từ phosphoenolpyruvate và 2 phân tử ATP
DẠYKÈMQUYNHƠN
20
Hình 9: Sơ đồ quá trình đường phân Điều hòa đường phân Quá trình đường phân gồm 10 phản ứng với ba phản ứng không thuận nghịch được xúc tác bởi hexokinase, phosphofructokinase-1, pyruvate kinase. Đây là các enzyme dị lập thể, chúng được tăng cường khi nồng độ ADP, AMP cao và bị ức chế khi nồng độ ATP và citrate cao. Chính vì vậy, khi năng lượng tế bào ở mức thấp, hoạt độ của các enzyme này tăng cao. Hoặc, với nồng độ citrate cao, phosphofructo kinase bị ức chế vì vậy quá trình đường phân sẽ bị ức chế. Quá trình đường phân bị ức chế glucose sẽ được vận chuyển nhò các đơn chuyển glucose vào các tế bào gan và dự trữ dưới dạng glycogen. Ngoài ra, glucose-6-phosphatase là enzyme xúc tác phản ứng tách glucose khỏi glucose 6-phosphate từ gan vào vòng tuần hoàn. Khi nồng độ glucose 6phosphate tăng, glycogen phosphorylase bị ức chế và glycogen synthase được hoạt hóa, hậu quả là nồng độ glucose trong máu không tăng khi đáp ứng glucagon và epinephrine (Thiếu hụt glucose-6-phosphatase (bệnh Von Gierke)).
OFFICIAL
Fructose 2,6-bisphosphate là một chất hóa học có khả năng hoạt hóa enzyme phosphofructo kinase-1 bằng cách tăng ái lực giữa enzyme này với fructose 6phosphate. Chẳng hạn, khi nồng độ insulin tăng cao, dưới sự xúc tác của enzyme phosphofructo kinase-2, sản phẩm từ fructose 6-phosphate là fructose 2,6bisphosphate. Quá trình này sử dụng năng lượng ATP, có thể thấy fructose 2,6bisphosphate còn có khả năng giảm hiệu ứng ức chế khi nồng độ ATP cao và thúc đẩy quá trình đường phân diễn ra nhanh chóng một cách gián tiếp. Ngược lại, khi glucagon được giải phóng từ lá lách, chúng sẽ thúc đẩy hoạt tính phosphatase của phosphofructo kinase-2 làm chậm quá trình đường phân. Biến đổi pyruvate thành các sản phẩm trong điêu kiện thiếu oxy - Sự tạo thành lactate do xúc tác của lactate dehydrogenase.
Trong mô động vật, lactate được tạo ra trong điều kiện oxy cung cap không đủ. Để duy trì hoạt động sống, lactate được tạo ra nhằm cung cấp một nguồn năng lượng tạm thời cho cơ thể. Ngoài ra, một số vi sinh vật có khả năng tạo lactate như lên men sữa chua, muối dưa, cà, ... C6H12O6 + 2ADP + 2NAD+ + 2P -> 2 lactate + 2ATP + 2H2O - Quá trình lên men rượu do một số vi sinh vật khác, chẳng hạn nấm men có khả năng khử nhóm carboxyl thành acetaldehyde và CO2 nhờ xúc tác của pyruvate decarboxylase. Trong bước thứ hai, acetaldehyde bị khử thành ethanol do xúc tác của alcohol dehydrogenase (ADH).

DẠYKÈMQUYNHƠN
Hình 10: Quá trình khử acetaldehyde thành ethanol


Chu trình CORI
Khi lượng oxy cung cấp cho cơ thể bị hạn chế do hoạt động căng thẳng, mệt mỏi (chạy nhảy, bơi lội, …) thì hệ cơ hầu hết hoạt động trong điều kiện yếm khí, nguồn ATP được cung cấp chủ yếu từ đường phân. Vì vậy, khi mô cơ hoạt động, lượng lactate được tạo ra nhiều sẽ gây độc cho cơ thể (nhiễm toan). Tuy nhiên, một con đường nhằm điều chỉnh nồng độ lactate trong cơ được thực hiện khi lượng lactate cao sẽ vận chuyển đến gan. Tại gan, lactate sẽ được biến đổi thành pyruvate và thực hiện con đường tái tạo glucose (gluconeogenesis). Sau đó glucose lại được đưa đến hệ cơ cung cấp trở lại ATP cho hoạt động. Chu trình này đã giải thích vì sao lượng lactate trong cơ bắp của vận động viên khi tập luyện căng thẳng hay khi thi đầu không ở mức quá cao. Hình 11: Chu trình Cori T
OFFICIAL
DẠYKÈMQUYNHƠN
Oxy
Oxy
cơ
ừ pyruvate đến acetyl CoA.
hóa acetyl CoA trong chu trình acid citric.
hóa các coenzyme khử qua chuỗi hô hấp Hệ
Gan
Hình 12: Sự khử caroboxyl hóa pyruvate tạo thành acetyl CoA
Kết quả của phản ứng: từ pyruvate chứa 3 carbon và kém hoạt động đã biến thành hợp chất 2 carbon ở dạng hoạt hóa là acetyl coenzyme A có chứa liên kết cao năng trong phân tử. Đồng thời, do quá trình oxy hóa nguyên tử hydro của cơ chất được chuyển đến coenzyme NAD+ tạo thành coenzyme dạng khử NADH.
Chu trình acid citric (Chu trình Krebs)
Chu trình acid citric xảy ra ở ty thể thông qua 8 phản ứng đã tạo ra nhiều sản phẩm trung gian là các chất hữu cơ như acid fumarate, acid succinate, acid aketoglutarate, … Các sản phẩm trung gian này sẽ được chuyển hóa thành sản phẩm cuối cùng là CO2, hoặc được vận chuyển ra khỏi ty thể cung cấp cho việc tổng hợp các hợp chất hữu cơ trong tế bào.
OFFICIAL
Phương trình tổng quát: Acetyl-CoA + 3NAD+ + FAD+ + GDP + P + 2H2O -> 2CO2 + 3NADH + FADH2 + GTP + 2H+ + CoA Như vậy, từ 2 phân tử acid pyruvic trải qua quá trình phân giải đến sản phẩm cuối cùng là CO2 thì đã tạo được 8NADH, 2FADH2 và 2ATP.
Tính đến đây, 1 phân tử glucose trải qua 2 giai đoạn đường phân và chu trình Krebs, đã tạo ra được 10NADH, 2FADH2 và 4ATP. Chu trình axit citric có ý nghĩa quan trọng:

- Phân tử glucose bị oxy hóa hoàn toàn đến CO2 và H2O và giải phóng toàn bộ năng lượng.
- Tạo ra nhiều coenzyme khử.
- Nguồn carbon cho các quá trình sinh tổng hợp khác nhau
- Là mắt xích liên hợp, là điểm giao lưu của nhiều đường hướng phân giải và tổng hợp các chất khác nhau trong tế bào, đồng thời cũng là đường hướng chính để phân giải các hợp chất hữu cơ.
DẠYKÈMQUYNHƠN
Hình 13: Chu trình axit citric
Chuỗi vận chuyên điện tử - sự phosphoryl hóa NADH và FADH2 được sinh ra từ giai đoạn đường phần, chu trình Krebs sẽ được đưa đến màng trong ty thể để thực hiện việc vận chuyển điện tử cho các chất nhận điện tử trên màng ty thể.
Khi một cơ chất bị oxy hóa trong chất nền ty thể, dòng electron sẽ được vận chuyển trong chuỗi hô hấp, tạo sự chênh lệch proton giữa hai bên màng trong ty thể. Đó là động lực để tổng hợp ATP từ ADP và P thông qua kênh ATP synthase. Khi H+ được vận chuyển từ xoang ty thế vào chất nền (ngược trở lại) theo tỷ lệ: cứ 4H+ sẽ tổng hợp 1 ATP. Vì vậy NADH cho 10H+ và FADH2 cho 6H+ (do FADH2 đi vào phức hệ II nên bỏ qua phức hệ I dẫn đến lượng proton H+ tạo ra ít hơn). Hình 14: Chuỗi vận chuyển điện tử trên màng trong ty thể 3.2. Trao đổi lipid Tế bào có thể phân

DẠYKÈMQUYNHƠN
24
OFFICIAL
ra ở
Sự
giải từ 3 nguồn: lipid thức ăn, lipid dự trữ và lipid tổng hợp diễn
các cơ quan trong cơ thể
phân giải lipid bắt đầu là sự thủy phân các liên kết ester, giải phóng các hợp phần cấu tạo như acid béo, glycerol. Sau đó, acid béo và glycerol bị phân giải theo các con đường khác nhau, tạo ra năng lượng hoặc tham gia vào quá trình tổng hợp các chất trung gian trong cơ thể.
3.2.1. Thuỷ phân các liên kết ester trong lipid Ở động vật có xương sống, triacylglycerol từ thức ăn được nhũ tương hóa nhờ muối mật thành các hạt micelle nhỏ dễ khuếch tán và bị thủy phân dưới tác dụng của lipase tuyến tụy cắt liên kết ester, tạo thành 2- monoacylglycerol và hai gốc acid béo. Các acid béo tự do và monoacylglyecrol được chuyển đến các tế bào niêm mạc ruột để tái tạo triacylglycerol rồi được chuyển đến các mô và bị phân giải tại đó. Các acid béo được biến đổi thành acetyl - CoA. Ba phân tử acetyl - CoA có thể kết hợp với glycerol, hoặc hai phân tử có thể kết hợp với một monoacylglyecrol để tạo thành triacylglycerol. Triacylglycerol kết hợp với cholesterol và các apoprotein tạo thành chylomicron và được chuyển từ ruột non qua hệ bạch huyết và máu đến mô cơ và mô mỡ. Tại mao mạch của các mô này, enzyme ngoại bào lipoprotein lipase sẽ phân giải triacylglycerol thành acid béo và glycerol đi vào trong tế bào để oxy hóa tạo năng lượng (mô cơ), hoặc để tổng hợp triacylglycerol dự trữ (mô mỡ).
OFFICIAL
Chylomicron vận chuyển triacylglycerol đến các mô ngoại biên như mô mỡ và mô cơ. Phần còn lại của nó sẽ đến gan, VLDL được hình thành tại gan và vận chuyển lipid nội sinh đến các mô ngoại biên. VLDL bị phân giải thành IDL, kết hợp với cholesterol và cholesteryl ester từ HDL tạo nên LDL, mang cholesterol đến các mô khác. HDL vận chuyển cholesterol từ huyết thanh và các mô ngoại biên đến gan. Tại gan, cholesterol có thê biến đổi thành muối mật và đi vào túi mật.
3.2.2. Chuyển hoá glyxerol
Quá trình phân giải triacylglycerol nhờ hệ thống enzyme thủy phân liên kết ester tạo thành glycerol và acid béo. Glycerol được phosphoryl hóa thành L-glycerol3-phosphate (glycerol-3- phosphate ở quá trình đường phân dạng D), rồi oxy hóa thành dihydroxyacetone phosphate và sau đó chuyên thành D-glycerol-3-phosphate. Dglycerol-3-phosphate có thể tiếp tục oxy hóa theo con đường đường phân và chu trình acid citric để tạo thành CO2, H2O và năng lượng, hoặc tham gia tổng hợp glucose.
3.2.3. Oxi hoá axit béo
a. Acid béo được hoạt hoá thành acetyl - CoA ở bào tương Acid béo được hoạt hóa thành acetyl - CoA với sự xúc tác của acetyl - CoA synthetase và sự tham gia của ATP. Pyrophosphate được hình thành sẽ bị thủy phân bởi pyrophosphate từ hai phân tử phosphate.

DẠYKÈMQUYNHƠN
Hình 15: Hoạt hoá axit béo
b. Acetyl-CoA được vận chuyển vào ty thể Ở tế bào sinh vật nhân thực, acid béo thường được hoạt hóa ở bào tương gần màng ngoài ty thể và được vận chuyển vào ty thể. Các acetyl có từ 12 carbon trở xuống sẽ trực tiếp đi qua màng ty thể. Acetyl-CoA được ester hóa với cRNAitine thành acetyl-cRNAitine giải phóng HS-CoA dưới sự xúc tác của cRNAitine acyltransferase I và đi qua các lỗ lớn ở màng ngoài ty thể. Acetyl-cRNAitine có thể được hình thành ngay ở khoang gian màng. Sau đó acyl-cRNAitine được chuyển vào bên trong ty thê nhờ chầ't vận chuyển acetyl-cRNAitine. Gốc acetyl - CoA được tái tạo nhờ cRNAitine acetyltransferase II và cRNAitine và được giải phóng, quay trở lại khoang gian màng đê tham gia vận chuyển tiếp các gốc acid béo khác.


OFFICIAL
Hình 16: Sự vận chuyển Acetyl-CoA vào hệ thống
Quá trình oxy hoá acetyl - CoA Acid béo (ROOH) được oxy hóa qua một chuỗi 4 phản ứng tạo sản phẩm Acetyl-CoA và Acetyl-CoA ngắn hơn 2 carbon. Acetyl-CoA di chuyển vào ty thể tham gia vào chu trình citric tiếp tục oxy hóa cung cấp năng lượng cho cơ thể. Trong khi đó, Acetyl-CoA tiếp tục phân cắt theo con đường 3-oxy hóa tạo Acetyl-CoA.
DẠYKÈMQUYNHƠN
Hình 17: Quá trình oxi hoá của Palmitoy-CoA
Phương trình tổng quát:
Cn-acetyl CoA + CoA + FAD+ + NAD+ + H2O-> Cn2-acetyl CoA + acetyl - CoA + FADH+ + NADH + + H+
II. ƯU THẾ CỦA CÁC ĐỐI TƯỢNG VI SINH VẬT TRONG NGHIÊN CỨU HOÁ SINH VÀ DI TRUYỀN HỌC
Trong nghiên cứu di truyền học, các đối tượng vi sinh vật có nhiều ưu thế hơn hẳn các động vật thực vật bậc cao.
1. Thời gian thế hệ ngắn, tốc độ sinh sản nhanh
Trong điều kiện thuận lợi, tế bào E. coli có thể phân chia một lần trong 20 phút, còn bacteriophage có thể trong 30 - 40 phút tạo ra hàng trăm cá thể, nấm men có thể phân chia tế bào trong 2 giờ. Đặc điểm của nghiên cứu di truyền học là theo dõi qua nhiều thế hệ nên các đối tượng vi sinh vật giúp rút ngắn đáng kể thời gian thí nghiệm. Ví dụ, với E. coli, thí nghiệm hôm trước, qua ngày sau đã có thể đánh giá kết quả
2. Số lượng cá thể tăng nhanh
Các vi sinh vật đơn bào, mỗi tế bào là một cá thể. Nếu đủ dinh dưỡng các vi sinh vật sinh sản nhanh tạo quần thể có số lượng cá thể lớn có thể khoảng 1010 - 1012 tế bào/ml. Tế bào E. coli có đường kính 1 µm (micromet) nếu đủ dinh dưỡng và mọi điều kiện thuận lợi khác thì sau 44 giờ có thể tạo ra một lượng sinh khối nặng bằng Trái Đất. Như vậy, số lượng cá thể lớn giúp nâng cao năng suất phân giải di truyền, tức khả năng phát hiện các đột biến và tái tổ hợp có tần số xuất hiện rất nhỏ
Ưu thế này lại được tăng thêm nhờ môi trường nuôi đơn giản, dễ nuôi cấy, dễ nhân giống, mà điều kiện nuôi cấy không cồng kềnh, ít tốn diện tích, dễ kiểm soát theo công thức chặt chẽ như khi làm thí nghiệm hóa học. 3. Cấu tạo bộ gen đơn giản Vi khuẩn và virut có bộ gen là DNA trần dễ tiến hành thí nghiệm trực tiếp trên DNA cũng như chiết tách tinh sạch. Số locus cũng ít hơn so với các sinh vật khác. Các
DẠYKÈMQUYNHƠN
27
OFFICIAL
vi nấm và
bi
vi tảo có thể tồn tại ở dạng đơn bội (n) với thời gian dài, nên các gen lặn có thể
ểu hiện ngay, mà không cần phải tiến hành lai phân tích hay đưa về dạng đồng hợp tử lặn. Tuy nhiên, các vi sinh vật kể trên có trạng thái lưỡng bội (2n) nên cũng dễ dàng thực hiện phân tích tái tổ hợp.
Các tính trạng ở vi sinh vật cũng đơn giản hơn, xác định di truyền các tính trạng này ít phức tạp hơn, nên dễ nghiên cứu. Đối với các tính trạng sinh hóa hay tính đề kháng thì có thể dễ dàng sử dụng môi trường chọn lọc để phát hiện.
4. Dễ phát sinh và thu nhận các đột biến
Các phân tích di truyền học phần lớn dựa vào những khác biệt của dạng bình thường so với đột biến. Tần số đột biến ở thực vật và động vật khoảng 10–5 – 10–7, khó thu nhận và cần thời gian dài khoảng vài thế hệ để khẳng định đúng là dạng đột biến. Nhiều đột biến ở động vật dễ gây chết nên số lượng đột biến thu nhận được ở động vật rất hạn chế.
- Các đột biến ở vi sinh vật có thể thu nhận dễ dàng, thậm chí có tần số xuất hiện thấp 10–10, mà việc xác nhận dạng đột biến cũng rất nhanh.
- Nhờ ưu thế này mà di truyền học vi sinh vật phát triển rất nhanh hình thành nên di truyền học phân tử và sinh học phân tử.
OFFICIAL
- Dễ nghiên cứu bằng các kỹ thuật vật lý hóa học Đa số các vi sinh vật có cấu tạo đơn bào nên quần thể của chúng có độ đồng nhất cao hơn so với các tế bào sinh vật đa bào bậc cao bắt nguồn từ nhiều loại mô khác nhau. Cấu tạo tế bào vi sinh vật đơn giản, dễ chiết tách, tinh sạch DNA. Có thể nuôi vi sinh vật đồng nhất (synchronous culture) tức là đa số các tế bào ở những giai đoạn phát triển gần giống nhau. Độ đồng nhất cao của vật liệu thí nghiệm tạo thuận lợi cho việc sử dụng các phương pháp vật lý hóa học trong nghiên cứu di truyền.
Do những ưu điểm kể trên, với việc sử dụng các đối tượng vi sinh vật, di truyền học đã bước vào giai đoạn nghiên cứu di truyền “trong ống nghiệm” (in vitro).
Mặc dù các vi sinh vật có những đặc điểm riêng nhưng chúng vẫn tuân theo các quy luật di truyền chung, các kết quả thu được có thể đối chiếu áp dụng cho các vi sinh vật bậc cao.
III. CÁC ĐẶC ĐIỂM CỦA DI TRUYỀN HỌC VI SINH VẬT
1. Thông tin di truyền trong vi sinh vật
Thông tin di truyền ở vi khuẩn và nhiều loại virus được mã hóa trong DNA, nhưng một số loại virus sử dụng RNA. Sao chép bộ gen là cần thiết để thừa kế các tính trạng do di truyền xác định. Sự biểu hiện gen thường bao gồm phiên mã DNA thành RNA thông tin và dịch mã mRNA thành protein.
2. Tổ chức bộ gen
Nhiễm sắc thể vi khuẩn là một phân tử DNA dạng tròn có chức năng như một yếu tố di truyền tự sao chép (bản sao). Các yếu tố di truyền ngoài nhiễm sắc thể như plasmid và vi khuẩn là những bản sao không cần thiết thường xác định khả năng chống lại các chất kháng khuẩn, sản xuất các yếu tố độc lực hoặc các chức năng khác. Nhiễm
DẠYKÈMQUYNHƠN
28
sắc thể sao chép bán nguyệt; mỗi sợi DNA đóng vai trò như khuôn mẫu để tổng hợp sợi bổ sung của nó. 3. Sự đột biến và chọn lọc
Tập hợp đầy đủ các yếu tố quyết định di truyền của một sinh vật cấu thành kiểu gen của nó và các đặc điểm quan sát được cấu thành kiểu hình của nó. Đột biến là những thay đổi di truyền trong kiểu gen có thể xảy ra một cách tự phát hoặc được gây ra bởi các biện pháp xử lý hóa học hoặc vật lý. Các vi sinh vật được chọn làm dòng tham chiếu được gọi là kiểu hoang dại, và thế hệ con cháu của chúng có đột biến được gọi là thể đột biến. Các phương tiện chọn lọc phân biệt giữa chủng loại hoang dại và chủng đột biến dựa trên tốc độ tăng trưởng; môi trường phân biệt giữa chúng dựa trên các đặc tính kiểu hình khác.
OFFICIAL
4. Trao đổi thông tin di truyền Trao đổi gen giữa các vi khuẩn xảy ra theo một số cơ chế. Trong quá trình biến nạp, vi khuẩn nhận lấy DNA của người cho ngoại bào. Trong quá trình tải nạp, DNA của vi khuẩn cho được đóng gói trong một thực khuẩn sẽ lây nhiễm sang vi khuẩn nhận. Trong tiếp hợp, vi khuẩn cho truyền DNA cho thể nhận bằng cách giao phối. Tái tổ hợp là sự sắp xếp lại các bộ gen của người cho và người nhận để tạo thành các bộ gen mới, lai. Transposon là các đoạn DNA di động di chuyển từ nơi này sang nơi khác trong hoặc giữa các bộ gen.
5. DNA tái tổ hợp và nhân bản gen
Nhân bản gen là sự kết hợp gen ngoại lai vào vectơ để tạo ra phân tử DNA tái tổ hợp sao chép và biểu hiện gen ngoại lai trong tế bào nhận. Các gen nhân bản được phát hiện bằng kiểu hình mà chúng xác định hoặc bằng trình tự nucleotit cụ thể mà chúng chứa. DNA tái tổ hợp và nhân bản gen là những công cụ cần thiết cho nghiên cứu vi sinh phân tử và y học. Chúng có nhiều ứng dụng y tế, bao gồm phát triển vắcxin mới, sinh học, xét nghiệm chẩn đoán và phương pháp điều trị.
6. Quy chế biểu hiện gen
Các đặc tính kiểu hình của vi khuẩn được quyết định bởi kiểu gen và điều kiện sinh trưởng của chúng. Đối với vi khuẩn trong môi trường nuôi cấy thuần khiết, những thay đổi trong điều kiện sinh trưởng thường dẫn đến sự thích nghi sinh lý có thể dự đoán được ở tất cả các thành viên của quần thể. Thông thường, các sản phẩm gen thiết yếu được tạo ra với số lượng cho phép phát triển nhanh nhất trong môi trường nhất định và các sản phẩm cần thiết trong chỉ được sản xuất khi cần thiết.
ự thích nghi sinh lý thường gắn liền với những thay đổi trong các hoạt động trao đổi chất. Dòng chảy của các chất chuyển hóa thông qua các con đường sinh hóa c
có thể được kiểm soát bằng cách điều chỉnh quá trình tổng hợp các enzym cụ thể và bằng cách thay đổi hoạt động của các enzym hiện có. Các cơ chế điều chỉnh sự
DẠYKÈMQUYNHƠN
29
S
ụ thể
biểu hiện của gen bằng cách ảnh hưởng đến tổng hợp các sản phẩm gen cụ thể được thảo luận ở đây. Quy chế biểu hiện của một gen hoặc một nhóm gen liên quan đến một quá trình trao đổi chất cụ thể. Cảm ứng và ức chế cho phép vi khuẩn điều chỉnh sản xuất các sản phẩm gen cụ thể để đáp ứng với các tín hiệu thích hợp. Nói chung, các enzyme dị hóa được tạo ra khi có mặt chất nền cho con đường trong môi trường tăng trưởng, và các enzyme sinh tổng hợp bị ức chế bởi sản phẩm của con đường này. Các enzim tham gia vào một con đường sinh hoá đơn lẻ thường chiếm các vị trí liền kề trên nhiễm sắc thể vi khuẩn và được cảm ứng hoặc phối hợp với nhau. Sự biểu hiện của gen ở vi sinh vật thường do điều kiện nội bào hoặc môi trường quy định. Quá trình điều tiết có thể ảnh hưởng đến bất kỳ bước nào trong biểu hiện gen, bao gồm bắt đầu hoặc kết thúc phiên mã, dịch mã hoặc hoạt động của các sản phẩm gen. Operon là một tập hợp các gen được phiên mã thành một đơn vị duy nhất và được biểu hiện một cách phối hợp. Cơ chế điều hòa cụ thể tạo ra hoặc kìm hãm một gen hoặc operon cụ thể. Tất cả các operon trong cơ quan điều hòa được điều khiển một cách phối hợp bởi cùng một cơ chế điều chỉnh. Sự biểu hiện của các yếu tố quyết định di truyền ở vi khuẩn liên quan đến dòng thông tin một chiều từ DNA đến RNA đến protein. Trong thực khuẩn, DNA hoặc RNA đều có thể đóng vai trò là vật chất di truyền. Trong quá trình lây nhiễm vi khuẩn bởi RNA thực khuẩn, các phân tử RNA đóng vai trò như khuôn mẫu để sao chép RNA và như mRNA. Các nghiên cứu với nhóm virus động vật retrovirus cho thấy rằng các phân tử DNA có thể được tổng hợp từ các khuôn mẫu RNA bằng các enzym được chỉ định là các polymerase DNA phụ thuộc RNA (sao chép ngược). Sự đảo ngược hướng thông thường của dòng thông tin di truyền, từ RNA sang DNA thay vì từ DNA sang RNA, là một cơ chế quan trọng để cho phép thông tin từ retrovirus được mã hóa trong DNA và được tích hợp vào bộ gen của tế bào động vật.
7. Vật chất di truyền trong vi sinh vật
Vật chất di truyền của vi khuẩn và plasmid là DNA. Vi rút vi khuẩn (thực khuẩn thể hoặc thể thực khuẩn) có DNA hoặc RNA làm vật liệu di truyền. Hai chức năng thiết yếu của vật chất di truyền là sao chép và biểu hiện. Vật chất di truyền phải sao chép chính xác để thế hệ con cháu thừa hưởng tất cả các yếu tố quyết định di truyền cụ thể (kiểu gen) của sinh vật bố mẹ. Sự biểu hiện của vật chất di truyền cụ thể trong một tập hợp các điều kiện sinh trưởng xác định các đặc điểm quan sát được (kiểu hình) của sinh vật. Vi khuẩn có ít đặc điểm cấu trúc hoặc phát triển có thể được quan sát dễ dàng, nhưng chúng có một loạt các khả năng sinh hóa và mô hình nhạy cảm với các chất kháng khuẩn hoặc thực khuẩn. Các đặc điểm sau này thường được chọn làm các đặc điểm di truyền để phân tích trong các nghiên cứu về di truyền vi khuẩn.
DẠYKÈMQUYNHƠN
OFFICIAL 30
VI SINH VẬT
Đối với các vi sinh vật, phân tích di truyền là phương pháp duy nhất để nghiên cứu các đặc tính di truyền và biến dị của chúng. Do các vi sinh vật thường có bộ gen đơn bội, đặc biệt là vi khuẩn chỉ có một nhóm liên kết gen nên sơ đồ phân tích di truyền học ở chúng là đơn giản hơn các sinh vật nhân thực bậc cao, bao gồm các giai đoạn sau:
- Xác định các gen
- Xác định trật tự của các locus trên nhiễm sắc thể
- Xác đinh cấu trúc tinh vi của gen
1. Nghiên cứu trực tiếp ở cấp độ tế bào và cấp độ phân tử
OFFICIAL
Di truyền học cổ điển sử dụng các mô hình đối tượng như đậu Hà Lan Pisum sativum, cây bắp (ngô) Zea mais, ruồi giấm Drosophila melanogaster và chuột nhắt Mus musculus, là những sinh vật đa bào mà sự biểu hiện tính trạng phải trải qua một quá trình phát triển phức tạp và kèm theo biệt hóa, việc quan sát trên các đối tượng này được thực hiện gián tiếp. Trong khi đó, nhiều đối tượng vi sinh vật như vi khuẩn Escherichia coli, nấm men Saccharomyces cerevisiae là sinh vật đơn bào nên các quan sát thực hiện trực tiếp hơn ở mức tế bào. Ví dụ, trên môi trường tối thiểu với lượng muối hữu cơ và glucoz cho trước, một tế bào E. coli có thể tổng hợp tất cả các hợp chất cần thiết cho sự tăng trưởng, sống sót và sinh sản. Nếu tế bào bị đột biến mất khả năng tổng hợp một chất nào đó như một loại axit amin thì nó không mọc được trên môi trường tối thiểu. Trên môi trường có bổ sung thuốc kháng sinh thì chỉ có các tế bào đề kháng mới mọc được.
Hơn nữa, các tế bào vi sinh vật có nhu cầu dinh dưỡng đơn giản dễ kiểm soát thành phần môi trường nuôi, dễ nuôi cấy, dễ nhân giống, dễ dàng thu nhận nhiều loại đột biến phục vụ cho nghiên cứu trực tiếp và nhanh chóng ở cấp độ tế bào, phân tử. Do vậy, chúng là những đối tượng lý tưởng cho nghiên cứu di truyền học phân tử.
Cấu trúc bộ gen
DNA hiện diện trong bộ gen (Genome) của tất cả các loại tế bào từ vi khuẩn đến người. Giữa các sinh vật nhân sơ Prokaryota và nhân chuẩn Eukaryota có sự khác nhau đáng kể v
kích thước, thành phần cấu tạo và tổ chức của DNA trong tế bào. Bộ gen của vi khuẩn E. coli và đa số các sinh vật nhân sơ là một phân tử DNA có dạng vòng tròn kín. Khái niệm nhiễm sắc thể hiện nay được dùng cho cả vi khuẩn, nên nói nhiễm sắc thể vi khuẩn ta hiểu đó là sợi DNA. Ty thể và lục lạp cũng có DNA riêng, mà cấu trúc bộ gen cũng tương tự vi khuẩn. Đa phần DNA của Eukaryota như nấm sợi, nấm men, vi tảo được tổ chức thành nhiều nhiễm sắc thể trong nhân tế bào. Mỗi nhiễm sắc thể chứa 1 phân tử DNA thẳng
DẠYKÈMQUYNHƠN
31
N HỌC
IV. PHƯƠNG PHÁP NGHIÊN CỨU ĐẶC THÙ CỦA DI TRUYỀ
ề
mạch kép kèm theo một số protein như histon. Các nhiễm sắc thể có số lượng và hình dạng đặc trưng cho tế bào của mỗi loài sinh vật nhân chuẩn.
Các virut có bộ gen rất đa dạng: DNA mạch đơn hoặc kép, RNA mạch đơn hoặc kép, nhưng chỉ một loại phân tử.
1.1. Phân tích đột biến
Phương pháp này được áp dụng để xác định các gen và được tiến hành bằng cách đo đếm các kết quả cuối cùng cuả sự biểu hiện gen thành ra sự biến đổi kiểu hình (đặc điểm hình thái, hoá sinh, kháng nguyên hoặc tính mẫn cảm đối với các tác nhân hoá học, vật lí và sinh học khác nhau của các tế bào vi khuẩn). Việc phát hiện một đột biến ngẫu nhiên hay gây tạo sẽ chỉ ra sự tồn tại của một gen cụ thể.
OFFICIAL
Sự biến đổi hình thái ở vi sinh vật bao gồm các biến đổi về kích thước, hình dạng và sự hình thành sắc tố của các khuẩn lạc do các tế bào bị đột biến tạo nên trên các môi trường dinh dưỡng đặc cũng như sự biến đổi của bản thân các phân tử của tế bào (gia tăng kích thước, thay đổi hình thái, ...). Sự biến đổi hoá sinh bao gồm các biến đổi liên quan đến việc tế bào mất khả năng tổng hợp các amino axit hoặc vitamin hoặc mất khả năng chuyển hoá các hợp chất cacbonhydrat. Các biến đổi về kháng nguyên thể hiện ở chỗ vi khuẩn bị mất đi những kháng nguyên nhất định. Các biến đổi trong tính bền vững của vi khuẩn đối với các tác nhân khác nhau liên quan đến sự xuất hiện của chúng trong các khả năng đề kháng đối với sự chiếu xạ, với các hoá chất khác nhau (kể cả các loại thuốc kháng sinh) hoặc với phage.
Do tần số đột biến ở vi khuẩn là rất thấp nên việc phân lập các tế bào bị đột biến chỉ có thể thực hiện được trong các thí nghiệm với các quần thể tế bào. Như vậy, về nguyên tắc, trong trường hợp này có thể sử dụng bất kỳ phương pháp nào cho phép tách được các thể đột biến từ các quần thể. Việc xác định số lượng các đột biến dựa trên các phương pháp xác định tần số đột biến. Thông thường, để phân tích di truyền cần có các nòi đột biến mang các đột biến vị trí cho trước, chẳng hạn, đối với B. subtilis, có thể xử lí sơ bộ DNA gây biến nạp bằng các tác nhân gây đột biến. Ở E. coli, có thể gây các đột biến có vị trí xác định bằng cách đưa vào tế bào vi khuẩn các gen đột biến nhờ các phage tải nạp. 1.2. Phân tích tái tổ hợp Đây là phương pháp đặc trưng được dùng để xác định vị trí và trật tự của các gen trên nhiễm sắc thể. Đối với vi khuẩn, việc phân tích di truyền dựa vào các quá trình trao đổi vật liệu di truyền như biến nạp, tải nạp, tiếp hợp hay còn gọi là giao nạp. Ở các vi nấm, việc phân tích di truyền được tiến hành bằng phân tích phép phân tích bộ bốn và dựa trên chu trình cận hữu tính. Nói chung, sự trao đổi di truyền ở các vi khuẩn và quá trình hữu tính ở các cơ thể bậc cao là không giống nhau. Việc truyền vật liệu di truyền từ vi khuẩn thể cho (donor) sang vi khuẩn thể nhận (recipient) có thể coi như sự kết hợp nhân của các tế bào sinh dục (ở đây là sự tạo thành các thể lưỡng bội từng phần), còn sự sát nhập của
DẠYKÈMQUYNHƠN
32
vật liệu di truyền vào bộ gen của vi khuẩn thể nhận, và sự hình thành nhiễm sắc thể tái tổ hợp sau đó, có thể so sánh với các kết quả của giảm phân. Chính các hệ thống tái tổ hợp này là cơ sở cho phương pháp phân tích tái tổ hợp và lập bản đồ di truyền ở vi khuẩn. Ví dụ, trật tự của hấu hết các gen trên nhiếm sắc thể E. coli được xác định là nhờ sử dụng tiếp hợp và tải nạp, ở B. subtilis nhờ tải nạp và biến nạp, còn ở Samonela typhimurium chủ yếu là nhờ tải nạp. Ngoài ra, phép phân tích tái tổ hợp này còn dược sử dụng để nghiên cứu cấu trúc tinh vi của gen
1.3. Phân tích sao chép
Phương pháp này cho phép xác định trật tự các gen trên nhiễm sắc thể dựa trên sự tính toán các số liệu về sự bắt đầu sao chép (tái bản) của nhiễm sắc thể từ một điểm xác định. Do thời gian sao chép của một phần nhiễm sắc thể nhất định phụ thuộc vào khoảng cách từ phần đó đến điểm khởi đầu sao chép nên thứ tự sao chép phản ánh trình tự sắp xếp của các gen. Như vậy, bản đồ NST chỉ có thể được xây dựng dựa trên các dẫn liệu về trật tự sao chép của các phần riêng biệt của nhiễm sắc thể.
OFFICIAL
1.4. Phân tích đoạn khuyết Phép phân tích đoạn khuyết được sử dụng để xác định vị trí của các gen trên nhiễm sắc thể cũng như để nghiên cứu cấu trúc tinh vi của các gen. Nó dựa trên việc tính toán các đoạn khuyết trên nhiễm sắc thể. Nhờ sự phân tích này người ta đã phát hiện được vị trí cuả hàng loạt gen ở E. coli và S. typhimurium, hiểu biết được cấu trúc tinh vi của các gen trên operon lactose ở vi khuẩn E. coli. Phương pháp này cũng được sử dụng rộng rãi để nghiên cứu cấu trúc tinh vi ở phage.
1.5. Phân tích bổ sung
Phương pháp này được sử dụng để phát hiện chức năng của các gen nhất định tham gia vào việc xác định một đặc tính nào đó của vi khuẩn, dựa trên hiện tượng bổ sung của các gen (nghĩa là sự tương tác của các sản phẩm gen).
Bằng cách lai các thể đột biến của cùng một gen có nguồn gốc độc lập nhau trong khi cho lây nhiễm các phage, đã làm xuất hiện các phage kiểu dại. Điều này chỉ có thể xảy ra bởi sự tái tổ hợp bên trong gene, nếu như các phần nhỏ riêng biệt của gen đều bị đột biến.
Đơn vị chức năng di truyền không chia nhỏ (cistron) có thể xác định được bằng sự phân tích bổ sung (complementation analysis), trong đó gen mà cụ thể là sản phẩm của nó được trắc nghiệm về khả năng bù đắp cho một đột biến tại một gen tương đồng trong cùng tế bào. Sự bổ sung liên tiếp làm phục hồi kiểu hình dại.

DẠYKÈMQUYNHƠN
33
Hình 18: Sơ đồ minh hoạ trắc nghiệm cis-trans
1.5. Năng suất phân giải Năng suất phân giải của di truyền học được xác định bởi khoảng cách giữa các cấu trúc di truyền (gene) cần phân tích trên nhiễm sắc thể. Đại lượng này phụ thuộc vào số lượng cá thể đời con nghiên cứu được từ một phép lai cụ thể, số con cháu thu được càng lớn thì khả năng phát hiện các thể tái tổ hợp hiếm càng lớn, tức năng suất phân giải của phân tích di truyền học càng cao. Theo luật số lớn này, các vi khuẩn tỏ ra rất thuận lợi trong phân tích di truyền học, vì trong một thời gian ngắn có thể thu được một số lượng cực kì lớn con cháu từ một tế bào vi khuẩn, cũng như có thể sử dụng các môi trường nuôi cấy khác nhau để chọn lọc các cá thể tái tổ hợp.
2. Dòng tế bào Đặc điểm của các tế bào vi sinh vật là rất nhỏ bé, phải nhìn dưới kính hiển vi mới thấy được. Do vậy khó có thể quan sát từng tế bào riêng lẻ, hơn nữa, bằng cách này cũng không ghi nhận được các tính trạng biến dưỡng, tính đề kháng và nhiều tính trạng khác. Do vậy, di truyền vi sinh vật không nghiên cứu từng tế bào riêng lẻ mà là dòng của tế bào, tức tập hợp của nhiều tế bào bắt nguồn từ một tế bào ban đầu nhờ sinh sản vô tính. Thông thường, tế bào vi sinh vật được cấy lên môi trường thạch đặc, rồi trải đều để các tế bào nằm rời xa ra thì mỗi tế bào mọc lên thành một cụm rời gọi là khuẩn lạc (colony). Mỗi khuẩn lạc cũng là một dòng tế bào (clone) gồm các tế bào bắt nguồn tự sự phân chia của một tế bào ban đầu.
OFFICIAL
Hình 19: Khuẩn lạc (colony) của vi sinh vật Mỗi khuẩn lạc dễ nhìn thấy bằng mắt thường, có tối thiểu 107 tế bào. Như vậy, các tính trạng ở vi sinh vật được ghi nhận qua một quần thể gồm hàng trăm triệu, hàng tỉ tế bào.
Dòng tế bào mang một đặc tính di truyền nào đó gọi là chủng (strain). Ví dụ: chủng vi khuẩn tạo nhiều vitamin B12 hay chủng vi khuẩn mất khả năng tổng hợp một axit amin nào đó.
3. Các tính trạng Các đột biến ở vi sinh vật thường được phát hiện theo sự biến đổi các tính trạng sau:

DẠYKÈMQUYNHƠN
34
Hình thái: kích thước, hình dạng tế bào hay khuẩn lạc, có màng nhân hay không, khả năng di động, ...
Sinh hóa: sự hiện diện của các sắc tố, màu sắc đặc trưng.
Nuôi cấy: như kiểu hô hấp, kiểu dinh dưỡng (khuyết dưỡng - auxotroph) hoặc nhu cầu đòi hỏi các nhân tố tăng trưởng.
Tính đề kháng: như kháng thuốc, kháng phage, chịu nhiệt, ...
Miễn dịch: như các phản ứng kháng thể, kháng nguyên, ...
Các đột biến có thể xuất hiện ngẫu nhiên hay do gây tạo ra nhờ các tác nhân gây đột biến. Mỗi gen có tần số đột biến đặc trưng.
OFFICIAL
Các tính trạng ở vi sinh vật được kí hiệu bằng 3 chữ tắt tiếng Anh hoặc đôi khi chữ hoa đầu tiên. Kèm theo kí hiệu còn thêm dấu + hoặc – hoặc chữ tắt để giải thích rõ thêm tính trạng. Ví dụ: lac– để chỉ mất khả năng tổng hợp lactoz; his+ - tổng hợp histidin; strS – nhạy cảm (Sensible) với Streptomycin, strR – đề kháng (Resistant) với Streptomycin.
Để chỉ hai giới tính khác nhau không dùng hai kí hiệu ♀ và ♂ thay vào đó là các chữ như mt (+), mt (-) (mating typ) (ở Chlamydomonas reinhardi), hoặc A, a (ở Neurospora crassa).
4. Kiểu sinh sản
Các virut chỉ sinh sản trong tế bào chủ sống với nhiều cơ chế khác nhau phụ thuộc kiểu virut
Các vi khuẩn không có các cơ chế nguyên phân và giảm phân, phân chia tế bào theo cơ chế trực phân, nhưng cũng có sinh sản vô tính và sự trao đổi thông tin di truyền tương tự sinh sản hữu tính được gọi là quá trình cận hữu tính.
Các nấm sợi, nấm men, vi tảo có các quá trình sinh sản vô tính và hữu tính về căn bản giống các sinh vật bậc cao, thực hiện qua nguyên phân và giảm phân.
V. BIẾN DỊ Ở VI SINH VẬT
Biến dị ở vi sinh vật cũng tuân theo quy luật di truyền chung.
Biến dị và đột biến có ý nghĩa quan trọng trong nghiên cứu di truyền học. Các đột biến gồm nhiều loại khác nhau và chúng được thu nhận dễ dàng từ các vi sinh vật nhờ các phương pháp phát hiện chuyên biệt. Các đột biến gen bắt nguồn từ những biến đổi phân tử trên DNA. Con người có thể sử dụng các tác nhân vật lí và hóa học gây nên các đột biến nhân tạo hay cảm ứng. Biến dị ở vi sinh vật cũng tuân theo các quy luật di truyền như ở sinh vật bậc cao. Nó có nhiều loại và số lượng rất lớn, cung cấp nguyên liệu thường xuyên cho quá trình tiến hóa và nghiên cứu di truyền học. Nhiều phương pháp phát hiện và chọn lọc các đột biến khác nhau được sử dụng để thu nhận các đột biến có tần số xuất hiện rất
DẠYKÈMQUYNHƠN
35
thấp. Chúng góp phần đáng kể cho các nghiên cứu di truyền. Các thay đổi thêm, mất hay thay thế các nucleotit trên phân tử DNA dẫn đến các biến đổi phân tử, gây ra các đột biến gen như: lệch khung, sai hay nhầm nghĩa và im lặng. Việc phát minh ra các tác nhân gây đột biến vật lí và hóa học làm tăng đáng kể nguồn đột biến phục vụ cho nghiên cứu và chọn giống. Con người có thể tăng nguồn biến dị bằng lai tạo hay sử dụng các tác nhân gây đột biến.
Vi sinh vật cũng có các loại đột biến như ở sinh vật bậc cao. Ở đây chỉ nêu các đột biến thường gặp ở vi sinh vật và có ý nghĩa quan trọng đối với di truyền phân tử
1. Quá trình đột biến tự nhiên
Đột biến gen là đột biến được hiểu theo nghĩa hẹp, là chỉ những biến đổi xảy ra bên trong cấu trúc gen. Mỗi đột biến gen dẫn đến sự thay đổi trình tự nucleotit tạo ra các alen khác nhau. Đột biến có thể xảy ra do biến đổi nhiều nucleotit, có thể do 1 nucleotit. Đột biến gen không phát hiện được khi quan sát tế bào học.
OFFICIAL
Các gen khác nhau của cùng 1 sinh vật có thể có tần số đột biến khác nhau. Nhưng tần số đột biến tự nhiên đối với mỗi gen là một số ổn định. Tần số đột biến được đánh giá theo các căn cứ khác nhau như: trên 1 lần sao chép, 1 lần phân bào hay trên 1 giao tử và trên 1 tế bào/1 thế hệ
Ví dụ: Ở E. coli đột biến từ nhạy cảm với streptomycin sang kháng tức StrSStrR với tần số 4.10-10 đột biến tính trên 1 tế bào/1 thế hệ. Để dễ hiểu ta có thể tính ngược lại tức trong 10 tỉ tế bào của một thế hệ có 4 đột biến StrR (resistance) kháng streptomycin xuất hiện ngẫu nhiên.
Tuy tần số đột biến của từng gen là rất thấp, nhưng tổng các đột biến của nhiều gen là một số đáng kể, có ý nghĩa quan trọng cho tiến hóa. Đột biến ảnh hưởng đến mọi tính trạng khác nhau của sinh vật và tác động theo mọi hướng.
2. Đột biến gen hay đột biến điểm Đột biến điểm là những biến đổi rất nhỏ trên một đoạn DNA, thường liên quan đến 1 nucleotit hay 1 cặp nucleotit.
Đột biến đồng nghĩa (Samesense) còn gọi là trung tính (neutral) hay im lặng (silent), khi codon mã hóa cho một axit amin bị biến đổi, thường ở bazơ thứ ba nên vẫn mã hóa cho axit amin đó (do tính thoái hoá của mã di truyền).
Đột biến vô nghĩa (Non-sense) khi codon mã hóa cho một axit amin biến thành một trong ba codon UAA, UAG và UGA là các codon kết thúc không mã hóa cho axit amin nào.
Đột biến sai nghĩa (Mis-sense): Khi codon của axit amin này biến thành codon mã hóa cho axit amin khác, làm thay đổi axit amin tương ứng trên phân tử protein.
DẠYKÈMQUYNHƠN
36
Đột biến lệch khung: Sự thêm 1 bazơ hay làm mất 1 bazơ dẫn đến các codon sai nghĩa hay vô nghĩa so với codon tương ứng ban đầu từ điểm biến đổi về sau, sự dịch mã bị lệch khung có tính dây chuyền từ bộ ba bị sai.
3. Đột biến nhiễm sắc thể
Các đột biến nhiễm sắc thể hay còn gọi là sai hình nhiễm sắc thể xuất hiện ở vi sinh vật nhân thực.
- Biến đổi trên 1 nhiễm sắc thể: mất đoạn, lặp đoạn, đảo đoạn.
- Biến đổi giữa các nhiễm sắc thể: chuyển đoạn.
- Đột biến bộ gen (genome mutation)
Đa bội thể (Polyploidy) hiểu theo nghĩa rộng là sự thay đổi số lượng nhiễm sắc thể gồm: Đa bội thể nguyên (Polyploidy hay Euploidy) (2n –> 3n, 4n, …), đa bội thể lai còn gọi dị bội thể (Alloploidy) (2nA + 2nB) và đa bội lệch (Aneuploidy), hay đa nhiễm: (ví dụ: 2n + 1 hoặc 2n – 1).
OFFICIAL
4. Các biến đổi vi cấu trúc
Các thay đổi thành phần nucleotit của gen.
Đột biến thay thế: Thay một nucleotit này bằng nucleotit khác.
- Đồng chuyển (Transition) khi pyrimidin được thay thế bởi pyrimidin hay purin bởi purin. Ví dụ: T thay cho C hoặc ngược lại.
- Đảo chuyển (Transversion) khi pyrimidin được thay thế bởi purin hay purin bởi pyrimidin. Ví dụ: T hay C thay cho A hoặc G và ngược lại. Mất nucleotit (Deletion): Mất một phần nucleotit của gen.
Đột biến xen nucleotit (Insertion mutant): Thêm 1 hay nhiều nucleotit vào gen.
5. Các đột biến kiểu hình
Các đột biến hình thái: Các biến đổi ảnh hưởng đến hình dạng, màu sắc và kích thước.
Đột biến sinh hóa:
- Các đột biến khuyết dưỡng (Auxotrophe mutation) làm mất khả năng tổng hợp các chất.
- Các đột biến có điều kiện: Các đột biến có thể không có biểu hiện trong những điều kiện giới hạn nhất định (restrictive condition) và có biểu hiện trong các điều kiện cho phép (permissive condition). Ví dụ, các đột biến nhạy cảm với nhiệt độ cao có biểu hiện ở nhiệt độ tương ứng.
- Đột biến đề kháng: Các biến đổi sinh hóa giúp kháng lại được các tác nhân bất lợi.
DẠYKÈMQUYNHƠN
37
6. Đột biến thuận và đột biến nghịch
Đột biến thuận hay trực tiếp (Direct mutation): Biến đổi từ kiểu hình hoang dại sang khác thường.
Hồi biến (Reversion): Đột biến từ kiểu hình đột biến quay về kiểu hình hoang dại.
Hồi biến thật hay đột biến nghịch. Đột biến trở lại y như ban đầu.
Ví dụ: adenin -> guanin -> adenin
Đột biến ức chế hay kìm hãm (Supressor): Đột biến ở một điểm khác. Cả hai cùng tạo kiểu hình gần như hoang dại.
Đột biến kìm hãm ngoài gen: Xảy ra ở gen khác với gen bị đột biến. Đột biến kìm hãm trong gen: Xảy ra ở nucleotit khác trong gen đưa gen trở về trạng thái tạo kiểu hình hoang dại.
OFFICIAL
Nói chung, các đột biến là các biến đổi rất đa dạng của vật chất di truyền và có nhiều tác động khác nhau.
6.1. Cơ chế phân tử của đột biến
6.1.1. Các biến đổi trên DNA
Tất cả các đột biến đều do những thay đổi trình tự nucleotit trên DNA. Các đột biến có thể xảy ngẫu nhiên (spontaneously) hay gây tạo (cảm ứng - induced) bởi các tác nhân gây đột biến (mutagens). Các đột biến có thể do thay đổi từng cặp bazơ hay những trình tự dài hơn.
Đột biến điểm (Point mutation) là biến đổi trình tự của một cặp bazơ. Đột biến điểm có thể do chuyển đổi hoá học bazơ này thành bazơ khác hoặc do bắt cặp sai trong sao chép. Sự biến đổi gồm nhiều kiểu:
Sự đồng chuyển: thay cặp G-C bằng A-T và ngược lại. Sự đảo chuyển: thay A-T bằng T-A và ngược lại.
– Sự bắt cặp sai (Bazơ mispairing) là sự bắt cặp không theo đúng nguyên tắc của mô hình Watson-Crick, mà là adenin với cytosin, thymine với guanin. Xen đoạn (Insertion) là sự thêm vào một đoạn cặp bazơ vào DNA. Tăng đôi đoạn (Duplication) là một dạng đặc biệt của xen đoạn. Mất đoạn (deletion) là sự mất đi một trình tự DNA, mà trình tự hai bên nối lại với nhau trừ trường hợp mất đầu mút nhiễm sắc thể.
Transposon hay phần tử di động là trình tự DNA có khả năng tự xen vào (hay bản sao chính nó) ở vị trí mới trên bộ gen (genome), mà không cần có quan hệ gì với locus mục tiêu. Xen đoạn là kiểu đột biến phổ biến nhất và do sự di chuyển của các phần tử di động.
DẠYKÈMQUYNHƠN
38
Phần lớn đột biến ngẫu nhiên do sự hiện diện của các bazơ bất thường trên DNA. Ngoài ra, một số bazơ bị biến đổi (modified) như thường gặp hơn cả là 5metylcytosin, được tạo ra do enzym metylaz thêm nhóm metyl vào một số cytosin ở những điểm đặc biệt trên DNA.
6.1.2. Các sai hỏng trong sao chép DNA
Các đột biến có thể xảy ra do sai lầm khi sao chép DNA. Mỗi bazơ tồn tại ở 2 dạng cấu trúc được gọi là tautomer. Ví dụ, adenin bình thường mang nhóm NH2 cung cấp nguyên tử hydro cho sự bắt cặp bổ sung với dạng keto (C = O - keto form) của thymine. Khi có biến đổi tautomer, adenin chuyển sang cấu trúc hiếm là dạng imino NH sẽ bắt cặp bổ sung với cytosin. Thymine có thể chuyển sang dạng enol (COH) không có trong DNA bình thường và bắt cặp với guanin.
Sự bắt cặp sai này có thể là các đột biến đồng chuyển, trong đó purin thay bằng purin khác và pyrimidin thay bằng pyrimidin khác.
OFFICIAL
Các biến đổi trên, ngoài việc thay thế các nucleotit trên mạch DNA còn có thể làm tăng thêm hay khuyết các nucleotit gây nên các kiểu đột biến ảnh hưởng đến sinh tổng hợp protein.
6.1.3. Ảnh hưởng của đột biến gen đến sinh tổng hợp protein
Đột biến lệch khung
Hai kiểu đột biến có hiệu quả nặng là thêm bazơ (addition) và mất bazơ (delection). Các biến đổi này thường làm enzym mất hoạt tính. Sự thêm 1 bazơ hay làm mất 1 bazơ dẫn đến sự dịch mã lệch khung. Từ điểm biến đổi về sau, từ bộ ba bị sai cái sai sẽ kéo dài liên tục đến cuối mạch polypeptit.
Đột biến thay thế (Bazơ substitution)
Đột biến thay thế bazơ nếu là đột biến sai nghĩa (mis-sense) sẽ có hiệu quả thay đổi từ axit amin này thành axit amin khác trong mạch polypeptit, còn nếu là đột biến vô nghĩa (non-sense) hay đột biến trung tính (hay im lặng) sẽ không ảnh hưởng đến mạch polypeptit.
6.1.4. Sai hỏng ngẫu nhiên Ngoài các sai hỏng trong sao chép, phân tử DNA còn chịu các sai hỏng ngẫu nhiên có thể dẫn đến đột biến. Hai kiểu sai hỏng ngẫu nhiên thường gặp là mất purin (depurination) và mất amin (desamination). Mất purin là kiểu sai hỏng thường hơn, xảy ra khi liên kết glycosidic giữa C1 của pentoz với bazơ bị đứt và làm mất A hoặc G. Sự mất amin của cytosin tạo ra uracil. Các gốc U không được sửa sai sẽ bắt cặp bổ sung với A trong sao chép, gây ra đồng chuyển G-C ->A-T. Trong các enzym sửa
DẠYKÈMQUYNHƠN
39
sai, uracil DNA-glycosylaz nhận biết đặc hiệu uracil trên DNA và cắt rời tạo lỗ hỏng, sau đó được tổng hợp lại đúng theo mạch bổ sung.
Trên phân tử DNA, một số cytosin được metyl hóa thành 5-metyl cytosin, chất này mất nhóm amin biến thành thymine. Sai hỏng này không bị uracil-DNA-glycolaz phát hiện nên không được sửa lại. Sự chuyển C - T do mất amin thường xảy ra ở các điểm có 5-metyl cytosin. Kiểu biến đổi này có ở cả vi khuẩn và tế bào sinh vật bậc cao.
6.1.5. Đột biến nhân tạo hay cảm ứng
Các tác nhân làm tăng tần số đột biến cao hơn mức tự nhiên được gọi là các tác nhân gây đột biến (mutagen). Các tác nhân vật lí như phóng xạ, tia X, tia tử ngoại gây đột biến. Nhiều hóa chất là tác nhân gây đột biến như các đồng đẳng của các bazơ nitric, HNO2 (nitrous axit), các chất alxyl hóa mạch...Các đột biến loại này được gọi là đột biến nhân tạo hay đột biến cảm ứng (induced mutation).
OFFICIAL
Đối với các vi sinh vật, các tác nhân gây đột biến chủ yếu là tia tử ngoại và một số hóa chất.
6.2. Hồi biến
Quá trình đột biến, nói chung, có tính thuận nghịch, nghĩa là nếu một gen A đột biến thành a (A –> a) thì, ngược lại alen a cũng có thể đột biến quay lại thành A (a –>A). Thông thường một dạng được gọi là đột biến khi nó mang kiểu hình khác với dạng hoang dại. Hồi biến là trường hợp từ trạng thái đột biến do biến dị di truyền quay trở về kiểu hình hoang dại. Hồi biến do đột biến nghịch (back mutation) hoặc do đột biến ức chế hay kìm hãm (supression).
6.2.1. Các đột biến nghịch
Đột biến nghịch có được khi gen đột biến có sự biến đổi quay trở lại có cấu trúc như gen hoang dại ban đầu. Trường hợp này khó xảy ra và khi lai trở lại với dòng hoang dại thì thế hệ con tất cả đều có kiểu hình hoang dại.
Ví dụ: Đột biến nghịch: m––> m+, khi lai với dạng hoang dại cho thế hệ con đều hoang dại Đột biến ức chế: m –su+ –> m–su –, khi lai với dạng hoang dại trong thế hệ con sẽ có m
(Suppressor mutation) là đột biến có tác động ngược lại hay kìm hãm của một đột biến khác. Các đột biến ức chế có những tính chất sau: Đột biến ức chế xảy ra ở điểm khác với đột biến bị ức chế. Khi lai thể hồi biến (revertant) với dạng hoang dại sẽ xuất hiện dạng đột biến bị ức chế do tái tổ hợp làm tách rời không bị kìm hãm bởi đột biến ức chế.
c ch
DẠYKÈMQUYNHƠN
40
Độ
ột ít kiểu hình đột biến. 6.2.2. Đột biến ức chế
t biến ứ
ế
Đột biến ức chế có thể xảy ra trong cùng một gen, ngoài gen hoặc ở gen khác. Các đột biến ức chế có thể thực hiện tác động bằng nhiều cách khác nhau. Ví dụ, các đột biến ức chế có thể tác động lên sự phiên mã, dịch mã hay những biểu hiện sinh lí khác của tế bào.
OFFICIAL
Đột biến kìm hãm thường gặp hơn, nó có được do 1 đột biến thứ hai làm cho biểu hiện kiểu hình của đột biến không biểu hiện ra được nên có kiểu hình hoang dại. Đột biến kìm hãm có thể xảy ra ngay trên cấu trúc gen. Ví dụ: đột biến thuận mất một nucleotit, đột biến kìm hãm xảy ra gần chỗ đó thêm vào một nucleotit. Đột biến kìm hãm có thể do sự bổ sung trong chu trình trao đổi chất. Sai hỏng do đột biến thứ hai tạo sản phẩm bù trừ được đột biến thứ nhất. Các biến dị ức chế được dùng để nghiên cứu sâu hơn về cơ chế dịch mã. Ví dụ, các đột biến ảnh hưởng tới anticodon của tRNA, làm thay đổi tính đặc hiệu mã hóa của nó, có thể tạo khả năng ức chế đột biến khác ở mức phiên mã. Các đột biến ức chế đối với codon vô nghĩa (nonsens-suppressor) thường xảy ra trên các tRNA, mà anticodon của nó có thể bị biến thành anticodon bổ sung với codon kết thúc do sự thay thế một nucleotit. Các nonsens - suppressor như vậy thường là trội. Có thể xảy ra các đột biến ức chế đối với các đột biến nhầm nghĩa. Ví dụ, tRNAgly của axit amin glycine có anticodon CCC thường bắt cặp với GGG (gly) trên mRNA. Sự biến đổi đột biến của anticodon thành CUC dẫn đến chỗ tRNAgly đột biến bắt cặp với GAG (glutamic axit). Như vậy, nếu như đột biến thuận ở một gen cấu trúc nào đó biến codon GGG (glycine) thành GAG (glutamic axit) của đột biến nhầm nghĩa (missens mutation), thì sự ức chế đối với đột biến này có thể do đột biến của tRNAgly với anticodon CUC sẽ gắn glycine vào chỗ bị đột biến (ở đột biến nhầm nghĩa là glutamic axit).
Các đột biến xảy ra trên tRNA có thể là đột biến ức chế đối với các đột biến lệch khung.
Sự ức chế ở mức phiên mã có thể xảy ra do các đột biến trên các gen mã hóa một số protein của riboxom.
VI. DI TRUYỀN HỌC Ở CÁC
VI SINH VẬT 1.
NHÓM
truyền học virrut Virut có cấu tạo đơn giản và rất nhỏ nên được phát hiện muộn hơn. Việc các nhà vật lí học khi chuyển sang lĩnh vực sinh học đã sử dụng các virut vào nghiên cứu di truyền học cho thấy rõ tầm quan trọng của các đối tượng này. Di truyền học virut đã góp phần đáng kể cho sự phát triển của sinh học phân tử. Sự hiểu biết chi tiết về các virut không những giúp con người biết rõ các cơ nguyên gây nhiều bệnh hiểm nghèo (ung thư, AIDS, ...), mà còn có thể biến chúng thành các công cụ chuyển gen có lợi cho con người
DẠYKÈMQUYNHƠN
41
Di
Virut được coi là những thực thể sống chưa có cấu tạo tế bào. Các virut hay các virion là những dạng sinh vật có cấu tạo đơn giản nhất. Xét từ góc độ phân loại học, sinh giới có thể chia thành hai nhóm lớn: các sinh vật có cấu tạo tế bào và virut.
1.1. Đặc điểm chung của virut
Virut có rất nhiều điểm khác vi khuẩn vơi đặc tính rất nhỏ bé, cấu tạo đơn giản. Virut nhỏ nhất có đường kính chỉ 20 nm, nhỏ hơn cả riboxom.
Ngoài ra, virut khác với các sinh vật có cấu tạo tế bào ở nhiều điểm:
Virut là các thể nội kí sinh bắt buộc, không có cấu tạo tế bào. Chúng phát triển và sinh sản chỉ trong các tế bào sống của vật chủ chuyên biệt.
Virut sử dụng bộ máy sinh tổng hợp của tế bào chủ để sinh sản và thường phá hủy tế bào chủ để phóng thích thế hệ virut con tiếp tục gây nhiễm các vật chủ mới.
OFFICIAL
Virut có bộ gen chỉ gồm một loại nucleic axit (DNA hoặc RNA), trong khi đó các tế bào có cả hai loại, được bao trong vỏ protein. Phần lớn virut gồm 1 loại nucleic axit và một ít loại protein.
Chúng không có hệ thống sinh tổng hợp protein riêng (không có riboxom); không có hệ thống trao đổi chất riêng nên không biến dưỡng năng lượng (không phân hủy thức ăn để tạo ATP), không thực hiện sự lên men, hô hấp và quang hợp.
Virut không tạo màng lipit riêng, mặc dù một số virut có màng ngoài (envelope) được tạo ra bằng biến đổi màng của tế bào chủ trước khi thoát ra khỏi tế bào chủ.
Virut không bị tác động bởi các thuốc kháng sinh vì không có cấu trúc vách tế bào và bộ máy sinh hóa riboxom như tế bào vi khuẩn.
Virut không có khung xương tế bào (cytoskeleton) hoặc phương tiện di động ngoài sự khuếch tán.
Virut không “tăng trưởng” theo nghĩa là tăng khối lượng, khi virut đã hình thành nó không tăng kích thước. Hình dạng đặc trưng của virut được xác định bởi vỏ protein.
Virut đã hình thành trọn vẹn được gọi là virion, bộ gen của nó được gói trong vỏ protein và bên ngoài có thể có màng bao bọc.
1.2. Cấu tạo virut
Virut có bộ gen rất đa dạng. Bộ gen (Genome) của virut có thể là DNA mạch kép (double strand - dsDNA), DNA mạch đơn (single strand - ssDNA), RNA mạch kép (double strand - dsRNA), hay RNA mạch đơn (single strand - ssRNA). Các virut có DNA hoặc RNA mạch đơn còn phân biệt thành 2 dạng dương hay cộng (+) và âm hay trừ (–):
Virut mạch dương (Plus (positive)-strand virut): virut với bộ gen RNA hay DNA mà bộ gen có cùng trình tự nucleotit như mRNA của virut.
DẠYKÈMQUYNHƠN
42
Virut mạch âm (Minus (negative)-strand virut): virut với bộ gen RNA mà mạch RNA này có trình tự nucleotit ngược chiều (bổ sung với) với mRNA của virut.
Bộ gen virut thường là một phân tử nucleic axit ở dạng vòng tròn hay thẳng. Virut nhỏ nhất có chừng 4 gen, virut lớn nhất có chừng vài trăm gen. Vỏ protein bọc bộ gen được gọi là capsid thường có thể ở dạng hình que, hình ống xoắn, hình đa diện hay phức tạp. Nucleocapsid là phức hợp nucleic axit và các protein của một virut. Các capsid thường được tạo nên bởi một số lớn tổ hợp các phân tử protein gồm ít loại, được gọi là capsome. Ví dụ, virut đốm thuốc lá có một capsid hình que dài cứng được tạo ra từ hơn 1000 capsome
OFFICIAL
Hình 20: Virut đốm thuốc lá
a) Sơ đồ cấu trúc; b) Ảnh hiển vi điện tử.
Trong các loại virut, các virut nhiễm vi khuẩn có capsid phức tạp nhất. Các virut của vi khuẩn được gọi là bacteriophage (thực khuẩn thể - ăn vi khuẩn) hay gọi ngắn là phage. Các phage đầu tiên gây nhiễm E. coli được nghiên cứu mang tên T1, T2, T3...T7 (T từ chữ typ). Các phage T chẵn (T2, T4, T6) có cấu trúc rất giống nhau. Capsid của chúng gồm một đầu đa diện (20 mặt) bọc chất di truyền. Phần thứ hai là bao đuôi bằng protein thành ống dài và phần thứ ba là sợi đuôi dài bám vào tế bào vi khuẩn khi gây nhiễm.

Tóm lại, virut được mô tả theo 4 tiêu chuẩn căn bản khác nhau:
- Bộ gen (Genome) chỉ gồm một loại phân tử là DNA hay RNA.
- Nucleic axit bộ gen là mạch đơn (single strand - ss) hay mạch kép (double strand - ds)
- Hình dạng (shape) của virion đơn giản hay phức tạp.
- Virion có hay không màng bao (membrane hay envelope).
1.3. Sao chép của các virut Các hạt virut (virion) là những vật kí sinh nội bào bắt buộc (obligate intracellular parasite). Chúng chỉ biểu hiện các gen của chúng và sinh sản bên trong 1 tế bào sống khác. Căn cứ vào loại tế bào chủ mà virut kí sinh, người ta gọi tên loại virut: virut kí sinh trên thực vật, virut kí sinh trên động vật, vi rút kí sinh vi sinh vật.
DẠYKÈMQUYNHƠN
43
Do đặc điểm này, sự sinh sản của virut khác hẳn với sự sinh sản của tế bào. Điểm nổi bật là virut tạo ra hàng trăm hay hàng ngàn virion trong mỗi thế hệ.
Do có sự đa dạng như nêu trên, các bộ gen của virut được sao chép theo nhiều con đường khác nhau:
Các DNA mạch kép –> DNA mạch kép: kiểu bán bảo tồn.
Các RNA mạch kép –> RNA mạch kép: kiểu bán bảo tồn nhờ RNA replicaz do gen tạo enzym sao chép này được mã hóa trong bộ gen của virut RNA.
Các DNA hoặc RNA mạch đơn –> chúng làm khuôn (mạch +) để tổng hợp mạch bổ sung (mạch –) thành dạng mạch kép trung gian (+/–), gọi là dạng sao chép (replicative form), mà từ nó lấy mạch – làm khuôn tạo ra mạch đơn + giống bộ gen ban đầu của virut.

OFFICIAL
Ở Retrovirut RNA –> nhờ enzym reverse transcriptaz tổng hợp c- DNA mạch đơn từ khuôn RNA virut –> c-DNA kép –> Chèn vào bộ gen tế bào chủ –> tạo ra bộ gen RNA virut mới và mRNA.
Phụ thuộc vào bộ gen DNA hay RNA mạch kép hay đơn, mạch dương (+) hay âm (–), kiểu sao chép bộ gen và tổng hợp mRNA, các virut được chia thành 7 lớp (classes).
Một cách sao chép đặc biệt được tế bào vi khuẩn sử dụng trong tiếp hợp để truyền phân tử DNA dạng thẳng sang tế bào khác hoặc được các virut sử dụng để tạo các bộ gen của chúng, mặt khác làm đứt mạch của vòng tròn xoắn kép, tạo đầu hở 3’–OH và 5’–P kết thúc. Helicaz và SSB protein chen vào tạo chẽ 3 sao chép. Sự sao chép được thực hiện không cần mồi (primer) vì mạch 3’–OH sẵn sàng cho việc nối dài như mạch trước (leading strand) nhờ DNA polymeaz I. Đồng thời với sao chép mạch trước, mạch khuôn sau dịch chuyển. Sự dịch chuyển của mạch sau gián đoạn để tổng hợp các đoạn ngắn Okazki như bình thường và đầu 5’ mạch khuôn duỗi thẳng ra . Sự sao chép có hình giống chữ sigma của Hi Lạp, nên được gọi là sao chép sigma. Kiểu sao chép này còn được gọi là vòng tròn quay (rolling-circle replication), vì mạch khuôn tròn ở giữa không bị đứt và quay tròn làm khuôn cho mạch trước. Sự sao chép kiểu này có thể lặp lại vài lần tạo ra sợi DNA dài, lặp lại nhiều lần bộ gen thẳng của virut, được gọi là concatemer. Enzym endonucleaz cắt ở những điểm khác nhau trên mỗi mạch của DNA tạo ra các đoạn cỡ bộ gen với hai đầu “dính”. Bộ gen thẳng này sẽ tạo thành vòng nhờ bắt cặp bổ sung các đầu “dính”.
DẠYKÈMQUYNHƠN
Hình 21: Sao chép kiểu sigma
1.4. Sự tự ráp (Self-assembly) của các virion
Các gen của virut sử dụng các enzym, chất dinh dưỡng, riboxom và các nguồn khác của tế bào chủ để tạo ra nhiều bản sao của bộ gen và các protein của các cấu phần khác (capsid, cổ, bao đuôi...). Khi các sản phẩm riêng lẻ đã tích đủ, chúng tự ráp (selfassembley) nhau thành số lượng lớn các virion rồi phá vỡ tế bào tìm các tế bào chủ mới.
Sự ráp nucleic axit của virut với các protein của capsid để hình thành virion mới diễn ra tự động tương tự các mạch polypeptit tự gắn với nhau để tạo nên các protein có cấu trúc bậc bốn. Các cấu phần được gắn với nhau bằng liên kết yếu nên không cần enzym.
OFFICIAL
1.5. Tái tổ hợp ở phage
Các phage tuy có kích thước nhỏ bé phải nhìn dưới kính hiển vi điện tử mới thấy được. Nhưng các tính trạng của phage được quan sát dựa theo các vết tan (Plaque) hoặc biên độ chủ. Vết tan (Plaque) là vùng tan hay sự ức chế tế bào gây ra bởi sự nhiễm virut của các tế bào nhạy cảm. Phage T2 có dòng hoang dại r+ tạo vết tan bình thường, còn dòng đột biến r (rapid hoặc ký hiệu r –) làm tan nhanh nên vết tan to.
Lai: T2 h+r x T2 hr+
T2 hr+ , T2 h+r T2 h+r+ , T2 hr
Thế hệ phage con: Các dạng cha mẹ Các dạng tái tổ hợp

Sự nhiễm kép haiphage
Cơ chế tái tổ hợpgen Hình 22: Tái tổ hợp ở phage
Sự xuất hiện các dạng tái tổ hợp T2 h+r+ và T2 hr chứng tỏ 2 dòng phage T2 đã lai với nhau.
Tái tổ hợp ở virut có các đặc điểm:

DẠYKÈMQUYNHƠN
45
Trong quá trình lai ở virut có sự tham gia của cả bộ gen như Eukaryota chứ không từng phần như ở vi khuẩn.
Quá trình tái tổ hợp có tính quần thể. DNA của 2 dòng phage xâm nhập vào tế bào vi khuẩn, chúng sao chép ra hàng trăm bản sao và giữa hàng trăm DNA bộ gen của phage đã xảy ra tái tổ hợp. Do điều này, ở phage thường thấy hiện tượng nhiễu âm (negative interference) trong tái tổ hợp: tần số tái tổ hợp đôi giữa 2 locus đáng lẽ phải giảm thì lại tăng cao hơn mức bình thường.
2. Di truyền học vi khuẩn
Các sinh vật Prokaryota như vi khuẩn, vi khuẩn lam cũng có các quá trình sinh sản tương đương sinh sản hữu tính, được gọi là cận hữu tính (parazxuality). Sự di truyền nhờ các quá trình cận hữu tính này ở vi khuẩn có những đặc điểm:
OFFICIAL
Truyền thông tin một chiều từ tế bào cho (donor) sang tế bào nhận(recipient). Tạo thành hợp tử từng phần (merozygote). Thể cho (donor) chỉ chuyển một đoạn của bộ gen sang thể nhận (recipient) nên chỉ lưỡng bội ở một phần, các phần khác đơn bội.
Bộ gen thường chỉ là một DNA trần nên chỉ có một nhóm liên kết gen và tái tổ hợp thực chất là giữa hai phân tử DNA trần trong biến nạp, hay phage trong tải nạp, hoặc nhờ giao nạp khi 2 tế bào khác giới tính gắn với nhau.
Bản đồ di truyền vi khuẩn được xây dựng nhờ các phương phác khác nhau: giao nạp gián đoạn hoặc không gián đoạn, tái tổ hợp hay dùng mất đoạn.
Plasmid là những DNA vòng tròn có thể tồn tại độc lập hoặc chèn vào DNA tế bào chủ có vai trò quan trọng trong chuyển gen.
Transposition là sự chuyển vị gen gồm IS, Tn và phage Mu. Các phần tử di động có thể gây biến đổi sự biểu hiện gen.
2.1. Kiểu hình và kiểu gen của vi khuẩn Các đột biến có thể tác động đến 5 loại kiểu hình: Biến đổi từ nguyên dưỡng (prototrophy) sang khuyết dưỡng (auxotrophy) và ngược lại. Ví dụ mất khả năng tổng hợp một chất trao đổi của chu trình và hồi biến để lại có khả năng tổng hợp chất đó. Sự mất hay có được khả năng sử dụng chất dinh dưỡng khác. Ví dụ: đột biến làm mất khả năng sử dụng đường lactoz.
Tính nhạy cảm hay đề kháng thuốc như nhạy cảm streptomycin đột biến thành kháng streptomycin.
Nhạy cảm với phage thành kháng phage hoặc ngược lại. Ví dụ: đột biến trên thụ thể ở bề mặt tế bào làm đề kháng với sự nhiễm phage.
DẠYKÈMQUYNHƠN
46
Sự mất đi hoặc có lại các thành phần cấu trúc của bề mặt tế bào. Ví dụ, một loại Pneumococcus có vỏ bao polysacarit (polysacarit capsule), trong khi đó dòng khác không có vỏ bao.
2.2. Sinh sản ở vi khuẩn Tế bào vi khuẩn phân chia theo lối trực phân. Phân tử DNA gắn trực tiếp vào màng sinh chất. Sự sao chép DNA tạo ra hai bản sao gắn chung nhau trên màng sinh chất. Khi tế bào kéo dài ra, các bản sao DNA tách xa nhau do phần màng giữ chúng lớn dần ra. Kiểu sinh sản vô tính này được gọi là “phân đôi” hay “ngắt đôi” (“binary fission”). Tế bào vi khuẩn chia nhanh (20 phút trong điều kiện tốt) hơn rất nhiều so với tế bào Eukaryota (24-48 giờ).
Quá trình sao chép DNA được bắt đầu từ điểm xuất phát oriC kéo dài về hai phía song song với quá trình sao chép màng sinh chất, nơi có điểm gắn vào của DNA bộ gen, mọc dài tách 2 phân tử DNA về 2 tế bào con.
OFFICIAL
DNA của E. coli cần 40 phút cho 1 vòng sao chép tương ứng với tốc độ 50.000 cặp bazơ/phút. Phụ thuộc vào tốc độ tăng trưởng, thời gian phân chia tế bào trong khoảng từ 18 đến 60 phút. Như vậy ở các tế bào tăng trưởng nhanh, vòng sao chép mới phải được bắt đầu sớm hơn sự phân bào trước đó như tế bào con đầu tiên.
2.3. E. coli là tế bào chủ căn bản của kỹ thuật di truyền
Các dữ liệu di truyền học của vi khuẩn mô hình - E. coli
Escherichia coli (E. coli) là vi khuẩn được nghiên cứu kĩ nhất, rất nhiều chủng khác nhau đã được phân lập. Do những thuận tiện trong nuôi cấy, nhân giống, thu nhận các đột biến và dễ phân tích các sự kiện di truyền hiếm hoi. Đến nay, nó được coi là đối tượng mô hình số một của Sinh học phân tử và công nghệ gen.
Kích thước bộ gen (Genome size): 4,6 Mb, không chứa intron, với số lượng khoảng 4000 gen, trong đó có 8% gen tương đồng với gen người, số lượng transposon khoảng 60 bản sao/bộ gen tuỳ chủng. NST là một phân tử DNA vòng tròn, dạng trần
E. coli có nhiều đóng góp trong việc nghiên cứu các cơ chế di truyền ở cấp độ phân tử tế bào nhân sơ, đồng thời cũng đóng góp cho nghiên cứu các lĩnh vực khác: Trao đổi chất của tế bào (Cell metabolism), gen ức chế vô nghĩa (Nonsense suppressors), sự tuyến tính (Colinearity) giữa gen và polypeptit, các Operon, sự đề kháng thuốc dựa vào plasmid (Plasmid-bazơd drug resistance) và sự vận chuyển tích cực (Active transport).
2.4. Các phương pháp phân tích di truyền Ngoài các phương pháp lai để phân tích tái tổ hợp (recombination) và bổ trợ (complementation), có nhiều kỹ thuật biến đổi di truyền (Techniques of Gentic Modification): - Gây đột biến (Mutagensis):
DẠYKÈMQUYNHƠN
47
Hóa chất và chiếu xạ: đột biến xoma ngẫu nhiên.
Dùng transposon: xen đoạn (Insertions) xoma ngẫu nhiên.
- Chuyển gen (Transgensis):
Trên vector plasmid: tự do hay chèn vào (integratd).
Trên vector phage: tự do hay chèn vào (integratd).
Biến nạp: chèn vào.
- Làm im lặng gen mục tiêu (Targeted gen knockout):
Alen không (Null alen) trên vector: thay gen bằng tái tổ hợp.
Alen được thiết kế (Engineered alen) trên vector: đột biến điểm định hướng (Site-directed mutagensis) bằng thay gen.
OFFICIAL
2.5. Quá trình tổng hợp axit nucleic Các enzym và protein tham gia tổng hợp và phân giải axit nucleic
Enzyme Gen mã hoá Chức năng
DNA polymeaz III polC; DNAE,Q,N,X Enzym polyme hoá chủ yếu
DNA polymeaz I polA-E, mutD, pol A
Cắt mồi RNA, lắp chỗ trống
Tháo xoắn ở chẻ ba sao chép Primaz DNAG Tạo mồi mạch DNA mới
Helicaz DNAB
Protein gắn điểm khởi đầu (Origin binding)
Protein căng mạch SSB (Singlestrand binding protein)
DNAA Gắn điểm khởi đầu sự sao chép (Ori), tạo thuận lợi cho mở tách mạch
Ssb
Ngăn các mạch đơn đã tách không chập lại
AND ligaza ligA, lig B
Nối các đầu hở trên DNA Bảng 3: Các enzym tham gia sao chép DNA ở vi khuẩn E. coli.
Enzyme Gen mã hoá Chức năng
DNA polC; Enzyme phục hồi
DẠYKÈMQUYNHƠN
48
polimeraza I DNAE,Q,N,X chủ yếu, cắt mồi RNA và lấp kín khoảng trống
DNA polimeraza II polA, mutD Enzyme phục hồi phụ (minor)
DNA polimeraza III polB
DNA polimeraza IV polC
DNA polimeraza V DNAB , mutD, C
Replicaz, polyme hoá chủ yếu
Phục hồi cấp cứu (SOS repair)
Phục hồi cấp cứu (SOS repair)
Bảng 4: Các enzyme DNA polymeraza ở vi khuẩn E. coli
OFFICIAL
Các enzyme tham gia vào sự phân giải axit nucleic: Deoxyribonucleaz (DNAaz) là enzym cắt các liên kết trong phân tử DNA. Nó có thể cắt mạch đơn hay kép. Gyraz là một loại enzym topoixomraz cắt DNA làm tháo xoắn.
Ribonucleaz (RNAaz) là các enzym cắt RNA, có thể đặc hiệu đối với RNA mạch đơn hay mạch kép.
Các nucleaz chia thành 2 nhóm: Exonucleaz cắt từng nucleotit một từ đầu mút của mạch polynucleotit; chúng có thể đặc hiệu đối với đầu mút 5’ hay 3’ của DNA hay RNA.
- Endonucleaz cắt các liên kết bên trong mạch DNA; chúng có thể đặc hiệu đối với RNA hay DNA mạch đơn hoặc mạch kép.
2.6. Các cơ chế di truyền ở vi khuẩn Trao đổi thông tin di truyền ở vi khuẩn: biến nạp, tải nạp và tiếp hợp khác nhau ở các phương tiện để đưa DNA từ tế bào cho vào tế bào nhận.
2.6.1. Biến nạp
Hiện tượng biến nạp được Griffith phát hiện ở vi khuẩn Diplococus pneumoniae (nay gọi là Streptococus pneumoniae - phế cầu khuẩn gây sưng phổi ở động vật có vú) vào năm 1928. Phát hiện này và các nghiên cứu về cơ chế biến nạp có ý nghĩa lịch sử cho sự ra đời của Sinh học phân tử. Vi khuẩn này có 2 dạng khác nhau: – Dạng SIII, gây bệnh có vỏ bao tế bào (capsule) bằng polysaccharid cản trở bạch cầu phá vỡ tế bào. Dạng này tạo khuẩn lạc trơn (Smooth) trên môi trường agar.
DẠYKÈMQUYNHƠN
49
– Dạng RII, không gây bệnh, không có vỏ bao, tạo đốm mọc nhăn (Roughnhăn).
Thí nghiệm tiến hành như mô tả trên hình:
Hình 23: Hiện tượng biến nạp.
Tiêm vi khuẩn S sống gây bệnh cho chuột - chuột chết.
Tiêm vi khuẩn R sống không gây bệnh - chuột sống.
Tiêm vi khuẩn S bị đun chết cho chuột - chuột sống.

Hỗn hợp vi khuẩn S bị đun chết trộn với vi khuẩn R sống đem tiêm cho chuộtchuột chết. Trong xác chuột chết có vi khuẩn S và R.
Hiện tượng trên cho thấy vi khuẩn S không thể tự sống lại được sau khi bị đun chết, nhưng các tế bào chết này đã truyền tính gây bệnh cho tế bào R. Nó được gọi là biến nạp (transformation). Năm 1944, T. Avery, Mc Leod và Mc Carty đã tiến hành thí nghiệm xác định rõ tác nhân gây biến nạp. Nếu các tế bào S bị xử lý bằng proteaz (enzym phân hủy protein) hoặc RNA-az (enzym phân hủy RNA) hoạt tính biến nạp vẫn còn, chứng tỏ protein và RNA không phải là tác nhân gây biến nạp. Nhưng nếu tế bào S chết bị xử lý bằng DNA-az (enzym chỉ phân hủy đặc hiệu DNA) thì hoạt tính biến nạp không còn nữa, chứng tỏ DNA là nhân tố biến nạp mang tín hiệu di truyền. Như vậy, biến nạp là hiện tượng truyền thông tin di truyền bằng DNA. Trong biến nạp, DNA trần từ một tế bào vi khuẩn (thể cho) này được truyền sang tế bào vi khuẩn khác (thể nhận). Biến nạp xảy ra khi vi khuẩn nhận DNA ngoại lai và hấp thu vào trong tế bào. Khi tế bào vi khuẩn bị vỡ do bị tan (lysis), DNA vòng tròn của chúng
DẠYKÈMQUYNHƠN
50
OFFICIAL
thoát ra môi trường thành các đoạn thẳng với chiều dài khác nhau, có khả năng gây biến nạp cho các tế bào nhận khác.
Biến nạp được nghiên cứu kĩ nhất ở các vi khuẩn Streptococcus pneumoniae, Bacillus subtilis, Haemophilus influenzae và ở một số nhóm vi khuẩn khác.
Hiệu quả của biến nạp phụ thuộc vào 3 yếu tố:
Tính dung nạp của tế bào nhận.
Kích thước của đoạn DNA ngoại lai.
Nồng độ của DNA
Cơ chế phân tử
Quá trình biến nạp ở cấp độ phân tử gồm các giai đoạn chủ yếu:
OFFICIAL
Sự phân hủy DNA tế bào cho: DNA tế bào cho có thể là của tế bào tự nhiên bị phân hủy hoặc trong thí nghiệm gây tác động bằng nhiệt độ cao hay tác nhân phá vỡ tế bào.
DNA bám vào bề mặt tế bào: Protein gắn vào DNA.

Thâm nhập của DNA: Sợi DNA mạch kép của dòng vi khuẩn S sau khi chui qua màng tế bào của dòng R thì một mạch S sẽ bị nucleaz của tế bào cắt, còn lại một mạch nguyên (thí nghiệm của Griffith)
Bắt cặp (Synapsis)và tái tổ hợp: Nhờ sự hỗ trợ của protein RecA DNA của thể nhận R sẽ biến tính tách rời 2 mạch ở 1 đoạn dễ bắt cặp với đoạn DNA thể cho S vừa chui vào
DẠYKÈMQUYNHƠN
Hình 24: Sơ đồ diễn biến của quá trình biến nạp ở cấp độ phân tử
a. DNA bám vào. b. Thâm nhập. c. Bắt cặp và tái tổ hợp. d. – Tế bào biến nạp
Sao chép: Sau khi bắt cặp tạo đoạn lai R - S, phân tử DNA sao chép tạo ra 2 sợi, một sợi kép R-R và sợi kép khác có mang đoạn DNA thể nhận S-S. Kết quả cuối cùng là đoạn gen của SIII chèn vào bộ gen tế bào nhận. Sau phân bào thì một dòng tế bào nhận được DNA ngoại lai vào bộ gen - tế bào được biến nạp. Tế bào đã được biến nạp sinh sản tạo dòng nhận RII mới.
2.6.2. Tải nạp (Transduction)
OFFICIAL
Việc tìm ra biến nạp đã thúc đẩy nghiên cứu dẫn đến phát minh ra tải nạp, là hiện tượng truyền DNA qua trung gian virut từ tế bào cho đến tế bào nhận. Có hai kiểu tải nạp: chung và chuyên biệt.
Trong tải nạp (transduction), các virut có chức năng như vật trung gian để đưa DNA từ vi khuẩn cho vào vi khuẩn nhận bằng cách lây nhiễm. Ở chu trình tan (lytic cycle), một số bacteriophage gói nhầm DNA vi khuẩn chủ vào capsid. Tế bào bị nhiễm bởi các virut như vậy nhận đoạn DNA của vi khuẩn A khác, chứ không phải DNA của virut. Do vậy, DNA vi khuẩn A tái tổ hợp với DNA nhiễm sắc thể của tế bào chủ B và biến đổi thành phần di truyền.

Phage là nhân tố chuyển gen
Thí nghiệm được tiến hành trong ống hình chữ U, ở đáy ống được ngăn cách bằng màng lọc vi khuẩn. Màng có lỗ nhỏ vi khuẩn không qua được, nhưng phage qua được (hình 25). Nhánh A của ống chứa vi khuẩn có khả năng tổng hợp tryptophan (trp+), còn nhánh B nuôi các vi khuẩn mất khả năng tổng hợp tryptophan (trp–). Sau một thời gian nuôi bên nhánh B xuất hiện vi khuẩn có khả năng tổng hợp tryptophan (trp+). Qua nhiều lần thí nghiệm việc phage tải gen trp+ từ nhánh A sang nhánh B được chứng minh.
DẠYKÈMQUYNHƠN
Hình 25: Thí nghiệm chứng minh có tải nạp do virut
a. Tải nạp chung (Genral transduction)
Tải nạp chung xảy ra khi phage mang bất kì gen nào của vi khuẩn A chuyển sang vi khuẩn B.
Tải nạp chung (genralized transduction) có các đặc điểm:

- Thường do phage kiểu P1 thực hiện.
- Bất kì gen nào của vi khuẩn cũng đều được tải nạp.
- Tải nạp có được do gói nhầm DNA của tế bào chủ khi phage trưởng thành.
- Các thể tái tổ hợp đơn bội được tạo ra.
Do không có sự tương đồng giữa trình tự DNA trên các phage này với trình tự ở tế bào chủ, nên không có điểm gắn vào đặc hiệu cho prophage. Bất kì gen nào cũng được tải nạp vì đầu của phage có thể gói nhầm vào một đoạn DNA của tế bào chủ. Sự đồng tải nạp (cotransduction) là quá trình tải nạp đồng thời 2 gen.
Quá trình phage xâm nhập vào vi khuẩn và sinh sản được mô tả trên hình 26 Đầu tiên phage bám trên bề mặt của vi khuẩn, sau 4 phút bơm DNA của nó vào tế bào, sau đó chúng sinh sản và độ nửa giờ sau thì làm tan vi khuẩn và giải phóng các phage con mới.
DẠYKÈMQUYNHƠN
53
OFFICIAL
Hình 26: DNA phage Nhiễm sắc thể vi khuẩn và Phage mới phá vỡ tế bào Quá trình xâm nhập của phage và làm tan vi khuẩn Khi DNA của phage xâm nhập tế bào vi khuẩn A, chúng cắt DNA của vi khuẩn A thành nhiều đoạn, đồng thời DNA của phage được sao chép thành nhiều phân tử con và các vỏ capsid của phage cũng được tạo thành. Sau đó các vỏ capsid được lắp ruột DNA vào, phá vỡ tế bào vi khuẩn ra ngoài và tiếp tục xâm nhập các vi khuẩn mới. Trong quá trình lắp ráp khoảng 1-2% phage, vô tình mang đoạn DNA của vi khuẩn có chứa gen. Phage mang gen của vi khuẩn A xâm nhập vi khuẩn B, quá trình tái tổ hợp xảy ra làm gen A gắn vào bộ gen B.

b. Tải nạp chuyên biệt (Special transduction)
Tải nạp chuyên biệt hay hạn chế (restricted transduction) là trường hợp chỉ mang một vài gen nhất định, nó có 4 đặc điểm:
OFFICIAL
- Những gen được chuyển nằm sát chỗ prophage gắn vào.
- Chỉ prophage lamda thực hiện.
- Do kết quả sự cắt sai của prophage khi tách khỏi nhiễm sắc thể của tế bào chủ.
- Các vi khuẩn tái tổ hợp có thể lưỡng bội một phần. Ví dụ: Phage chỉ mang gen gal (đồng hóa đường galactoz) từ vi khuẩn này chuyển sang vi khuẩn khác.
Hình 27: Điểm gắn của phage vào bộ gen vi khuẩn Điểm gắn của phage vào bộ gen của vi khuẩn nằm giữa 2 gen gal (galactoz) và bio (tổng hợp biotin), tiếp theo xảy ra quá trình tái tổ hợp ở điểm chuyên biệt (sitespecific recombination) chèn DNA của phage vào nhiễm sắc thể vi khuẩn Đầu của phage chỉ có thể chứa một lượng DNA giới hạn, nó chỉ tải nạp được gen gal hoặc bio. Phage tải nạp các gen galactoz được gọi là gal hay dg (d = defective: khuyết, g = galactoz). Nếu tế bào gal– được nhiễm bởi dg (mang gen gal+), sự ráp phage biến dạng vào tế bào chủ sẽ tạo lưỡng bội một phần. Sự cắt sai của phage rất hiếm nên tải nạp hạn chế có tần số thấp.
DẠYKÈMQUYNHƠN
54
Tuy nhiên, tải nạp tần số cao có thể nhận được trong điều kiện thí nghiệm. Nếu tế bào vi khuẩn được gây nhiễm kép với phage hoang dại và phage dg, phage hoang dại có thể hỗ trợ chức năng sai sót ở phage biến dạng, và thế hệ con sẽ có cả 2 kiểu với số lượng bằng nhau. Khi dịch tan được dùng tải nạp, quá trình được gọi là tải nạp tần số cao.
Trong nhiều trường hợp, do bộ gen biến dạng dg không gắn được vào bộ gen của tế bào chủ (nên không sao chép được). Sau mỗi lần phân bào, chỉ một trong 2 tế bào có bộ gen của phage biến dạng; quá trình này được gọi là tải nạp sẩy (abortive transduction).
2.6.3. Giao nạp (Conjugation)
Giao nạp ở vi khuẩn là sự kết hợp nhất thời của hai tế bào có kiểu bắt cặp đối nhau, được tiếp nối bằng sự chuyển một phần hoặc toàn bộ vật chất di truyền từ tế bào cho sang tế bào nhận qua cầu tế bào chất, và sau đó các tế bào tách nhau ra (exconjugants). Giao nạp đòi hỏi sự tiếp xúc trực tiếp giữa 2 loại tế bào được khởi sự bằng ống giao nạp hay tính mao (pilus), một sợi ống nhỏ rất dài do tế bào cho (donor cell) tạo ra. Khả năng cho nhận được xác định bởi các plasmid liên hợp cụ thể được gọi là plasmid khả năng sinh sản hoặc plasmid giới tính.
OFFICIAL
Plasmid F (còn gọi là yếu tố F) của E. coli là nguyên mẫu cho plasmid khả năng sinh sản ở vi khuẩn Gram âm. Các chủng E. coli có plasmid F ngoài nhiễm sắc thể được gọi là F+ và có chức năng là người cho, trong khi các chủng không có plasmid F là F– và hoạt động như người nhận. Các chức năng liên hợp của plasmid F được quy định bởi một cụm gồm ít nhất 25 gen chuyển xác định sự biểu hiện của F pili, tổng hợp và chuyển ADN trong quá trình giao phối, can thiệp vào khả năng của vi khuẩn F+ để phục vụ như là người nhận, và các chức năng. Mỗi vi khuẩn F+ có 1 đến 3 F pili liên kết với một protein màng ngoài cụ thể (sản phẩm của gen ompA) trên vi khuẩn nhận để bắt đầu giao phối.
Hình 28: Hai tế bào vi khuẩn giao nạp qua cầu tế bào chất pilus DNA được truyền qua một cầu tế bào chất mỏng (a thin cytoplasmic bridge) gọi là ống giao nạp (conjugation tube). Kiểu sao chép sigma được tế bào vi khuẩn sử dụng trong giao nạp để truyền phân tử DNA dạng thẳng sang tế bào khác. Khi đoạn DNA vào bên trong tế bào nhận (recipient cell), nó thực hiện tái tổ hợp với các gen tương đồng (homologous gens).

DẠYKÈMQUYNHƠN
55
2.6.4. Hiện tượng lai ở vi khuẩn Vào năm 1946, J. Lederberg và E. Tatum đã sử dụng các dòng đột biến khuyết dưỡng khác nhau ở E. coli để chứng minh có tái tổ hợp giữa các dòng vi khuẩn khác nhau. Cụ thể dòng A có kiểu gen met–bio–thr+leu+thi+ (có khả năng tổng hợp threonin, leuxin và vitamin B1 (thiamin) và không tổng hợp được metionin và biotin), còn ở dạng B thì ngược lại có khả năng tổng hợp metionin và biotin với kiểu gen met+bio+thr–leu- thi-. Trộn A và B trong ống nghiệm, sau đó cấy lên môi trường tối thiểu (Minimal medium - MM). Các khuẩn lạc mọc trên môi trường tối thiểu chứng tỏ có các dạng lai, chúng chỉ mọc lên được nhờ sự bù đắp cho nhau các nhu cầu dinh dưỡng. Dạng lai có kiểu gen met+bio+thr+leu+thi+ mọc được trên môi trường tối thiểu.
Trong khi đó từng dạng A hoặc B riêng lẻ không mọc được trên MT tối thiểu
Dòng A = met–bio–thr+leu+thi+ x dòng B= met+bio+thr–leu-thiDạng lai met+bio+thr+leu+thi+ mọc thành khuẩn lạc, mỗi dạng riêng lẻ không mọc thành khuẩn lạc.

OFFICIAL
t
h
Hình 29: Sơ đồ lai vi khuẩn (MM: môi trường tối thiểu)
p
n có yếu tố giới tính tương tự giống đực và cái ở sinh vật bậc cao: F+ (tương tự giống đực), nó truyền gen sang F- (giống cái). Tần số lai F+ x F- vào khoảng 10-6, tức là lai 1 triệu tế bào thì sẽ có 1 tế bào lai. Khi tiếp xúc với F+ một thời gian tế bào Fsẽ trở thành F-. Dạng Hfr (High frequency of recombination) được phát hiện sau, dạng này có tần số lai với F- cao hơn F+ có thể lên tới 104 lần. Plasmid là phân tử DNA vòng tròn nhỏ có khả năng tồn tại độc lập hoặc gắn vào bộ gen vi khuẩn. Plasmid có thể mang một số gen khác nhau như gen kháng kháng sinh (plasmid R), ... Bản chất di truyền của các dòng F+, F- và Hfr được xác định do các plasmid như sau:
khu
DẠYKÈMQUYNHƠN
56
2.6.5. Tái
ổ
ợ
Ở vi
ẩ
F- không chứa plassmid F+ chứa plasmid ở dạng độc lập Hfr- plasmid được gắn vào bộ gen của vi khuẩn Muốn xảy ra tái tổ hợp thì 2 dòng vi khuẩn phải tiếp xúc với nhau (F+ x F-) hoặc (Hfr x F-). Dòng tế bào mang nhân tố F+ được coi là tế bào “đực” và có khả năng tạo protein pilin, từ protein này tạo ống giao nạp là pilus. Sự co lại của pilus đang nối hai tế bào làm chúng tiếp xúc kề nhau. Tế bào F- được coi là cái (female). Sau khi giao nạp tế bào F– trở thành F+ . Việc chuyển gen chỉ thực hiện khi plasmid gắn vào bộ gen của vi khuẩn. Trong quá trình chuyển vật chất di truyền sang F- thì DNA của tế bào chủ sao chép và mạch mới có ori đi đầu và F ở cuối
Quá trình chuyển DNA từ F+ sang F– có thể bị ngắt quãng.

OFFICIAL
Hình 30: Sự truyền DNA từ thể cho sang thể nhận Hfr X F– Sao chép DNA truyền cho F– Hfr F– tái tổ hợp
Các gen A, B, C được chuyển một chiều từ Hfr sang F–. Đọan gen thể cho bắt cặp với các gen tương đồng của DNA tế bào F– và diễn ra trao đổi chéo tạo tế bào F–tái tổ hợp
Dòng Hfr có tần số lai cao hơn nhiều vì plasmid đã nằm sẵn trong bộ gen. Còn F+ phải qua giai đoạn plasmid gắn vào bộ gen rồi mới chuyển gen.

Trong điều kiện thí nghiệm ở 37oC, nguyên bộ gen của tế bào E. coli được chuyển sang tế bào nhận trong vòng 90 phút. Thường sự giao nạp bị ngắt giữa chừng do các pilus bị gãy, nên ít khi bộ gen được chuyển nguyên vẹn vào tế bào nhận. Lúc đó tế bào F–vẫn là F–.
Hình 31: Đoạn DNA từ thể cho trao đổi chéo với DNA thể nhận tạo F– tái tổ hợp
DẠYKÈMQUYNHƠN
57
2.6.6. Lập bản đồ di truyền nhiễm sắc thể của vi khuẩn
a. Giao nạp ngắt quãng (Interrupted conjugation)
Khi trộn dịch tế bào Hfr với F–, sự tiếp hợp có thể bị ngắt quãng vào thời điểm tùy ý bằng rung lắc mạnh. Mẫu được pha loãng nhanh và cấy lên môi trường chọn lọc. Ngoài ra, dòng Hfr phải có gen đánh dấu hay khuyết dưỡng để chúng không mọc được trên môi trường chọn lọc và chỉ có các dạng tái tổ hợp mọc lên. Sự truyền DNA của Hfr sang F– có tính phân cực, các gen ở đầu sang trước và lần lượt các gen khác theo sau. Nhờ ngắt quãng có thể xác định được thời gian mà một gen được truyền sang F–và khoảng cách giữa chúng. Ví dụ, dòng Hfr có mang các gen nguyên dưỡng (prototrophic) đánh dấu a+, b+, c+ được trộn với dòng F– mang các alen khuyết dưỡng a, b, c. Sự tiếp hợp được ngắt quãng với khoảng cách 5 phút và pha loãng cấy lên môi trường chọn lọc (ví dụ, môi trường tối thiểu). Kết quả như sau:
OFFICIAL
Thời gian (phút) Các thể tái tổhợp 5 a b+c 10 a b+ c+ 15 a+ b+ c+ Bảng 5: Kết quả của sự tiếp hợp ngắt quãng
Trình tự gen ở dòng Hfr là b+ – c+ – a+; b cách đầu mút truyền sang ít hơn 5 phút; c ít hơn 10 phút; a ít hơn 15 phút. Ở đây đơn vị thời gian là phút.
b. Giao nạp không ngắt quãng (Uninterrupted conjugation) Nếu không rung mạnh để ngắt quãng nhân tạo, cầu tế bào chất giữa hai gen càng gần ori (ở đầu của DNA thể cho), xác suất được chuyển sang tế bào nhận càng lớn. Tần số của các gen xuất hiện ở dạng tái tổ hợp trong thể nhận, được phát hiện trên môi trường chọn lọc, tỉ lệ nghịch với khoảng cách so với gen đánh dấu ở đầu. Các gen có nhiều dạng tái tổ hợp xuất hiện thì càng nằm gần phía đầu được chuyển sang tế bào nhận.
Khoảng cách giữa các gen có thể tính bằng 3 loại đơn vị:
DẠYKÈMQUYNHƠN
58
đơn vị thời gian, đơn vị tái tổ hợp và đơn vị cặp bazơ. Ví dụ: Nếu một phút giao nạp tương đương 20 đơn vị tái tổ hợp ở E. coli, và nguyên nhiễm sắc thể (DNA) được chuyển sang trong 100 phút, thì tổng chiều dài là 2000 đơn vị tái tổ hợp. Nếu DNA có 107 cặp nucleotit, thì 1 đơn vị tái tổ hợp bằng 107/2000 = 5000 bp.
2.6.7. Lập bản đồ bằng tái tổ hợp Đặc điểm của tái tổ hợp ở vi khuẩn là chỉ một phần bộ gen được chuyển sang tế bào nhận. Một hay nhiều gen có thể được gắn vào nhiễm sắc thể tế bào nhận nhờ giao nạp và phụ thuộc độ dài đoạn truyền sang. Exogenote phải được gắn vào nhiễm sắc thể nhận thì mới được sao chép và chia về các tế bào trong dòng. Chỉ một đoạn ngắn DNA thường được gắn nhờ biến nạp và tải nạp. Như vậy, nếu hai gen cùng biến nạp (cotransformation) thì hai locus phải liên kết chặt. Tương tự như vậy, hai gen cùng được tải nạp vào phage sẽ ở gần nhau. Mức độ liên kết giữa các gen có chức năng khác nhau (intercistronic) hay giữa các đột biến bên trong gen chức năng (intracistronic) có thể đánh giá từ các kết quả lai chuyên biệt.
Ở hệ thống hợp tử một phần (merozygote), exogenote muốn gắn vào endogenote phải xảy ra 2 trao đổi chéo ở hai đầu vì nếu chỉ có 1 trao đổi chéo thì cả hai sản phẩm nhận được đều mất cân bằng.
Trong các hệ thống này, tổng cá thể tham gia tái tổ hợp không biết được, nên tần số tái tổ hợp không thể tính như ở ruồi giấm (trên tổng số cá thể). Do đó, tần số tái tổ hợp được trình bày tương đối theo một số tiêu chuẩn chung cho tất cả các tổ hợp lai. Ví dụ, số lượng các cá thể tái tổ hợp nguyên dưỡng được tạo ra khi lai hai dòng đột biến có so sánh với kết quả khi lai dạng hoang dại với mỗi loại đột biến. Tuy nhiên có nhiều sai lệch và cần chỉnh lí. Xác định trình tự gen ở vi sinh vật thường phức tạp vì có thể xảy ra hiện tượng nhiễu âm cục bộ (localized negative interference). Phương pháp xác định trình tự gen thường dùng là lai 3 điểm hoán đổi (three - factor reciprocall crosses).
OFFICIAL
Hình 32: Bản đồ di truyền E. coli dòng K12 (theo Brock Microbiology 11,2006)
OriC - điểm khởi sự sao chép; RE – restriction endonucleaz Nost1 Bản đồ di truyền liên kết gen vòng tròn của nhiễm sắc thể ở E. coli dòng K12 (hình 32). Bộ gen của E. coli đã được giải ký tự chuỗi (sequencing) năm 1997, nó gồm 4.639.221 bp (cặp bazơ) với khoảng 4288 ORF (khung đọc mở). Vòng ngoài cùng ghi ký hiệu một số gen, mà mặt trong các số từ 0 đến 100 chỉ vị trí tính theo số phút gen được chuyển qua. Các số ở vòng trong cùng chỉ số kilo cặp bazơ (kbp) tại các điểm

DẠYKÈMQUYNHƠN
59
nhận biết (recognition sites) của enzym cắt hạn chế (RE – restriction endonucleaz) có tên Not 1. Các mũi tên chỉ điểm khởi sự của các dòng Hfr.
2.6.8. Plasmid

Trong phần nói về quá trình giao nạp (conjugation) hay tiếp hợp ở trên đã đề cặp đến plasmid, là những DNA vòng tròn nhỏ hiện diện ở nhiều vi khuẩn. Plasmid là nhân tố di truyền sao chép độc lập với nhiễm sắc thể (Nhiễm sắc thể) của tế bào chủ. Không giống virut, plasmid không có dạng ngoại bào (extracellular form) và tồn tại trong tế bào đơn giản là DNA tự do và điển hình là dạng vòng tròn. Plasmid và DNA Nhiễm sắc thể của tế bào có vài điểm khác nhau cơ bản: plasmid chỉ mang những gen không thiết yếu (nhưng thường rất có ích), còn những gen thiết yếu nằm trên Nhiễm sắc thể.
Plasmid di chuyển giữa các tế bào trong quá trình giao nạp (conjugation), tức sự tiếp xúc giữa hai loại tế bào.
OFFICIAL
Các kiểu plasmid khác nhau được phân lọai dựa vào các gen mà chúng mang. Một số plasmid, các nhân tố trao đổi chất (metabolic factors) mang các gen mã hóa cho các chức năng trao đổi chất khác thường (unusual metabolic functions) như phân hủy dầu mỏ do tràn dầu.
Đến nay đã biết hàng ngàn plasmid khác nhau. Trên thực tế, người ta đã phân lập hơn 300 plasmid khác nhau trong tự nhiên chỉ từ dòng E. coli duy nhất. Nhiều plasmid được sử dụng làm công cụ chuyển gen trong kỹ thuật di truyền.
Sự chuyển plasmid từ tế bào này sang tế bào khác Cơ chế chính của việc chuyển plasmid từ tế bào này sang tế bào khác là giao nạp, mà chức năng thực hiện được mã hóa bởi chính một số plasmid. Giao nạp là một quá trình sao chép DNA và plasmid của tế bào cho và truyền bản sao của Nhiễm sắc thể cùng bản sao plasmid sang tế bào nhận.
Bản đồ gen của plasmid F, một plasmid đã được nghiên cứu rất kĩ của Escherichia coli. Khoảng 25 gen trên F plasmid, bao gồm các gen sao chép DNA, các yếu tố thực hiện chức năng của một epixom và cuối cùng là một vòng cung DNA lớn, gọi là vùng tra, chứa những gen giúp nó tự di chuyển từ tế bào này sang tế bào khác.
Hình 33: Sơ đồ gen của plasmid F của E. coli.
DẠYKÈMQUYNHƠN
60
Plasmid điều khiển sự truyền gen của chính nó bởi sự tiếp xúc của hai tế bào gọi là có khả năng giao nạp. Không phải tất cả plasmid đều có khả năng tiếp hợp. Khả năng truyền trong tiếp hợp được kiểm soát bởi những gen trong plasmid gọi là vùng tra. Vùng tra chứa những gen mã hóa protein thực hiện chức năng bắt cặp. Sự hiện diện của vùng tra ở plasmid có thể dẫn đến kết quả quan trọng khác nếu plasmid chèn vào nhiễm sắc thể. Trong trường hợp này, plasmid có thể huy động sự chuyển DNA nhiễm sắc thể từ tế bào này sang tế bào khác. Một vài plasmid tiếp hợp từ Pseudomonas có biên độ tế bào chủ lớn. Điều này có nghĩa là chúng có thể được truyền sang rất nhiều vi khuẩn Gr+ khác. Những plasmid như thé có thể chuyển thông tin di truyền giữa những sinh vật ở gần nhau. Những plasmid tiếp hợp có thể chuyển giữa vi khuẩn Gr- và Gr+, giữa vi khuẩn và tế bào thực vật và giữa vi khuẩn và nấm. Thậm chí nếu plasmid không thể sao chép độc lập trong vật chủ mới, sự chuyển plasmid tự nó có thể có ý nghĩa tiến hóa quan trọng nếu gen từ plasmid nối lại với bộ gen của vật chủ mới.
OFFICIAL
Vài loại plasmid khác và ý nghĩa sinh học của chúng Mặc dù plasmid không mang những gen thiết yếu đối với vật chủ, nhưng nó có thể ảnh hưởng đáng kể đến kiểu hình của tế bào. Chẳng hạn, khả năng của Rhizobium tương tác với thực vật và hình thành nốt sần ở rễ cố định đạm là nhờ những plasmid thực hiện. Những plasmid khác mang lại đặc điểm biến dưỡng đặc biệt ở tế bào, như sự phân hủy chất gây ô nhiễm độc hại. Thực ra, plasmid dường như là một bộ máy chính để tạo ra những tính chất riêng biệt của vi khuẩn, và trong nhiều trường hợp, còn “xuất khẩu” (export) những đặc tính này bởi sự chuyển gen theo chiều ngang. Hạn chế duy nhất đối với những kiểu gen này có trong plasmid là chúng không can thiệp vào sự sao chép của chính mình hoặc vào sự tồn tại của vật chủ
Plasmid đề kháng
Trong số những nhóm plasmid phổ biến nhất và được nghiên cứu kĩ nhất là các plasmid R, có khả năng kháng kháng sinh và nhiều chất ức chế sinh trưởng khác. Bản chất gây nhiễm của plasmid tiếp hợp R cho phép chúng lan rộng nhanh chóng trong quần thể tế bào gây ra một vấn nạn lớn trong y học lâm sàng là sự xuất hiện nhanh các vi khuẩn đề kháng thuốc. Một plasmid R có thể mang nhiều gen đề kháng. Chẳng hạn, plasmid R100 có 94,3 kbp mang những gen mã hóa cho sự kháng sulfonamid, streptomycin và spectinomycin, fusidic axit, chloramphenicol, tetracylin và có thể một số gen kháng thủy ngân (mercury). Plasmid R100 có thể được chuyển giữa các vi khuẩn đường ruột thuộc chi (Genra) Escherichia, Klebsiella, Proteus, Salmonella và Shigella, có thể chuyển vào vi khuẩn
Gram âm Pseudomonas. Những plasmid R khác có gen kháng kháng sinh cũng được ghi nhận
DẠYKÈMQUYNHƠN
61
Hình 34: Plasmid R100: RTF là vùng các gen tra chuyển gen; r-determinant là vùng các gen đề kháng (mer - thủy ngân, sul - sulfamid, str - streptomycin, cmlchloramphenicol, tet – tetracyclin).

Plasmid mã hóa chất độc và những độc tính khác Ở một số vi khuẩn gây bệnh, một số tính chất này được mang trên plasmid. Thí dụ, dòng E. coli gây bệnh đường ruột có tính chất này bởi khả năng sinh sản thành tập đoàn trong ruột non và sản xuất một chất độc gây các triệu chứng của bệnh tiêu chảy. Sự hình thành tập đoàn đòi hỏi sự hiện diện của một protein bề mặt tế bào gọi là yếu tố kháng nguyên tạo quần thể (yếu tố kháng nguyên hình thành tập đoàn), được mã hóa bởi một plasmid. Protein này giúp tế bào có khả năng gắn với tế bào biểu mô của ruột. Ít nhất hai chất độc ở E. coli gây bệnh đường ruột được mã hóa bởi một plasmid: hemolysin làm tan tế bào hồng cầu và enterotoxin gây tiết quá nhiều nước và muối vào ruột và do vậy là chất độc gây tiêu chảy.
Bacteriocin
Nhiều vi khuẩn sản xuất protein ức chế hoặc giết chết tế bào các loài họ hàng gần, thậm chí ngay cả những dòng khác nhau của cùng một loài. Những tác nhân này, được gọi là bacteriocin để phân biệt với chất kháng sinh, có phổ tác động hẹp hơn kháng sinh. Các gen mã hóa bacteriocin và những protein chế biến (processing) và vận chuyển chúng (tạo tính miễn dịch cho sinh vật sản sinh ra nó) thường nằm trên plasmid hay transposon. Bacteriocin được đặt tên theo loài tạo ra nó như ở E. coli có colicin, mã hóa bởi Colplasmid; Bacillus subtilis tạo ra subtilisin, .... Plasmid Col của E. coli mã hóa nhiều colicin khác nhau. Colicin được giải phóng từ một tế bào gắn với những thụ thể (receptors) đặc hiệu trên màng tế bào dễ cảm nhiễm (susceptible). Colicin giết tế bào bằng cách ngăn cản chức năng quan trọng nào đó của tế bào.
DẠYKÈMQUYNHƠN
62
OFFICIAL
Bacteriocin hoặc tác nhân tương tự bacteriocin của vi khuẩn Gram dương thì hơi khác colicin những cũng thường được mã hóa bởi plasmid, một số thậm chí còn có giá trị thương mại. Chẳng hạn, vi khuẩn lactic tạo ra bacteriocin Nisin A ức chế mạnh sự tăng trưởng của một loạt vi khuẩn Gr+ và được dùng làm chất bảo quản trong công nghệ thực phẩm.
2.6.9. Sự chuyển vị (Transposition)
Các phần tử chuyển vị (transposable elements) hay phần tử di động (mobile elements) là những trình tự DNA có khả năng di chuyển từ vị trí này đến vị trí khác (mục tiêu) của bộ gen (cùng bộ gen hay khác). Sự di chuyển DNA này được gọi là transposition (sự chuyển vị).
OFFICIAL
Tái tổ hợp (Recombination) trong chuyển vị (transposition) là sự kết nối (junction) giữa các đầu mút của phần tử chuyển vị với các đầu mút bị cắt hở của DNA mục tiêu (target site). Khác với tái tổ hợp tương đồng (homologous recombination), transposition không đòi hỏi sự tương đồng (homologous sequence) giữa các phần tử di động và DNA mục tiêu, và nó độc lập với chức năng được mã hóa bởi recA, vì nó sử dụng enzym đặc hiệu là Transposaz. Đây là hiện tượng rất phổ biến trong thiên nhiên, các transposon được tìm thấy ở vi khuẩn, nấm, thực vật và động vật
Prokaryota Eukaryota
– Trình tự xen đoạn: IS – Transposon: Tn như Tn3, Tn5, Tn10, – Virut: Mu
– Retrotransposon: Nấm men (Yeast): Ty Ruồi giấm: copia, P – Transposon (DNA): Ngô: hệ thống Ac-Ds – SINE: ở người (họ Alu) – Retrovirut: Rous sarcoma, HIV
Bảng 6: Các phần tử chuyển vị có ở Prokaryotae và Eukaryota
Chúng có chức năng như các vector quan trọng thực hiện biến đổi di truyền. Các xen đoạn, mất đoạn và cấu trúc lại bộ gen thường kèm theo sự di chuyển của các transposon. Sự di chuyển này làm sai hỏng chức năng bình thường của gen. Chúng hoạt hóa hay làm bất hoạt các gen bằng cách xen đoạn vào kề bên hay vào giữa đoạn gen. Các transposon IS, là các phần tử lặp đoạn (repetitive elements), còn tạo các vùng tương đồng rải trong bộ gen, nhờ đó các hệ thống tái tổ hợp tương đồng có thể tác động. Sự chuyển vị (transposition) gồm các kiểu chính:
DẠYKÈMQUYNHƠN
63
IS: trình tự xen đoạn (insertion sequence) là các transposon ngắn (khoảng 7801500 bp), cấu trúc đơn giản và chỉ mã hoá các chức năng cần thiết cho transposition
Transposon (kí hiệu Tn): Các phần tử di động dài (khoảng 5000 bp) có chứa một hoặc vài gen, gây ra đột biến, làm trung gian cho sự sắp xếp lại bộ gen, Nó thực hiện:
+ Transposition không sao chép (nonreplicative): Phần tử chuyển vị được cắt khỏi DNA cho (donor) và được gắn vào phân tử DNA mục tiêu. Thuộc loại này có Tn10, Tn5, Tn7 (trong đó Tn5, Tn10 xác định khả năng kháng kanamycin và tetracycline tương ứng. Các chuyển vị phức tạp có thể phát triển bằng cách chuyển vị các trình tự chèn tương đồng sang các vị trí lân cận trong phân tử DNA)
OFFICIAL
+ Transposition sao chép (replicative): DNA được nhân đôi và bản sao được xen vào vị trí mới tạo cointergrat (cộng gắn) gồm có thực khuẩn Mu và các phage ôn hoà có liên quan, Tn3 (Transposon kháng ampicillin), Tn1000 (transposon gammadelta) tìm thấy trong plasmid F Nhóm Transposon Tn917 được phát hiện ở Gram dương bao gồm chuyển vị liên hoàn, khác hoàn toàn với các chuyển vị được mô tả ở trên. Transposon liên hợp không tạo ra sự sao chép của trình tự đích mà nó chèn vào, và ở vi khuẩn Gram dương, dòng vật chủ mang transposon có thể hoạt động như một người cho kết hợp. Vi khuẩn tiếp nhận không cần thiết phải có quan hệ mật thiết với vi khuẩn cho. Transposon được cắt ra khỏi nhiễm sắc thể của người cho và được truyền bằng cách tiếp hợp cho người nhận, nơi nó tích hợp ngẫu nhiên vào nhiễm sắc thể. Tn917 mã hóa kháng tetracycline, nhưng các chuyển vị liên hợp lớn hơn khác có thể mã hóa kháng kháng sinh bổ sung. Các chuyển vị liên hợp dường như là nguyên nhân chính của sự lan truyền tình trạng kháng thuốc kháng sinh ở vi khuẩn Gram dương
Retrotransposition: Sự di chuyển qua trung gian RNA, nhờ reverse transcriptaz tạo thành cDNA, và sự xen đoạn cDNA vào vị trí mới.
2.6.10. Các trình tự xen đoạn IS
Các transposon đơn giản nhất là các trình tự xen đoạn (insertion sequence) và được kí hiệu bởi tiếp đầu ngữ IS kèm số thứ tự như IS4. Các phần tử IS là các cấu phần bình thường của DNA vi khuẩn và plasmid. Dòng E. coli chuẩn thường chứa vài bản sao (<10) của bất kì một trong các IS chung thường gặp.
Các IS là những đơn vị tự trị, mỗi một trong chúng mã hóa cho chỉ một protein cần thiết cho sự chuyển vị bản thân chúng. Trình tự của mỗi loại IS có khác nhau, nhưng trong tổ chức cấu tạo có nhiều tính chất chung. Ở giữa có gen transposaz tnp, hai đầu có lặp đoạn đảo ngược (IR – Inverted repeats). Sự xen đoạn của IS ở tiêu điểm (target) được minh họa trên hình 35.
DẠYKÈMQUYNHƠN
64
Các đầu mút của transposon có trình tự lặp lại đảo ngược (inverted repeat - IR). Trong ví dụ này, tiêu điểm có 5 bp. Các đầu mút của transposon gồm các lặp đoạn đảo ngược 9 bp được đánh số từ 1 đến 9.
DNA mục tiêu

Hình 35: Cấu trúc IS và sự chèn vào DNA mục tiêu Ở hai đầu của IS luôn có hai trình tự lặp đoạn trực tiếp (direct repeat) ngắn. Các trình tự này dao động tùy transposon, nhưng cố định đối với mỗi loại IS. Chiều dài của phần lớn lặp đoạn trực tiếp là 9, chúng xác định các đầu mút của transposon.
OFFICIAL
2.6.11. Transposon không sao chép và sao chép
Sự chuyển vị DNA theo 2 kiểu khác nhau (sao chép và không sao chép hay bảo tồn (conservative)) và có những tính chất chung.
Hình 36: Sơ đồ về transposition sao chép và không sao chép DNA cho Cả hai đầu của phân tử mang gần như một trình tự có định hướng đảo ngược nhau.
Các transposon mã hóa ít nhất một protein là transposaz. Transposaz gắn đặc hiệu và cắt các trình tự ở cuối để thực hiện chuyển vị.
Các transposon tạo bản sao ngắn (12bp) của DNA ở điểm mục tiêu trong transposition. Chiều dài của trình tự này đặc trưng và không đổi đối với một phần tử nhất định và được tạo ra nhờ sự cắt so le (staggered cleavage) của DNA mục tiêu nhờ transposaz.

DẠYKÈMQUYNHƠN
65
I R I R
Cơ chế transposition được nghiên cứu chi tiết ở phage Mu và có thể tóm tắt như sau:
- Nhận biết và bắt cặp 2 đầu mút của transposon nhờ transposaz để hình thành cấu trúc chuyên biệt protein - DNA. Sự hình thành phức hợp được kích thích bởi các protein HU và IHF là các nhân tố tham gia tái tổ hợp điểm chuyên biệt Mu transposaz, giống như Int protein, có 2 vùng gắn độc lập.
- Cắt khấc (nicking) do transposaz tạo ra 3’-OH ở mỗi đầu của Mu.
- Cắt tiêu điểm nhờ transposaz tạo đầu mút so le 5’ - P dài 5 bp.
- Nối đầu 5’ - P của tiêu điểm với 3’-OH của transposon tạo cấu trúc trung gian chuyển mạch (strand - transfer intermediate).
2.6.12. Sự chuyển vị ngược (Retrotransposition)
OFFICIAL
Nhóm các transposon, được phát hiện ở nấm men (Ty) và Drosophila (copia) và có liên quan đến retrovirut, di chuyển đến vị trí mới qua trung gian RNA Phương thức phiên mã ngược của các phần tử di động tương tự như của retrovirut. Có sự tương tự về cấu trúc giữa retrovirut và các retrotransposon ở nấm men (Ty) và Drosophila (copia). Sự chuyển vị ngược tạo bản sao của phần tử ở vị trí mới, trong khi phân tử cho ban đầu vẫn giữ nguyên cấu trúc không biến đổi. Do vậy, retrotransposition tạo nên một ít đứt đoạn và các tái cấu trúc (rearrangement) của bộ gen tế bào chủ. Những biến đổi của bộ gen liên quan với retrotransposition sẽ dẫn đến việc làm ngừng hay hoạt hóa các gen, mà một số có thể gây ung thư.
Các transposon đã góp phần vào sự tiến hóa của plasmid, và vài chứng cứ cho thấy các plasmid R có được tính đề kháng kháng sinh thông qua các transposon.
Integron là các transposon có thể thu nhận và biểu hiện các gen từ nhiều nguồn khác nhau. Tuy nhiên, khác với các transposon được chèn vào một cách ngẫu nhiên, các integron chèn vào có tính chọn lọc cao (high selective) trong các điểm xen đoạn (insertion site) của chúng, thường thì đựơc chèn vào trong plasmid.
Integron chứa gen mã hóa cho protein được gọi là integraz, cần thiết cho sự tái tổ hợp ở điểm chuyên biệt (site-specific recombination). Bộ gen của phage λ (lambda) chèn vào Nhiễm sắc thể của E. coli ở một vị trí đặc biệt nhờ họat tính của enzym integraz λ. Integron cũng chứa trình tự DNA đặc biệt cho phép integraz chèn các nhóm gen gọi là cassette vào Nhiễm sắc thể, mà trên đó có promoter cho phép các gen cassette mới được biểu hiện. 2.6.13. Tái bản DNA (DNA replication) a. Các nguyên tắc và đặc điểm chung của tái bản DNA - Tái bản theo kiểu bán bảo toàn (semi-conservative).
DẠYKÈMQUYNHƠN
66
- Tái bản bắt đầu tại một hoặc nhiều khởi điểm (Ori). Từ khởi điểm, DNA mở xoắn tạo thành hai chạc tái bản (replication fork). Cấu trúc như vậy gọi là đơn vị tái bản (replicon). DNA E. coli trong quá trình tái bản như vậy có cấu trúc giống chữ cái theta Hy Lạp (θ) nên gọi là tái bản theta. Đối với các DNA mạch vòng, mỗi phân tử chỉ có một Ori; trong khi đó mỗi DNA nhiễm sắc thể eukaryote có nhiều Ori.

- Tham gia vào sự tái bản DNA có nhiều protein và enzyme.
- Tại mỗi chạc tái bản, trước tiên xảy ra sự tổng hợp các đoạn mồi RNA (primer) bởi vì các DNA polymerase tự nó không thể bắt đầu tổng hợp mới được.


OFFICIAL
Mặt khác, do hai sợi đơn của mỗi chạc ngược chiều nhau trong khi các DNAvà RNA polymerase chỉ xúc tác theo chiều 3'-5', cho nên sự tái bản DNA trên hai sợi khuôn là không giống nhau: một sợi liên tục gọi là sợi dẫn đầu (leading strand) và một sợi không liên tục gọi là sợi ra chậm (lagging strand). Kiểu tái bản như thế gọi là tái bản nửa gián đoạn (semi-discontinuous), được R. Okazaki phát hiện đầu tiên năm 1969. Một khởi điểm và hai chạc tái bản sinh trưởng đồng thời theo hai hướng đối lập nhau, mỗi chạc gồm một sợi dẫn đầu và một sợi ra chậm.
sợi dẫn đầu (được tổng hợp liên tục) chạc tái bản chạc tái bản 5’ 3’ 5’ 3’ 3’ 5’ 3’ 5’ 5’ 3’ 3’ 5’ sợi ra chậm (được tổng hợp không liên tục)
Hình 37: Tái bản AND ở E. coli Cơ chế tái bản DNA (E. coli) Đối với nhiễm sắc thể E. coli, sự tái bản bắt đầu tại một khởi điểm đặc thù gọi là Ori. Quá trình diễn biến ở khởi điểm E. coli cho đến lúc hình thành hai chạc có thể tóm tắt như sau: (1) Các protein bám khởi điểm dnaA bám Ori tạo ra cấu trúc nucleoprotein chuyên hoá của khởi điểm; (2) Cấu trúc này mở xoắn vùng DNA giàu AT để hình thành "phức hợp mở"; và (3) Hai phân tử helicase dnaB chui vào phức hợp mở làm mở xoắn khởi điểm theo cả hai hướng, tạo thành hai chạc tái bản (replication fork). Khi cả hai sợi đơn của mỗi chạc được tách ra thì các protein SSB bám vào
DẠYKÈMQUYNHƠN
67
Giai đoạn khởi đầu
Khởi đầu trong tái bản DNA ở E. coli là sự tổng hợp một đoạn mồi ngắn khoảng 10-12 nucleotide bởi primase (xét chung ở các sinh vật là ~ 5 base). Cả ba loại protein dnaB, dnaC và dnaG hợp thành một phức hợp có tên là primasome (hoặc primosome: thể mở đầu)
Giai đoạn kéo dài (elongation)
Một khi primasome tổng hợp xong một mồi, sự kéo dài chuỗi DNA được bắt đầu bằng một phức hợp giữa primasome và DNA polymerase III hoàn chỉnh, gọi là replisome (thể tái bản). Sự tái bản DNA trên mỗi chạc xảy ra theo kiểu nửa gián đoạn (semi-discontinuous)
Trên sợi khuôn dẫn đầu (3'→5'): Sau khi primase (primasome) tổng hợp xong đoạn mồi RNA với đầu 3'-OH tự do, enzyme hoàn chỉnh DNA polymerase III (hay replisome) bắt đầu kéo dài chuỗi DNA mới sinh trưởng theo chiều 5'→3' một cách liên tục.

OFFICIAL
Trên sợi khuôn ra chậm (5'→3'): Sự kéo dài diễn ra không liên tục dưới dạng các đoạn Okazaki. Kích thước trung bình mỗi đoạn Okazaki ở E. coli là 1.000 - 2.000 nucleotide. Quá trình này đòi hỏi sự "mồi hóa" lặp lại, với sự tham gia lần lượt của bốn enzyme sau: (i) primase tổng hợp một đoạn mồi RNA; (ii) DNA polymerase III kéo dài đoạn Okazaki; (iii) DNA polymerase I vừa cắt bỏ đoạn mồi vừa lấp khoảng trống bằng cách kéo dài dần đoạn Okazaki theo sau; (iv) DNA ligase hàn liền khe hở giữa hai đoạn Okazaki bằng một liên kết phosphodiester.
Hình 38: Cơ chế tái bản nửa gián đoạn trên một chạc tái bản. Giai đọan kết thúc (termination)
Do cấu trúc nhiễm sắc thể ở hai nhóm prokaryote và eukaryote là hoàn toàn khác nhau, nên cơ chế kết thúc tái bản của chúng cũng khác nhau.
Cả hai chạc tái bản của DNA E. coli được bắt đầu từ một khởi điểm (Ori), và di chuyển hầu như cùng tốc độ theo hai hướng đối lập nhau xung quanh nhiễm sắc thể mạch vòng cho tới khi chúng gặp nhau tại một điểm kết thúc chung đối diện với ori.
DẠYKÈMQUYNHƠN
68
S
DNA
Đoạ
RNA
ợi mới DNA polymerase Sợi khuôn dẫn đầu Sợi khuôn ra chậm Helicase DNA polymerase Primase
cha mẹ
n Okazaki
primer Protein bám sợi đơn (SSB)
RTP của E. coli có TLPT ~36kD, được mã hóa bởi gene tus (ter) và trong mỗi tế bào có ~80 bản sao của protein này được duy trì hầu như ổn định trong suốt chu kỳ tế bào. Trình tự điều hoà của vùng kết thúc tái bản ở E. coli (R6K), theo Bastia và cs (1997), như sau: 5'NN(A/T)(A/T)(A/T)G(A/T)(A/G)TGTTGTAACTA(A/C)NN3'
2.6.14. Phiên mã (Transcription) ở prokaryote
a. Các nguyên tắc và đặc điểm chung của phiên mã
Phiên mã (transcription) là quá trình tổng hợp các RNA khác nhau từ thông tin di truyền chứa đựng trong DNA. Trừ các gene mã hóa protein trong các operon ở vi khuẩn, nói chung, các RNA mới được tổng hợp chỉ là các bản sao sơ cấp (primary transcript) gọi là các pre-RNA. Các pre-RNA này phải trải qua một quá trình sửa đổi để trở thành các RNA trưởng thành (mature) trước khi tham gia vào quá trình sinh tổng hợp protein của tế bào.
OFFICIAL
Quá trình phiên mã DNA các đặc điểm chung sau đây:
Hình 39: Sự tổng hợp RNA trên một sợi khuôn của gene (DNA).

- Diễn ra dưới tác dụng của các enzyme RNA polymerase.
- Chỉ một sợi đơn được dùng làm khuôn cho tổng hợp RNA, gọi là sợi khuôn, sợi mã hoá hay sợi có nghĩa (template/ coding / sense strand); còn sợi bổ sung được gọi là sợi đối khuôn, sợi không mã hoá hay sợi đối nghĩa (antitemplate/ non-coding / antisense strand).
- Phản ứng tổng hợp RNA diễn ra theo nguyên tắc bổ sung và được kéo dài theo chiều 5'→3', ngược với chiều của sợi khuôn.
- Nguyên liệu cho tổng hợp gồm: ATP, UTP, GTP và CTP.
- Sản phẩm của phiên mã là các RNA sợi đơn.
- Khởi đầu và kết thúc phiên mã phụ thuộc vào các tín hiệu điều hoà là các trình tự DNA đặc thù nằm trước gen (vùng khởi động) và sau gene.
Ở các prokaryote, RNA polymerase hoàn chỉnh (holoenzyme) là một phức hợp gồm nhân tố sigma và lõi enzyme. Nhân tố sigma giúp RNA polymerase nhận biết và bám vào promoter để có thể bắt đầu phiên mã tại vị trí chính xác, và lõi enzyme đóng vai trò xúc tác tổng hợp RNA.
Vùng khởi động (promoter) nói chung nằm kề trước gene và có chứa các trình tự đặc thù cho phép RNA polymerase nhận biết và bám vào. Trình tự quan trọng nhất
DẠYKÈMQUYNHƠN
69
của promoter là hộp TATA hay hộp Pribnow (Pribnow box) ở vị trí "-10". Ngoài ra, còn có trình tự TTGACA ở vị trí ''-35'', gọi là đoạn nhận biết (recognition sequence). Các vùng này được bảo tồn cao.
Các giai đoạn của quá trình phiên mã ở prokaryote
- Khởi đầu: RNA polymerase holoenzyme nhận biết và bám vào promoter, tháo xoắn một đoạn khoảng 12 cặp base. Sau khi tổng hợp ribonucleotide đầu tiên (Appp hoặc Gppp), nhân tố sigma tách ra để đi vào một chu kỳ phiên mã khác, gọi là chu kỳ sigma (sigma cycle).
- Kéo dài: Enzyme lõi tổng hợp sợi RNA dọc theo sợi khuôn.
- Kết thúc: Khi phiên mã xong hai vùng giàu GC và AT nằm sau gene, ở vùng đuôi của sợi RNA hình thành cấu trúc ''kẹp cài tóc'' (hairpin loop) làm dừng sự phiên mã của lõi RNA polymerase. Cuối cùng, dưới tác dụng của nhân tố rho, sợi RNA và enzyme lõi được giải phóng khỏi DNA khuôn.
OFFICIAL
2.6.15. Dịch mã tổng hợp protein
Dịch mã (translation) là quá trình sinh tổng hợp protein diễn ra trong tế bào chất, được chia làm hai giai đoạn sau đây: Hoạt hoá amino acid Đây là quá trình tạo nguồn các aminoacyl-tRNA cho dịch mã. Mỗi amino acid được đính vào tRNA thích hợp thông qua hai phản ứng nhờ enzyme aminoacyl-tRNA synthetase đặc thù cùng với ATP và Mg2+. R−CH(NH2)−COOH + ATP → R−CH(NH2)−CO~AMP + PP R−CH(NH2)−CO~AMP + tRNA → R−CH(NH2)−CO~tRNA + AMP
Tổng hợp polypeptide Mở đầu (initiation): Quá trình dịch mã bắt đầu khi một tiểu đơn vị ribosome bé bám vào mRNA tại vị trí của codon khởi đầu AUG. Lúc này một phân tử tRNA khởi đầu đặc thù mang methionine (ở vi khuẩn là formyl-Met) đi vào và khớp anticodon của nó với codon mở đầu của mRNA. Kế đó, tiểu đơn vị ribosome lớn bám vào tiểu đơn vị bé tạo ra một ribosome hoạt động hoàn chỉnh. Lúc này Met-tRNA ở vị trí P và vị trí A để trống; một tRNA thứ hai (ví dụ, tRNAVal) đi vào vị trí A và khớp với codon thứ hai Kéo dài (elongation): Quá trình kéo dài bắt đầu sau khi liên kết peptide đầu tiên được hình thành. Phản ứng này được xúc tác bởi enzyme peptidyl transferase, và kết quả là tạo ra một peptidyl-tRNA ở vị trí
DẠYKÈMQUYNHƠN
70
Hình 40: Quá trình tổng hợp chuỗi polypeptide.

Sau đó, ribosome lập tức chuyển dịch sang một codon mới dọc theo mRNA theo chiều 5'→3' (C). Phản ứng này đẩy phân tử tRNA tự do vốn ở vị trí P ra ngoài; lúc này peptidyl-tRNA nằm ở vị trí P và vị trí A lại để trống. Một chu kỳ dịch mã mới lại bắt đầu, một aminoacyl-tRNA thứ ba đi vào và khớp anticodon của nó với codon đang để trống ở vị trí A, một liên kết peptide thứ hai được hình thành, và ribosome lại dịch chuyển sang codon kế tiếp. Quá trình nói trên cứ diễn ra một cách tuần tự dọc theo mRNA làm cho chuỗi polypeptide dài dần ra cho đến dịch mã xong codon có nghĩa cuối cùng.
Kết thúc (termination): Quá trình tổng hợp polypeptide sẽ dừng lại khi codon kết thúc của mRNA đối diện với vị trí A. Lúc này nhân tố giải phóng RF (release factor) đi vào (D); chuỗi polypeptide được tách ra và phóng thích cùng với hai tiểu đơn vị ribosome cũng như tRNA ra khỏi mRNA.
3. Di truyền học vi nấm và vi tảo
Các vi sinh vật nhân thực Eukaryota như vi nấm, vi tảo có chu trình sống đa dạng và ở nhiều điểm giống với các Eukaryota bậc cao. Cấu tạo đơn bào giúp cho việc sử dụng có hiệu quả các phương pháp phân tích di truyền ở vi sinh vật. Phân tích bộ bốn giúp nghiên cứu được chi tiết từng sản phẩm của giảm phân. Các nghiên cứu di truyền vi nấm tập trung ở 4 vấn đề căn bản: tính không phối hợp, phân tích bộ bốn, tái tổ hợp nguyên phân và sự đơn bội hóa.
DẠYKÈMQUYNHƠN
71
OFFICIAL
A
B Liên kết peptid C D
Tách và giải phóng
Nhân
tố RF Chuỗi gồm 8 amino acid
Neurospora crassa và Saccharomyces cerevisiae là những đối tượng nghiên cứu quan trọng của di truyền. Ở vi tảo Chlamydomonas reinhardii được nghiên cứu chi tiết hơn cả trong số các vi tảo. Các nghiên cứu ở vi tảo làm sáng tỏ nhiều vấn đề của di truyền quang hợp và sự xác định các sắc tố.


3.1. Nấm men Saccharomyces cerevisiae Nấm men Saccharomyces cerevisiae là một loài thuộc lớp Nấm Túi (Ascomycetes), còn gọi là “men bánh mì” (baker yeast) hay “men rượu”. Đó là loài nấm men chủ yếu được dùng trong các quá trình lên men rượu. Vì là Eukaryota đơn bào (kích thước khoảng 5 – 10µm, được biết rất chi tiết về di truyền học và sinh lí học, cho nên là đối tượng mô hình nghiên cứu di truyền các sinh vật nhân thực.
OFFICIAL
Hình 41: Nấm men S. cerevisiae dưới kính hiển vi điện tử và kính hiển vi quanghọc
a. Các đặc tính sinh học
S. Cerevisiae có 2 tính chất: là đơn bào nên có thể tiến hành thí nghiệm như vi khuẩn, đồng thời có những đặc tính chủ yếu điển hình của Eukaryota và có ty thể với bộ gen DNA nhỏ. Giống với vi khuẩn, nó có thể nuôi trên môi trường dịch thể hay đặc và tạo khuẩn lạc trên môi trường thạch. Có thể nuôi tế bào nấm men quy mô lớn trong các nồi lên men và dễ dàng thu nhận sinh khối tế bào. Nấm men có 2 dạng tế bào đơn bội (n) là a và α có thể tồn tại độc lập nhờ sinh sản vô tính qua nguyên phân (mitosis). Khi 2 dạng a và α gặp nhau bắt cặp, rồi phối hợp tế bào và hợp nhân tạo 1 tế bào lưỡng bội (2n). Tế bào lưỡng bội có thể sinh sản vô tính vô hạng và đây là dạng thường sử dụng trong sản xuất. Trong những điều kiện nhất định, tế bào 2n sinh sản hữu tính qua giảm phân tạo nang có 4 bào tử (2 a và 2 α), mà sự kết hợp a và α tạo tế bào 2n, lặp lai chu trình.

DẠYKÈMQUYNHƠN
72
Hình 42: Chu trình sinh sản của nấm men S. cerevisiae
b. Các dữ liệu di truyền học của S. cerevisiae:
Kích thước bộ gen (Genome size): 12 Mb
Nhiễm sắc thể: n = 16
Số lượng gen: 6.000
Phần trăm gen tương đồng với người: 25%
Kích thước trung bình của gen: 1,5 kb, 0,03 intron/gen
Các transposon: một tỷ lệ nhỏ của DNA
Kết thúc giải ký tự chuỗi: 1996 c. Các kĩ thuật biến đổi di truyền trên nấm men: Gây đột biến (Mutagensis):
OFFICIAL
Hóa chất và chiếu xạ: đột biến xoma ngẫu nhiên.
Dùng transposon: xen đoạn (Insertions) xoma ngẫu nhiên.
Chuyển gen (Transgensis):
Plasmid tích hợp (integrative): xen đoạn (Inserts) nhờ tái tổ hợp tương đồng (homologous recombination).
Plasmid sao chép (replicative): Có thể sao chép tự lập (autonomously) (Ori sao chép của plasmid 2 hay ARS).
Nhiễm sắc thể nhân tạo của nấm men: sao chép và phân ly như một nhiễm sắc thể
Vector con thoi (Shuttle vector): Có thể sao chép trong tế bào nấm men hay E. coli.
Làm im lặng gen mục tiêu (Targeted gen knockout): Thay thế gen (Gen replacement): tái tổ hợp tương đồng thay alen hoang dại bằng alen không (null alen).
S. cerevisiae có nhiễm sắc thể nhân tạo (Yeast artificial chromoxom - YAC) có trình tự sao chép ARS (Autonomously replicative sequence), tâm động (centromere) và 2 telomere (trình tự đầu mút nhiễm sắc thể). YAC tồn tại độc lập trong tế bào nấm men như một nhiễm sắc thể và các gen được chèn vào nó được di truyền như nhiễm sắc thể Mendel. YAC có khả năng mang đoạn gDNA ngoại lai dài 1 – 2 Mb, nên thuận tiện cho tạo dòng và giải ký tự chuỗi (sequencing) những bộ gen lớn như bộ gen người. Nấm men S. cerevisiae được sử dụng rộng rãi làm tế bào chủ trong KTDT. Ngoài ra, một số protein tái tổ hợp (gốc động vật) như interferon khi biểu hiện trong tế bào Prokaryotae như E. coli thì không có hoạt tính do thiếu biến đổi sau dịch mã, nhưng khi cho biểu hiện trong tế bào nấm men thì sản phẩm có hoạt tính.
DẠYKÈMQUYNHƠN
73
Vai trò chủ yếu của S. cerevisiae trong các nghiên cứu:
- Chu trình tế bào (Cell cycle): Sự xác định các gen kiểm soát phân bào nhờ các đột biến nhạy cảm nhiệt (temperature-sensible mutants (cdc mutants)) dẫn đến mô hình rất tốt cho nghiên cứu sự phân bào.


- Tương tác gen (Gen interaction): nghiên cứu sự ức chế gen (suppression). Hệ thống plasmid lai kép (two-hybrid plasmid system) giúp tìm các tương tác giữa các protein ở nấm men đã dẫn đến các bản đồ tương tác phức tạp, mà là khởi đầu cho sinh học các hệ thống (systems biology).
- Di truyền học ty thể: nhờ các đột biến “petite” mất khả năng hô hấp mà phát hiện các gen của ty thể. Nhờ chúng và các đột biến khác của ty thể mà phân tích chi tiết cấu trúc và chức năng bộ gen ty thể.
OFFICIAL
- Di truyền học kiểu bắt cặp (Gentics of mating typ): Các alen MAT ở nấm men là các gen kiểu bắt cặp đầu tiên được xác định các đặc tính ở mức phân tử. Đóng góp khác: Sự di truyền của khóa dóng mở (switching) giữa sự tăng trưởng kiểu nấm men (yeast-like) và sợi (filamentous); di truyền học sự thoái hóa (senescense).
3.2. Nấm sợi Neurospora crassa a. Các đặc tính sinh học Giống với vi khuẩn và nấm men, nấm sợi này có thể nuôi trên môi trường dịch thể hay đặc và tạo khuẩn lạc trên môi trường thạch. Nó thể hiện các tính chất điển hình của Eukaryota giống như nấm men: bộ gen gồm nhiều nhiễm sắc thể, bào tử túi có trạng thái đơn bội (n) và hợp tử lưỡng bội (2n), sinh sản vô tính qua chu trình nguyên phân (mitotic cycle), sinh sản hữu tính qua giảm phân và có ty thể với bộ gen DNA nhỏ. Nấm thường mọc trên bánh mỳ cũ và có màu vàng tươi.
Hình 43: Nấm sợi Neurospora crassa dưới kính hiển vi quang học
Sợi nấm phân đoạn có chứa nhiều nhân đơn bội. Có hai kiểu giới tính được điều khiển bởi một căp alen A và a. Sinh sản hữu tính chỉ thực hiện khi có sự kết hợp của các tế bào khác alen. Như hình vẽ mô tả khi bào tử đính a rơi trên tiền quả thể dạng chai (protoperithecium). Các cơ quan sinh dục cái hay A rơi lên tiền quả thể a thì sự thụ tinh sẽ được xảy ra. Lúc đầu hai nhân đơn bội A và a tồn tại song song và chia đồng thời. Sau đó xảy ra sự hợp nhân và tiền quả thể dạng chai biến thành quả thể
DẠYKÈMQUYNHƠN
74
dạng chai (perithecium). Mỗi hợp tử lưỡng bội 2n tạo thành một tế bào kéo dài gọi là nang hay túi (ascus) và lập tức chia giảm nhiễm được 4 nhân, mà 4 nhân này lại chia nguyên nhiễm một lần nữa tạo thành 8 nhân của 8 bào tử nang hay bào tử túi (ascospores).
OFFICIAL
Hình 44: Chu trình sống của nấm sợi Neurospora crassa
Một đặc điểm độc đáo của Neurospora crassa là các sản phẩm của giảm phân, 8 nang bào tử xếp thẳng hàng trong nang. Nhờ vậy, qua phân tích bộ bốn (tetrade analysis) nghiên cứu hàng loạt các cơ chế di truyền như trao đổi chéo, gen chuyển biến (conversion), tái cấu trúc nhiễm sắc thể (chromosome rearrangement), sự không chia ly trong giảm phân (meiotic nondisjunction) và sự kiểm soát di truyền đối với giảm phân. Các nhiễm sắc thể tuy nhỏ, nhưng có thể nhìn thấy dễ dàng. N. crassa đạt kỷ lục về tốc độ tăng trưởng trong các loài nấm: mỗi sợi nấm (hypha) mọc dài ra hơn 10 cm/ngày. Sự tăng trưởng nhanh đó kết hợp với chu trình đơn bội và khả năng mọc trên các môi trường nuôi cấy có thành phần xác định làm cho nó thành một đối tượng rất thuận tiện cho nghiên cứu di truyền hóa sinh (biochemical gentics). Trên thực tế, nó nổi tiếng với sự ra đời giả thuyết một gen - một enzyme
Các dữ liệu di truyền học của Neurospora crassa:
Kích thước bộ gen (Genome size): 43 Mb Nhiễm sắc thể: 7 Nhiễm sắc thể thường (n = 7)
Số lượng gen: 10.000 Phần trăm gen tương đồng với người: 6 %
Kích thước trung bình của gen: 1,7 kb, 1, 7 intron/gen
Các transposon: rất hiếm
Kết thúc giải ký tự chuỗi: 2003
Phân tích di truyền Gây đột biến (Mutagensis):
DẠYKÈMQUYNHƠN
75
Hóa chất và chiếu xạ: đột biến xoma ngẫu nhiên.
Dùng transposon: không.
Chuyển gen (Transgensis):
Biến nạp qua trung gian plasmid (Plasmid-mediated transformation): xen đoạn ngẫu nhiên (Random insertion).
Làm im lặng gen mục tiêu (Targeted gen knockout):
RIP: các đột biến GC –> AT trong các đoạn tăng đôi chuyển gen trước khi lai.
Ức chế (Quelling): bất hoạt xoma sau phiên mã các gen được chuyển vào (Xomatic posttranscriptional inactivation of transgens).
OFFICIAL
3.3. Các đặc điểm di truyền vủa vi nấm Chu trình sống của các loài nấm khác nhau rất đa dạng, nhưng có thể xếp vào 5 kiểu căn bản khác nhau như: 1. Sinh sản vô tính; 2. Thể đơn bội; 3. Thể đơn bội với giai đoạn dị nhân; 4. Đơn bội - Lưỡng bội; 5. Lưỡng bội.
Ngay trong các nấm sinh sản hữu tính cũng có sự dao động từ hoàn toàn đơn bội như Neurospora đến hoàn toàn lưỡng bội như ở Saccharomyces cerevisiae
Đối với phần lớn nấm sợi, điểm đặc trưng là nhiều nhân cùng hiện diện trong một tế bào. Các nhân này có thể có kiểu gen khác nhau. Trong trường hợp này được gọi là thể dị nhân (heterokaryon) tương tự dị hợp tử.
Ở các vi sinh vật nói chung, các tính trạng hình thái thường không nhiều, nhưng có sự đa dạng lớn về nhiều loại phản ứng hóa học khác nhau. Sự ra đời của giả thuyết nổi tiếng 1 gen - 1 enzym đã dựa trên các đột biến sinh hóa ở N. crassa. Các môi trường chọn lọc được sử dụng để thu thập các dạng lai hiếm hoi giữa các dòng cha mẹ đơn bội mang các đột biến khuyết dưỡng lặn, khi sai hỏng trong chuỗi phản ứng sinh hóa của chúng bổ sung cho nhau. Ngoài ra tính đề kháng với các tác nhân bất lợi được sử dụng rộng rãi làm tính trạng đánh dấu trong các nghiên cứu di truyền ở nấm. Nói chung, các vi sinh vật nhân thực có ưu thế đặc biệt là sự kết hợp giữa cấu tạo tế bào và chu trình sống như sinh vật bậc cao với cơ thể đơn bào của vi sinh vật. Nếu như trong những năm 70 của thế kỷ trước, các đối tượng căn bản của di truyền học phân tử là phage và vi khuẩn, thì những từ năm 80 cho đến nay các Eukaryota đơn bào đã thay thế dần. Bốn vấn đề căn bản được chú ý trong nghiên cứu di truyền ở nấm là: tính không phối hợp (incompatibility), phân tích bộ bốn (tetrade analysis), tái tổ hợp nguyên phân (mitotic recombination), và sự đơn bội hóa (haploidisation). Nhiều nấm sợi có quả thể nhìn thấy được không phải là vi nấm, nhưng có thể sử dụng các phương pháp dùng cho vi nấm để nghiên cứu .. a. Lập bản đồ di truyền bằng phân tích bộ bốn
DẠYKÈMQUYNHƠN
76
Đối với trường hợp bộ bốn sắp theo thứ tự như ở Neurospora, số phần trăm các nang tái tổ hợp phản ánh khoảng cách giữa gen và tâm động. Trao đổi chéo chỉ liên quan đến hai nhiễm sắc thể, nên chỉ có hai sản phẩm của giảm phân chứa nhiễm sắc thể tái tổ hợp. Do đó để tính phần trăm các nhiễm sắc thể tái tổ hợp, lấy phần trăm mang tái tổ hợp chia đôi. Trường hợp bộ bốn không theo thứ tự như ở nấm men thì việc tính tần số tái tổ hợp khá phức tạp
OFFICIAL
Hình 45: Các kiểu bộ bốn khác nhau: – Kiểu PD parental dityp (không trao đổi chéo) – Kiểu RD recombination dityp hay NPD nonparental dityp (có trao đổi chéo) – Kiểu TT tetratyp (có trao đổi chéo).
b. Hiện tượng chuyển biến (conversion) Chuyển biến (conversion) là hiện tượng lệch khỏi sự phân li bình thường 2: 2 của các bộ bốn, khi có sự di truyền của 1 gen, được Lindegreen phát hiện năm 1949. Ví dụ: Dị hợp tử của nấm men a+/+b tạo các bộ bốn bất thường như: (a +) (a +) (a b) (+ b) và (a +) (+ +) (+ b) (+ b) hoặc (a +) (a b) (+ b) (+ b) và (a +) (a +) (+ +) (+ b). Sự phân li bất thường có thể liên quan đến cả 2 gen như: (a +) (a +) (a +) (+ b) hay (a +) (+ b) (+ b) (+ b). Các nghiên cứu tiếp theo cho thấy chuyển biến (conversion) là hiện tượng bình thường ở các gen khác nhau của nấm men với tần số 1%. Hiện tượng này cũng được

DẠYKÈMQUYNHƠN
77
mô tả ở các loài nấm khác như Neurospora crassa, Sordaria fimicola và nó có ý nghĩa quan trọng trong giải thích cơ chế tái tổ hợp.
OFFICIAL
Hình 46: Trao đổi chéo trong nguyên phân (Mitotic crossing-over) ở đoạn a-b.
a) Trong tứ dị hợp tử theo các gen liên kết, khi alen lặn c (cần được xác định vị trí) nằm trên đoạn tương đồng được đánh dấu.
b) Trong đoạn tương đồng không đánh dấu, trao đổi chéo ở đoạn giữa gen và tâm động đưa đến sự đồng hợp tử của các gen xa điểm trao đổi ở một nửa số nhân của tế bào (thế hệ con của nhân tái tổ hợp). Nhờ đó, có thể sử dụng trao đổi chéo nguyên phân để xác định vị trí gen ở một vai của nhiễm sắc thể so với tâm động.
3.4. Vi tảo

Các tảo đơn bào (Microalgae) cũng được dùng làm đối tượng nghiên cứu của Di truyền học, đặc biệt là di truyền quang hợp và di truyền của bào quan lục lạp. So với nấm, các vi tảo và nói chung là tất cả thực vật, các đột biến khuyết dưỡng ở tảo lục đơn bào chỉ hạn chế trong một phạm vi hẹp như mất khả năng tổng hợp arginin (arg–) và một số vitamin
Loài vi tảo được sử dụng sớm nhất và nghiên cứu di truyền chi tiết hơn cả là Chlamydomonas reinhardii nó có chu trình sinh sản hữu tính. Ưu thế của đối tượng này là có thể tiến hành lai và phân tích bộ bốn không xếp theo thứ tự.
DẠYKÈMQUYNHƠN
78
Hình 47: Cấu trúc và hình thái Chlamydomonas


a. Đặc điểm sinh học
Vi tảo Chl. reihardii có thể nuôi cấy trong môi trường dinh dưỡng dịch thể hay môi trường thạch đặc như các vi sinh vật khác. Các tế bào mọc thành khuẩn lạc trên môi trường thạch. Vi tảo có thể nuôi ngoài sáng (ánh sáng mặt trời hay đèn huỳnh quang thông dụng) hoặc trong tối (phải bổ sung axetat natri hoặc glucoz) …
Bình thường các tế bào dinh dưỡng tồn tại lâu dài ở trạng thái đơn bội n với 2 kiểu bắt cặp khác nhau mt+ (mating typ) và mt– tương đương với 2 giới tính, mà về hình thái thì rất giống nhau. Các tế bào dinh dưỡng nay có thể tạo nang bào tử kín hay túi bào tử (sporangia) và sinh sản vô tính tạo ra các tế bào con đơn bội.
Khi được kích thích, như nuôi trên môi trường dinh dưỡng thiếu nitơ, các tế bào dinh dưỡng chuyển thành các động bào tử (zoospores) mt+ và mt–. Sự kết hợp và phối hợp 2 loại tế bào khác kiểu bắt cặp mt+ và mt–sẽ tạo ra hợp tử lưỡng bội 2n. Hợp tử này gặp điều kiện thuận lợi sẽ thực hiện giảm phân tạo ra 4 tế bào đơn bội n, mà chúng sinh sản vô tính tạo ra số lượng lớn tế bào dinh dưỡng.
Ở Chl. reinhardii có thể nhận được nhiều đột biến khác nhau, đặc biệt là các đột biến sắc tố khác với màu khuẩn lạc xanh lục của dạng hoang dại như màu cam, vàng, trắng kem, xanh lợt, …thuận lợi cho nghiên cứu di truyền lục lạp và quang hợp
Hình 48: Chu trình sống của vi tảo Chlamydomonas reinhardii Sự di truyền của lục lạp được nghiên cứu chi tiết hơn cả ở vi tảo Chlamydomonas reinhardii. Tế bào của vi tảo này có một lục lạp lớn với đường kính trung bình 5 micrometer chứa 50 đến 80 bản sao của phân tử DNA vòng tròn dài 196 kb.
DẠYKÈMQUYNHƠN
79
OFFICIAL
R oi
Các đột biến có biểu hiện kiểu hình như sau:
- Mất khả năng quang hợp; để mọc được ngoài ánh sáng và trong tối cần bổ sung đường khử là axetat.
- Nhạy cảm với nhiệt độ cao hoặc thấp.
- Tính đề kháng với thuốc kháng sinh hoặc có nhu cầu được cung cấp thuốc kháng sinh.
Tất cả các đột biến trên có sự di truyền theo một cha mẹ (uniparental inheritance), có kiểu bắt cặp mt+ (có thể coi là dòng mẹ). Điều này liên quan đến sự hình thành lục lạp trong hợp tử, bằng cách nào đó chỉ nhận DNA từ lục lạp mt+
Bảng 7: Tỷ trọng của cpDNA ở thế hệ con từ các tổ hợp lai Chlamydomonas
Tổ hợp lai N14 mt+ x N14 mt–N15 mt + x N15mt–N15 mt + x N14mt–N14 mt + x N15mt–
Tỉ trọng của cpDNA của hợp tử (g/cm3 ) 1,69 1,70 1,70 1,69
Trên thực tế, các kết quả này cho thấy cpDNA của cha mẹ mt– bị mất hoặc bị phân hủy như thế nào đó. Sự mất đó kèm theo mất các đột biến (ví dụ: sm) trên cha mẹ mt–.
Các thí nghiệm khác theo nguyên tắc tương tự được tiến hành với việc sử dụng các đoạn RFLP. Mỗi dòng cha mẹ có cpDNA với RFLP khác nhau. Kết quả cũng cho thấy cpDNA ở thế hệ con nhận được từ dòng mt+ .
Như vậy, có thể kết luận rằng cpDNA của Chlamydomonas được truyền thụ từ một dòng cha mẹ (uniparental) và các gen của nó cũng có sự truyền thụ tương tự Lập bản đồ các gen của Chlamydomonas
Trong tổ hợp lai mt+sm –r x mt–sm –s có khoảng 0,1% thế hệ hợp tử con mang cả sm –r và sm–s. Các hợp tử như vậy là hợp tử hai cha mẹ (biparental zygote) và được gọi là cytohet (cytoplasmically heterozygote).






DẠYKÈMQUYNHƠN
80
OFFICIAL
Tần số các cytohet có thể tăng lên 40–100% ở thế hệ hợp tử con nếu mt+ được chiếu tia tử ngoại trước khi lai.
PHẦN B: PHẦN BÀI TẬP
CÂU HỎI VÀ BÀI TẬP CÓ PHÂN TÍCH, HƯỚNG DẪN
Câu 1.
Đánh giá axit amin bằng đồng vị phóng xạ, sau đó theo dõi sự di chuyển của dấu phóng xạ. Lúc đầu người ta thấy dấu phóng xạ xuất hiện trên mạng lưới nội chất hạt, tiếp theo dấu phóng xạ có thể xuất hiện ở những cấu trúc nào của tế bào? Cho biết chức năng của các cấu trúc đó?
Hướng dẫn vận dụng kiến thức: Để trả lời được câu hỏi, yêu cầu học sinh phải nắm chắc kiến thức phần cấu trúc tế bào, sự di chuyển của protein trong tế bào
+ Kiến thức về thành phần hoá học của tế bào (aa là thành phần của protein) vị trí của protein trong tế bào.

OFFICIAL
+ Kiến thức về hoá sinh tế bào: sự vận chuyển protein trong tế bào
Các nhà khoa học sử dụng các chất phóng xạ để đánh dấu các hợp chất hoá học nhất định, tạo ra các chất đánh dấu để có thể theo dõi quá trình trao đổi chất hoặc định vị hợp chất trong cơ thể. Trong ví dụ này, các đồng vị phóng xạ còn được dùng như các chất đánh dấu để theo dõi các nguyên tử trong quá trình trao đổi chất - các quá trình hoá học của cơ thể. Tế bào sử dụng được cả các nguyên tử phóng xạ cũng như các chất đồng vị không phóng xạ của một nguyên tố, nhưng các chất đánh dấu phóng xạ thì dễ dàng bị phát hiện. Các chất đồng vị phóng xạ là phương tiện chẩn đoán quan trọng trong y học. Ví dụ những hội chứng nhất định ở thận có thể được chẩn đoán bằng cách tiêm vào một lượng nhỏ các chất chứa đồng vị phóng xạ vào máu, sau đó đo lượng chất đánh dấu tiết ra ở nước tiểu. Các chất đánh dấu phóng xạ còn được sử dụng phối hợp với các dụng cụ hiện hình tinh vi, như máy nội soi PET- máy có thể theo dõi các quá trình hoá
DẠYKÈMQUYNHƠN
81
học, ví dụ như quá trình diễn ra trong sự sinh trưởng của khối u ung thư, đúng như thực sự nó diễn ra trong cơ thể. Mặc dù các chất đồng vị phóng xạ rất hữu ích để nghiên cứu sinh học và y học, song sự phóng xạ từ các chất đồng vị bị phân huỷ cũng nguy hiểm cho sự sống do nó phá huỷ các phân tử của tế bào. Tính nghiêm trọng của các tổn thương đó phụ thuộc vào loại và lượng phóng xạ mà cơ thể hấp thụ. Một trong số những mối nguy hiểm nghiêm trọng nhất cho môi trường là đồng vị phóng xạ thải ra từ các sự cố hạt nhân. Tuy nhiên, liều lượng của các chất đồng vị dùng trong chẩn đoán y học là tương đối an toàn.
Tất cả các amino axit đều có cấu trúc chung. Các amino axit là các phân tử hữu cơ có cả nhóm cacboxyl và nhóm amin. Ở trung tâm là Cacbon không đối xứng (Cacbon alpha). Bốn đối tác của nó là nhóm amin, nhóm carboxyl, nhóm hydrogen và nhóm biến động kí hiệu là R, còn gọi là chuỗi phụ, khác nhau đối với mỗi amino axit.
OFFICIAL
Hệ thống màng nội bào điều hoà sự vận chuyển protein và thực hiện các chức năng chuyển hoá trong tế bào: Nhiều loại màng khác nhau của tế bào nhân thực là một phần của hệ thống màng nội bào, hệ thống màng thực hiện nhiều nhiệm vụ khác nhau trong tế bào. Các nhiệm vụ đó bao gồm tổng hợp protein và vận chuyển chúng đến màng tế bào và bào quan hoặc ra khỏi tế bào, chuyển hoá và vận động của các lipit, và khử độc các chất độc. Các màng của hệ thống này, hoặc là sự kế tiếp vật lí của nhau một cách trực tiếp, hoặc do tách chuyển một đoạn màng dưới dạng các túi nhỏ Nhiều loại tế bào tiết các protein do các ribosome gắn với các ER tạo ra. Khi protein mới được tổng hợp vào khoang ER, nó cuộn xoắn thành hình dạng tự nhiên. Hầu hết các protein tiết đều là glycoprotein, loại protein có carbonhydrat liên kết cộng hoá trị với chúng. Carbonhydrat gắn với protein trong ER nhờ các phân tử chuyên hoá được tạo ra ở màng ER.
Sau khi các protein tiết được hình thành, màng ER giữ chúng tách biệt khỏi các protein do các ribosone tự do tạo ra và duy trì chúng trong bào tương. Các protein tiết rời khỏi ER trong các túi có màng bao, giống như các bong bóng, nảy ra từ các vùng chuyên hoá (vùng ER chuyển tiếp). Các túi vận chuyển từ vùng này đến vùng khác của tế bào được gọi là túi vận chuyển (túi tải)
- Sau khi rời ER, nhiều túi vận chuyển đi đến bộ máy golgi là trung tam sản xuất, kho chứa hàng, nơi phân loại và vận chuyển. Ở đây, các sản phẩm của ER, như protein, được sửa đổi, dự trữ và sau đó được gửi tới những chỗ khác nhau.
+ Túi vận chuyển của bộ máy Golgi làm nhiệm vụ đưa các phân tử prôtêin đến các bào quan của tế bào hoặc đến màng sinh chất, hoặc đưa ra bên ngoài tế bào.
+ Màng sinh chất có chức năng vận chuyển các chất qua màng, tiếp nhận thông tin từ bên ngoài tế bào, nhận biết giữa các tế bào, tạo hình dạng tế bào.
DẠYKÈMQUYNHƠN
82
Câu 2
Trong tế bào động vật có hai loại bào quan đều thực hiện chức năng khử độc, đó là hai loại bào quan nào? Cơ chế khử độc của hai loại bào quan đó có gì khác nhau?
Hướng dẫn vận dụng kiến thức: phần Sinh học tế bào - cấu trúc và chức năng của các bào quan:
Hóa sinh: cơ chế khử độc của các bào quan:
Lưới nội chất trơn: Chức năng tổng hợp lipit, chuyển hoá các cacbonhydrat, khử độc các thuốc và chất độc. Các enzyme của ER trơn có vai trò quan trọng trong quá trình tổng hợp lipit, bao gồm dầu thực vật, phospholipid và steroid. Cac enzyme khác của ER trơn giúp khử độc thuốc và chất độc, đặc biệt là ở các tế bào gan. Sự khử độc thường là bổ sung nhóm hydroxyl vào các phân tử thuốc làm cho chúng dễ tan hơn và dễ dàng đẩy ra khỏi cơ thể. Thuốc giảm đau và thuốc an thần là những ví dụ về những loại thuốc được trao đổi chất theo cách đó bởi ER trơn ở các tế bào gan. Trong thực tế, các thuốc an thần, alcohol và nhiều loại thuốc khác kích thích sự sinh sôi của ER trơn và các enzyme khử độc liên kết với nó, nhờ vậy làm tăng tốc độ khử độc. Điều đó lại làm tăng sự chịu đựng đối với thuốc, nghĩa là ngày càng cần liều cao hơn mới đạt hiệu quả, ví dụ như để giảm đau. Ngoài ra, vì một số enzyme khử độc có phổ hoạt động tương đối rộng nên sự sinh sôi của ER trơn để đáp ứng với một loại thuốc có thể làm tăng sự chịu đựng với những loại thuốc khác. Ví dụ, sự lạm dụng thuốc an thần có thể làm giảm hiệu qủa của những thuốc kháng sinh nhất định và những thuốc có ích khác.
OFFICIAL
Peroxixom là khoang trao đổi chất chuyên hoá, được bao bọc bởi màng đơn. Peroxixom chứa các enzyme truyền hidro từ các cơ chất khác nhau đến oxygen (O2) tạo ra hydropeoxit (H2O2) như một sản phẩm phụ. Một số peroxixom dùng oxygen để phá huỷ các axit béo thành các phân tử nhỏ hơn để vận chuyển đến ti thể, nơi chúng được dung làm nguyên liệu cho hô hấp tế bào. Các peroxixom trong gan khử độc ancohol và các hợp chất độc hại khác bằng cách truyền hydrogen từ các chất độc đến oxygen. H2O2 do các peroxixom tạo ra rất độc nhưng bào quan này còn chứa enzyme chuyển hoá H2O2 thành nước. Đây là một ví dụ tuyệt vời cho thấy cấu trúc phân chia xoang của tế bào có ý nghĩa sống còn với các chức năng của nó: các enyme sinh ra hydrogen peroxide và các enzyme khử bỏ hợp chất độc hại này được cô lập ở cùng 1 nơi, tách khỏi các thành phần khác có thể bị tổn thương của tế bào.
Loại peroxisome chuyên hoá có tên là glyoxisome được tìm thấy ở các mô dự trữ chất béo của hạt cây. Bào quan này chứa các enzyme khởi đầu của chuyển hoá các acid béo thành đường để các cây non mới mọc dung làm nguồn năng lượng và nguồn Carbon cho đến khi nó có thể tự tạo ra nhờ quang hợp.
Không giống như lysosome, các peroxisome không mọc ra từ hệ thống màng nội bào. Chúng to lên nhờ kết hợp thêm các protein được tạo ra ở dịch bào, lipit được
DẠYKÈMQUYNHƠN
83
tạo ra ở ER và lipit tự do chúng tự tổng hợp. Số lượng các peroxisome có thể tăng lên bằng cách phân đôi khi chúng đạt kích thước nhất định.
Câu 3 (Trích đề thi HSGQG 2015 ngày 1)
Hãy phân biệt quá trình phiên mã và quá trình sao chép trong tế bào chủ của virut chứa hệ gen RNA (+) với virut chứa hệ gen DNA về: nơi phiên mã, enzyme dùng cho phiên mã, nơi sao chép, enzyme dùng cho sao chép. Quá trình phiên mã có trùng với quá trình sao chép không?
Hướng dẫn vận dụng kiến thức:
Kiến thức phần sinh học vi sinh vật: phân biệt virut RNA+ và virut DNA
Kiến thức phần di truyền: phần sao chép DNA và phiên mã
Hướng dẫn trả lời:
Virut RNA (+)
OFFICIAL
Virut DNA
Nơi phiên mã Trong tế bào chất Trong nhân tế bào
Enzyme dùng cho phiên mã
RNA polimeraza phụ thuộc RNA của virut
RNA polimeraza phụ thuộc DNA của tế bào
Nơi sao chép Trong tế bào chất Trong nhân tế bào
Enzyme dùng cho sao chép
RNA polimeraza phụ thuộc RNA của tế bào
DNA polimeraza phụ thuộc DNA của virut
Ở virut chứa hệ gen RNA (+), quá trình phiên mã trùng với quá trình sao chép còn ở virut chứa hệ gen DNA quá trình phiên mã không trùng với quá trình sao chép. Câu 4 Phân lập từ nước dưa chua thu được vi khuẩn Streptococcus faecalis. Nuôi vi khuẩn này trên môi trường cơ sở gồm các chất sau đây: 1,0 gam NH4Cl; 1,0 gam K2HPO4; 0,2 gam MgSO4; 0,1 gam CaCl2; 5,0 gam glucôzơ; các nguyên tố vi lượng Mn, Mg, Cu, Co, Zn (mỗi loại 2.10-5 gam) và thêm nước vừa đủ 1 lít. Thêm vào môi trường cơ sở các hợp chất khác nhau trong các thí nghiệm từ 1 đến 3 dưới đây, sau đó đưa vào tủ ấm 37oC và giữ trong 24 giờ, kết quả thu được như sau: Thí nghiệm 1: môi trường cơ sở + axit folic → không sinh trưởng. Thí nghiệm 2: môi trường cơ sở + pyridoxin → không sinh trưởng.
DẠYKÈMQUYNHƠN
84
Thí nghiệm 3: môi trường cơ sở + axit folic + pyridoxin → có sinh trưởng.
a) Dựa theo nguồn cung cấp năng lượng; nguồn cacbon; chất cho electron; các chất thêm vào môi trường cơ sở thì vi khuẩn Streprococcus faecalis có kiểu dinh dưỡng nào?
b) Các chất thêm vào môi trường cơ sở có vai trò như thế nào đối với vi khuẩn Streprococcus faecalis?
Hướng dẫn vận dụng kiến thức: Vi sinh vật nguyên dưỡng, khuyết dưỡng và các nhân tố sinh trưởng
Hướng dẫn trả lời
a) Vi khuẩn có kiểu dinh dưỡng: Theo nguồn năng lượng: là hóa dưỡng vì vi khuẩn dùng năng lượng được tạo ra từ chuyển hóa glucozơ thành axit lactic
OFFICIAL
Theo nguồn cacbon: là dị dưỡng vì glucozơ là nguồn cacbon kiến tạo nên các chất của tế bào.
Theo nguồn cho electron: là dinh dưỡng hữu cơ vì glucozơ là nguồn cho electron trong lên men lăctic đồng hình.
Theo các chất thêm vào môi trường cơ sở: là vi khuẩn khuyết dưỡng, thiếu 1 trong 2 chất trên vi khuẩn không phát triển được.
b) Các chất thêm vào môi trường cơ sở có vai trò: Các chất folic, pyridoxin là các nhân tố sinh trưởng đối với vi khuẩn nêu trên. Thiếu 1 chất trong 2 chất này thì vi khuẩn không thể tự tổng hợp được và không sinh trưởng.
Axit folic là một loại vitamin giúp hình thành tổng hợp purin và pirimidin. Pyridoxin là vitamin B6 giúp chuyển amin của các axit amin.
Câu 5
Nêu sự khác biệt về quá trình xâm nhập và cởi vỏ giữa virut của vi khuẩn (phagơ) với virut động vật. Nếu bơm prôtôn trong lizôxôm không hoạt động sẽ ảnh hưởng như thế nào đến quá trình xâm nhập và nhân lên của 2 loại virut trên?
Hướng dẫn vận dụng kiến thức:
+ Sinh học vi sinh vật: sự xâm nhập và nhân lên của virut trong tế bào chủ:
+ Sinh học tế bào: Vai trò của lizoxom trong quá trình xâm nhập của virut động vật: lizoxom là túi chứa các enzyme thuỷ phân có màng bao mà các tế bào động vật dung để tiêu hoá các đại phân tử. Các enzyme của lizoxom hoạt động tốt nhất trong môi trường acid. Nếu lizoxom bị phá vỡ hoặc rò rỉ chất chứa của nó thì các enzyme được giải phóng ra hoạt động không mạnh vì dịch bào có pH trung tính. Tuy nhiên, sự
DẠYKÈMQUYNHƠN
85
rò rỉ quả nhiều từ một số lượng lướng lizoxom có thể phá huỷ tế bào bằng cách tự tiêu hoá. Cac enzyme thuỷ phân và màng lizoxom do ER hạt tạo ra và sau đó được truyền đến bộ máy Golgi để xử lý tiếp.
OFFICIAL
Lizoxom thực hiện sự tiêu hoá nội bào trong nhiều hoàn cảnh. Trùng amip và nhiều protisst khác ăn bằng cách nhấn chìm (nuốt) các sinh vật nhỏ hoặc các hạt thức ăn, quá trình đó gọi là sự thực bào (phagocytosis). Sau đó không bào thức ăn được hình thành theo cách này, kết hợp với lizoxom để các enzyme tiêu hoá thức ăn. Các sản phẩm tiêu hoá, bao gồm đường đơn, amino acid và các đơn phân khác, đi vào dịch bào và trở thành chất dinh dưỡng cho tế bào. Một số tế bào người cũng tiến hành thực bào. Trong số đó, có các đại thực bào, loại tế bào bạch cầu bảo vệ cơ thể bằng cách “nuốt” và tiêu huỷ vi khuẩn và các kẻ xâm nhập khác. Lizoxom cũng dung các enzyme thuỷ phân để tái quay vòng vật chất hữu cơ riêng của tế bào, đó là quá trình tự thực bào. Trong quá trình này, bào quan bị tổn thương hoặc một lượng nhỏ dịch bào bị bao bởi lớp màng kép chưa rõ nguồn gốc và lizoxom kết nối với màng ngoài của túi đó. Các enzyme của lizoxom phá huỷ vật chất được bao bọc bên trong và các monomer được đưa trở lại dịch bào để tái sử dụng. Với sự trợ giúp của lizoxom tế bào liên tục tự đổi mới. Ví dụ, các tế bào gan người, mỗi tuần, tái quay vòng một nửa các đại phân tử của nó. Tế bào của những người mắc bệnh dự trữ lizoxom di truyền không có enzyme thuỷ phân hoạt động chức năng bình thường trong các lizoxom. Các lizoxom bị nhét đầy các cơ chất không được tiêu hoá bắt đầu ảnh hưởng đến các hoạt động khác của tế bào. Ví dụ, bệnh Tay-sachs, enzyme tiêu hoá lipid bị mất hoặc không hoạt động và não bị hư hại do sự tích luỹ lipit trong tế bào. Rất may là bệnh dự trữ lizoxom rất hiếm trong quần thể
- Trong quá trình xâm nhập của virut vào tế bào động vật: Nếu bơm prôtôn trong lizoxom không hoạt động, môi trường không bị axit hóa, các enzyme không được hoạt hóa để phân giải capsit thì axit nucleic của virut động vật không được giải phóng khỏi vỏ capsit dẫn đến virut động vật không nhân lên được.


- Quá trình cởi vỏ capsit và nhân nhân lên ở phagơ không sử dụng bơm prôtôn trong lizoxom của tế bào.
Câu 6 (IBO 2013)
Bilirubin là sản phẩm phân huỷ tạo ra từ quá trình dị hoá nhân heme và được đưa đến gan, tại đây nó liên kết với hai phân tử axit glucuronic nhờ enzim UGT (xem hình phía dưới). Bilirubin liên kết sau đó được tiết vào ruột non như là một thành phần của dịch mật:
DẠYKÈMQUYNHƠN
Hãy chỉ ra các phát biểu sau là đúng hay sai
A. Liên kết với axit glucoronic làm tăng tính hoà tan của bilirubin trong nước
B. Một khối u làm tắc đoạn ống dẫn mật sát với ruột non dẫn đến làm giảm hàm lượng bilirubin liên kết trong máu
C. Một đột biến điểm gây giảm đáng kể hoạt tính của UGT dẫn đến làm giảm hàm lượng bilirubin không liên kết trong máu.
D. Tăng hàm lượng bilirubin liên kết trong máu là triệu chứng của nhiễm trùng sốt rét
Hướng dẫn vận dụng kiến thức: Hoá sinh enzim, đột biến gen
Hướng dẫn trả lời A. Đúng, B. Sai, C. Sai, D. Đúng Giải thích
OFFICIAL
A. Đúng - Axit glucoronic là một phân tử hydrpphilic, trong khi bilirubin kỵ nước và không hòa tan trong nước. Liên kết với axit glucoronic làm tăng khả năng hòa tan của nó trong nước
B. Sai - Khi mật không thể vào ruột non, bilirubin liên hợp sẽ tích tụ trong ống mật và di chuyển ngược lên trong đường mật trong gan và đi vào máu. Kết quả là, sự liên hợp bị giảm hoặc thậm chí ngừng gây ra sự tích tụ của bilirubin không liên hợp.
C. Sai - Nếu UGT không hoạt động bình thường (như ở bệnh nhân Morbus Meulengracht), sự liên hợp của bilirubin bị giảm và mức độ bilirubin không liên hợp tăng lên.
D. Đúng - Ở một giai đoạn, Plasmodium falciparum sinh sản trong hồng cầu. Các khi hồng cầu này vỡ ra giải phóng các ký sinh trùng, dẫn đến giải phóng hemoglobin, do đó làm tăng nồng độ bilurubin trong máu, chất này sẽ được liên hợp. Câu 7 (QG2015 ngày 2)
Một trong các protein đặc thù của phức hệ kết dính các nhiễm sắc tử trong giảm phân là protein Rec8. Protein chỉ được biểu hiện trong giảm phân, không phân rã trong giảm phân I, nhưng bị phân rã trong giảm phân II, nhờ vậy các nhiễm sắc tử chỉ được tách khỏi nhau trong giảm phân II. Từ hiện tượng đó, các nhà khoa học cho rằng trong tế bào có một loại protein ngăn không cho Rec8 phân rã ở giảm phân I. Người ta tạo tế bào nấm men chuyển gen mang nhiễm sắc thể nhân tạo nấm men (YAC) chứa gen Rec8 và cho biểu hiện trong nguyên phân, các tế bào được chuyển gen có thể sống bình thường. Để tìm gen ngăn sự phân rã của Rec8, người ta cho biểu hiện các gen khác trong dòng tế bào biểu hiện Rec8 trong nguyên phân, từ đó tìm ra gen mã hóa protein Shugoshin chính là protein ngăn Rec8 không phân rã ở giảm phân I. Hãy dự đoán:
DẠYKÈMQUYNHƠN
87
a) Bằng cách nào người ta biết là protein Shugoshin mà không phải là các protein khác ngăn sự phân rã của Rec8?
b) Kiểu hình của tế bào tái tổ hợp biểu hiện đồng thời Rec8 và Shugoshin sẽ như thế nào?
Hướng dẫn vận dụng kiến thức:
- Phân bào giảm phân: Các nhiễm sắc tử chị em đính với nhau trong suốt giảm phân I nhưng lại tách nhau ra trong giảm phân II và trong nguyên phân như thế nào? Các nhiễm sắc tử được gắn với nhau theo suốt chiều dài của chúng bằng các phức hợp protein được gọi là cohensin. Trong nguyên phân sự gắn kết này kéo dài tới tận cuối kì giữa, khi enzyme phân huỷ cohensin làm cho các nhiễm sắc tử có thể di chuyển về các cực đối lập của tế bào. Trong giảm phân, sự gắn kết các nhiễm sắc tử được giải phóng qua hai bước. Ở kì giữa I, các nhiễm sắc thể được giữ với nhau bởi sự gắn kết giữa các vai của các nhiễm sắc tử trong các vùng mà ở đó DNA đã được trao đổi. Trong kì sau I, cohensin được loại bỏ ở các vai cho phép các NST tương đồng tách nhau ra. Ở kì giữa II, cohensin được loại bỏ ở tâm động cho phép các nhiễm sắc tử tách rời nhau.
OFFICIAL
Các thí nghiệm được trình bày bởi Yoshinori Watanabe và các cộng sự ở trường đại học Tokyo đã biết rằng có các protein tương tự nhau trong các phức hợp cohensin ở nguyên phân và giảm phân, họ muốn biết rằng cái nào làm nhiệm vụ ngăn cản sự phân huỷ cohensin ở tâm động trong khi sự phân huỷ lại xảy ra ở vài vào cuối kì giữa I. Họ đã tìm thấy một protein có tên là shugosin (tiếng Nhật có nghĩa là “tinh thần vệ sĩ”) bảo vệ cohensin khỏi bị phân huỷ ở tâm động trong suốt giảm phân I. Shugosin tương tự protein của ruồi quả đã được nhận biết cách đó 10 năm bởi Terry OrrWeaver. Giảm phân I được gọi là phân bào giảm nhiễm vì nó làm giảm số bộ nhiễm sắc thể trong mỗi tế bào đi một nửa-giảm từ hai bộ (trạng thái lưỡng bội). Trong giảm phân II, (đôi khi còn gọi là phân bào đồng đều) các nhiễm sắc tử chị em phân ly tạo ra các tế bào đơn bội. Cơ chế phân ly nhiễm sắc tử chị em thực tế cũng y hệt nhau trong giảm phân II và trong nguyên phân. Cơ sở phân tử của hoạt động của các nhiễm sắc thể trong giảm phân còn tiếp tục là tâm điểm thu hút sự quan tâm nghiên cứu của các nhà khoa học.
Yoshinori Watanabe và các cộng sự đã biết rằng trong kì sau I, protein shugosin chỉ có ở xung quanh tâm động. Họ muốn biết liệu nó có bảo vệ cohensin khỏi bị phân huỷ trong giảm phân I để đảm bảo cho các nhiễm sắc tử vẫn gắn với nhau trong khi các NST tương đồng phân ly hay không. Để kiểm tra giả thuyết này, họ đã sử dụng một loài nấm men, trong đó giảm phân tạo ra các bào tử đơn bội nằm thẳng hàng theo một trình tự đặc biệt trong nang bào tử. Để theo dõi sự di chuyển của các nhiễm sắc thể, họ đã đánh dấu huỳnh quang vùng gần tâm động của cả hai nhiễm sắc tử của một nhiễm sắc thể tương đồng, còn vùng này của nhiễm sắc thể tương đồng còn lại thì không đánh dấu. Sau đó họ đã làm bất hoạt gen mã hoá shugosin và so sánh dòng nấm men này (shugosin-) với dòng nấm men bình thường (shugosin+). Các nhà nghiên cứu đã kì vọng rằng hai nhiễm sắc thể đã được đánh dấu hình thành từ hai nhiễm sắc tử
DẠYKÈMQUYNHƠN
88
trong tế bào bình thường sẽ phân ly về các bào tử khác nhau, nằm mỗi cái ở một đầu của túi bào tử. Tiếp đó, họ cũng tiên đoán rằng nếu shugosin bảo vệ cohensin ở tâm động khỏi bị phân huỷ ở kì sau I thì các nhiễm sắc thể được đánh dấu trong các tế bào shugosin- sẽ phân ly một cách ngẫu nhiên trong giảm phân II, đôi khi chúng lại ở cùng một bào tử.
OFFICIAL
bào shugosin+ hai nhiễm sắc thể đánh dấu đi về các bào tử p. Trong các tế bào shugosin-chừng 50% các trường hợp chúng lại ở cùng với nhau trong cùng một bào tử
Kết luận: Shugosin bảo vệ cohensin ở tâm động trong kì sau I, nhờ vậy duy trì được sự gắn kết giữa các nhiễm sắc tử chị em và đảm bảo cho chúng phân ly bình thường trong giảm phân II.
Hướng dẫn trả lời
a) Với các tế bào có gen Shugoshin được biểu hiện (có protein Shugoshin) thì sự phân li NST trong nguyên phân diễn ra không bình thường, còn các tế bào có các gen khác được biểu hiện nguyên phân diễn ra bình thường.
b) Vì có cả Shugoshin và protein Rec 8 cùng được biểu hiện trong nguyên phân, nên có nhiễm sắc thể được phân ly, nhiễm sắc thể khác không phân li, do sự ngăn cản của Shugoshin. Kết quả tạo ra nhiều loại tế tế bào con lệch bội khác nhau.


Một số tế bào có thể có 4 bản sao của cùng một 1 NST, một số có 2 bản sao của cùng 1 NST, trong khi một số thiếu (không có) một NST nào đó. Nhiều kiểu gen này gây chết, dẫn đến kiểu hình là khuẩn lạc nấm men chậm phát triển.
Câu 8. (Trích đề thi HSG QG 2015 ngày 2)
Để tìm một loại protein là yếu tố phiên mã được tổng hợp ở một loại mô nhất định, người ta phải tách chiết các yếu tố phiên mã ra khỏi tế bào. Hãy mô tả cách làm tiếp theo để nhận biết được sự có mặt của yếu tố phiên mã cần tìm trong hỗn hợp protein tách chiết (nêu tóm tắt nguyên lý và các bước cần tiến hành).
DẠYKÈMQUYNHƠN
89
Hướng dẫn vận dụng kiến thức:
Công nghệ sinh học: Phương pháp điện di trên gel:
Ứng dụng: Điện di trên Gel là phương pháp được dùng để phân tách các acid nucleic hoặc protein khác nhau về kích thước, độ tích điện, hoặc các thuộc tính vật lí khác. Các phân tử DNA được phân tách bởi diện di trên gel trong các thí nghiệm phân tích các doạn giới hạn đối với cả các gen được nhân dòng.

Kĩ thuật: Phương pháp này phân tách các đại phân tử trên cơ sở tốc độ di chuyển trên điện trường qua gel polyme. Khoảng cách di chuyển của một phân tử DNA tỷ lệ nghịch với chiều dài của nó. Một hỗn hợp các phân tử, thường là các đoạn cắt giới hạn hoặc là sản phẩm PCR, được phân tách thành các băng. Mỗi băng chứa hàng nghìn phân tử có kích thước giống nhau.
OFFICIAL
Phương pháp điện di trên Gel
Phương pháp thẩm tách western-blot
Phương pháp này sử dụng điện di trên gel để phân tách các protein còn nguyên vẹn bằng cấu trúc 3D hay protein đã biến tính theo độ dài của mạch polypeptide. Protein này sau đó sẽ được chuyển lên màng (thường sử dụng là màng nitrocellulose hay màng PVDF), ở đó chúng được gắn bằng các kháng thể đặc hiệu với protein mục tiêu. Điện di trên gel sẽ được đưa vào hệ thống phân tích Western Blot nhằm giải quyết các vấn đề của các phản ứng chéo giữa các kháng thể.
Phương pháp Western Blot

DẠYKÈMQUYNHƠN
90
Nguồn ảnh: http://proteomics.case.edu/proteomics/westernblot.htm
1. Nguyên lý
Western Blot là kỹ thuật lai giữa protein với protein (Kháng nguyên – Kháng thể). Protein kháng nguyên được phát hiện qua phản ứng tạo màu hoặc phát huỳnh quang
2. Các bước thực hiện: Bước 1: Xử lý mẫu Lấy mẫu từ toàn bộ mô hay môi trường nuôi cấy tế bào. Đầu tiên, xử lý mô rắn bằng phương pháp cơ học sử dụng máy nghiền, sử dụng máy đồng hóa hoặc siêu âm. Những mẫu virus hay mẫu lấy trừ trong môi trường nuôi cấy cũng có thể là nguồn protein xác định được trong Western Blot. Thêm các loại chất tẩy rửa, muối và dung dịch đệm để ly giải tế bào và hòa tan protein.
OFFICIAL
Bước 2: Điện di trên gel Điện di trên gel để phân tách các protein trong mẫu. Sự phân tách này của protein dựa trên điểm đẳng điện, khối lượng phân tử, điện tích hoặc phối hợp các yếu tố trên.
Phương pháp điện di phổ biến nhất là điện di trên gel polyacrylamide và có bổ sung sodium dodecyl sulfate (SDS). Phương pháp SDS – PAGE (điện di trên gel polyacrylamide và có bổ sung SDS) giữ các polypeptide ở trạng thái biến tính sau khi chúng được xử lý với chất khử mạnh và mất đi cấu trúc bậc 2, cấu trúc bậc 3.
Các mẫu được nạp vào trong các giếng của bản gel. Thường để lại một giếng cho chỉ thị (marker) hoặc thang chuẩn ladder, là một sản phẩm thương mại có chứa hỗn hợp các protein với khối lượng phân tử xác định được nhuộm để có thể tạo ra band màu và nhìn thấy được. Khi điện thế được thiết lập trên gel, protein bắt đầu di chuyển với tốc độ khác nhau phụ thuộc vào khối lượng phân tử của chúng. Vận tốc khác nhau của các protein (sự khác biệt về độ di động điện di) sẽ tạo thành vạch khác nhau trên mỗi giếng.
Bước 3: Chuyển protein gel lên màng lai Để các protein có thể phát hiện được kháng thể thì protein phải được chuyển từ gel lên màng lai. Phương pháp chính để chuyển các protein được gọi là phương pháp thẩm tách điện là sử dụng một dòng điện để kéo các protein từ gel lên màng PVDF hoặc màng nitrocellulose. Các protein được chuyển lên màng mà vẫn duy trì sự sắp xếp như trên bản gel. Kết quả là protein sẽ được phơi ra trên lớp mỏng bề mặt để tiến hành xác định Bước 4: Xử lý màng lai (Blocking) Do kháng thể và protein đích đều là protein, nên thường thực hiện các bước để ngăn chặn liên kết giữa màng và kháng thể được sử dụng để xác định protein mục tiêu.
DẠYKÈMQUYNHƠN
91
Việc ngăn chặn các liên kết không đặc hiệu bằng cách đặt màng vào dung dịch protein loãng albumin huyết tương bò 3-5 % (BSA) hoặc sữa bột không béo trong Tris –Buffered saline (TBS). Protein trong dung dịch loãng sẽ gắn với màng ở tất cả các vị trí mà protein đích chưa gắn vào. Do đó khi kháng thể được bổ sung vào, sẽ không còn chỗ bám trên màng ngoại trừ các vị trí liên kết đặc hiệu với protein đích. Điều này làm giảm nhiễu cơ bản trong sản phẩm cuối cùng của Western Blot, cho kết quả rõ ràng và ngoại trừ hiện tượng dương tính giả. Bước 5: Quá trình lai và phát hiện vị trí lai Để phát hiện các protein chuyên biệt, màng được dò protein quan tâm bằng kháng thể đã biến đổi có khả năng liên kết với enzyme thông báo, enzyme này khi kết hợp với một cơ chất tương ứng sẽ thúc đẩy phản ứng hấp thụ quang và tạo màu. Quá trình này diễn ra gồm 2 bước:
OFFICIAL
- Màng lai đã cố định protein được lai với kháng thể sơ cấp. Kháng thể sơ cấp là một kháng thể đặc hiệu được tạo ra khi cho vật chủ hay môi trường nuôi cấy tế bào miễn dịch tiếp xúc với protein quan tâm.
- Sau khi rửa màng để loại bỏ kháng thể sơ cấp chưa liên kết, màng tiếp tục gắn kháng thể thứ hai (kháng thể thứ cấp) có gắn enzyme (thường sử dụng horseradish peroxidase). Tiếp tục ủ màng lai trong một hỗn hợp phản ứng đặc hiệu với enzyme. Đặt 1 tấm phim ngạy cảm với tia X lên màng lai để phát hiện các điểm sáng phát ra do enzyme.
Có thể sử dụng nhiều phương pháp để phát hiện kháng thể thứ cấp: sử dụng bức xạ hồng ngoại gần liên kết với kháng thể gắn chất huỳnh quang, sử dụng đánh dấu phóng xạ
3. Ứng dụng: Xác định sự hoạt động của gel thông qua sự có mặt của protein trong mô Nhận dạng protein mục tiêu Đánh giá tính chuyên biệt của kháng thể Phân tích bệnh do vi khuẩn và virus gây ra: thử nghiệm khẳng định HIV, viêm gan B
Năm 2002, đã ứng dụng thành công phương pháp Western Blot trong việc xác định kháng nguyên giun đũa chó (Toxocara canis) trên thỏ (Olga Lucia Morales và ctv, 2002), mở ra một hướng đi mới trong việc xét nghiệm chẩn đoán chính xác các bệnh ký sinh trùng trên người. Hướng dẫn trả lời - Học sinh cần nói được bước đầu tiên cần tiến hành điện di để tách phân đoạn protein khỏi nhau. Vì các đoạn protein có các phần tích điện trái dấu khác nhau nên
DẠYKÈMQUYNHƠN
92
trước khi điện di, các protein phải được xử lý hóa chất để cho các phân đoạn protein đều được tích điện âm (âm hóa) thì chúng mới di chuyển được trong điện trường.
- Tiếp theo cần tiến hành thẩm tách để chuyển các phân đoạn protein từ gel điện di lên màng thẩm tách (thẩm tách Western) để cố định các protein trên màng thẩm tách.
- Nhận biết protein cần tìm dựa trên phản ứng kháng nguyên kháng thể đặc hiệu bằng cách cho kháng thể đánh dấu tiếp xúc với các phân đoạn protein, ở đâu có yếu tố phiên mã liên kết được với kháng thể thì sẽ có thể thì ta có thể nhận ra.
Câu 9 (Trích đề thi HSGQG 2016 ngày 1)
Có hai ống nghiệm bị mất nhãn, trong đó có một ống nghiệm chứa nấm men Saccharomyces cerevisiae (S. cerevisiae) và ống nghiệm còn lại chứa vi khuẩn Escherichia coli (E. coli). Hãy đưa ra 04 phương pháp giúp nhận biết ống nghiệm nào chứa nấm men S. cerevisiae và ống nghiệm nào chứa vi khuẩn E. coli
OFFICIAL
Hướng dẫn vận dụng kiến thức: hoá sinh tế bào vi sinh vật S. cerevisiae là sinh vật nhân thực có hình bầu dục, kích thước lớn có thể quan sát dưới kính hiển vi với độ phóng đại 400 lần. Trong khi đó, E. coli là vi khuẩn sinh vật nhân sơ, hình que, kích thước của E. coli nhỏ hơn nhiều so với S. cerevisiae nên phải phóng to ít nhất 1000 lần mới nhìn thấy rõ hình thái tế bào. Cấu trúc thành tế bào vi khuẩn E. coli có chứa hợp chất peptidoglycan rất mẫn cảm với kháng sinh. Nấm men có thể sinh sản bằng nảy chồi hoặc sinh sản hữu tính, vi khuẩn phân chia theo lối trực phân. Nấm men S. cerevisiae có khả năng thực hiện chuyển hoá piruvat trong điều kiện thiếu oxi thành etanol (lên men rượu).
Hướng dẫn trả lời:
- Phương pháp 1: Làm tiêu bản và quan sát tế bào dưới kính hiển vi, S. cerevisiae là sinh vật nhân thực có hình bầu dục, kích thước lớn có thể quan sát dưới kính hiển vi với độ phóng đại 400 lần. Trong khi đó, E. coli là vi khuẩn sinh vật nhân sơ, hình que, kích thước của E. coli nhỏ hơn nhiều so với S. cerevisiae nên phải phóng to ít nhất 1000 lần mới nhìn thấy rõ hình thái tế bào.
- Phương pháp 2: Dùng phương pháp lên men dịch ép hoa quả để phân biệt hai loài: sử dụng dịch chiết hoa quả vô trùng chia đều ra hai bình như nhau rồi cấy vi sinh vật vào. Sau đó bịt kín bình và giữ ở nhiệt độ, thời gian thích hợp. Nếu bình nào sinh ra nhiều CO2, tạo ra nhiều bọt khí có mùi rượu thì bình đó chứa nấm men, bình còn lại là chứa E. coli (do E. coli không có khả năng lên men rượu)
- Phương pháp 3: Bổ sung vào hai ống nghiệm chất kháng sinh có khả năng ức chế sự phát triển của E. coli. ở ống nghiệm chứa E. coli thì E. coli sẽ không sinh trưởng và không phát triển được.
- Phương pháp 4: có thể kiểm tra bằng hình thức quan sát khuẩn lạc trên môi trường nuôi cấy vi khuẩn (MPA) và môi trường nuôi cấy nấm men (Hansen). E. coli
DẠYKÈMQUYNHƠN
93
mọc kém hoặc không mọc trên môi trường nấm men, còn nấm men mọc tốt ở cả hai môi trường. Câu 10 (Trích đề HSG QG 2016 ngày 1) Một số loài vi khuẩn có thề sử dụng êtanol (CH3-CH2-OH) hoặc axêtat (CH3COOH) làm nguồn cacbon duy nhất trong quá trình sinh trưởng. Tốc độ hấp thụ ban đầu hai loại chất này của tế bào vi khuẩn được trình bày trong bảng dưới đây: Nồng độ cơ chất (mM) Tốc độ hấp thụ của Vi khuẩn (µmol/phút) Chất A Chất B 0,1 2 18 0,3 6 46 1,0 20 100 3,0 60 150 10,0 200 182 Vẽ đồ thị biểu diễn mồi quan hệ giữa tốc độ hấp thụ ban đầu và nống độ của hai chất trên
Dưa vào đồ thị đã vẽ, hãy cho biết: Sự vận chuyển của hai chất A và B qua màng tể bào vi khuẩn theo cách nào? Giải thích. Hai chất A và B, chất nào là êtanol và chất nào là axêtat? Giải thích Hướng dẫn vận dụng kiến thức: + Hoá sinh: Sự vận chuyển các chất qua màng sinh chất Vận chuyển thụ động: là sự khuếch tán các chất qua màng mà không cần năng lượng. Sự khuếch tán diễn ra khi không có các lực khác tác động thì một chất sẽ khuếch tán từ nơi có nồng độ cao đến nơi có nồng độ thấp hơn. Đây là quá trình vận chuyển thụ động vì tế bào không phải chi phí năng lượng. Gradien nồng độ bản thân nó là thế năng và điều khiển sự khuếch tán. Tuy nhiên, màng có tính thấm chọn lọc vì vậy nó có hiệu ứng khác nhau với tốc độ khuếch tán của các đại phân tử khác nhau Khuếch tán tăng cường: sự vận chuyển thụ động nhờ protein: Câu hỏi đặt ra là bằng cách nào mà nước và các chất tan ưa nước có thể đi qua màng, vì màng có thành phần chính là photpholipt sẽ cản lại các phân tử phân cực và các ion. Với sự trợ giúp của các protein vận chuyển xuyên màng, nước và các chất tan ưa nước có thể dễ dàng vận chuyển qua màng sinh chất. Hầu hết protein vận chuyển rất đặc hiệu, chúng vận chuyển chất này mà không vận chuyển chất kia. Các protein tham gia vào quá trình này là protein kênh và protein mang. Tốc độ vận chuyển tỉ lệ thuận với số lượng
DẠYKÈMQUYNHƠN
94
OFFICIAL
protein mang và protein kênh, khi tất cả các kênh đã bão hoà, tốc độ vận chuyển sẽ giảm.
Sự vận chuyển các chất qua màng tế bào phụ thuộc vào nhiều yếu tố: bản chất của chất tan, kích thước, ....
+ Vi sinh: Cấu tạo MSC tế bào vi khuẩn Hướng dẫn trả lời a. hình vẽ
OFFICIAL
b. Sự hấp thụ chất B qua đồ thị cho thấy tốc độ vận chuyển các chất vào trong tế bào lúc đầu tăng cùng với việc tăng nồng độ các chất. Nhưng đến một giai đoạn nhất định thì tốc độ phản ứng gần như không tăng ngay kể cả khi nồng độ chất tan tiếp tục tăng lên. Chất B được vận chuyển qua kênh protein và việc vận chuyển của chất B không tăng ở giai đoạn sau là hiện tượng bão hòa kênh.
Sự hấp thụ chất A qua đồ thị cho thấy tốc độ vận chuyển chất tan phụ thuộc tuyến tính vào nồng độ chất tan. Điều này chỉ ra rằng chất A được khuếch tán trực tiếp qua lớp lipit kép của màng tế bào mà không cần phải qua kênh protein xuyên màng.
Từ đồ thị cho thấy:
- Chất A là etanol vì etanol là chất phân tử nhỏ, không tích điện nên có thể khuếch tán trực tiếp qua lớp lipit kép của màng tế bào dễ dàng hơn rất nhiều so với axêtat.
- Chất B là axêtat vì là chất tích điện nên sẽ khó khuếch tán trực tiếp qua lớp lipit kép của màng tế bào vì lớp phospholipit kép có chứa các đuôi hydrocacbon kị nước (không phân cực).

Câu 11 (Trích đề thi HSGQG 2016-ngày 2)
X là protein có tác dụng ngăn ngừa sự tăng cân ở người. Protein này bất hoạt ở những người béo phì. Các phân tử mRNA trưởng thành của X phân lập được từ một số người béo phì của cùng một gia đình cho thấy, chúng thiếu một đoạn trình tự dài 173 nucleotit so với các phân tử mRNA trưởng thành phân lập được từ những người bình thường. Khi so sánh trình tự gen mã hóa cho protein X của người bình thường và người béo phì, người ta phái hiện ra rằng không có nucleotit nào bị mất mà chỉ có 1 nucleotit bị thay đổi. Sự thay đổi này xảy ra ở vùng intron của gen. Tại sao việc thay đổi 1 nucleotit lại có thể làm cho mRNA trưởng thành của gen đột biến bị mất một đoạn dài 173 nucleotit? Giải thích và minh họa bằng hình vẽ? Giải thích hiện tượng bất hoạt của protein X ở người béo phì?
DẠYKÈMQUYNHƠN
95
Để sản xuất protein này, người ta sử dụng kỹ thuật di truyền tạo plasmid tái tổ hợp giữa thể truyền bởi gen mã hóa protein X của người bình thường, sau đó chuyển vào vi khuẩn E. coli để sản xuất sinh khối. Sản phẩm protein tạo ra có bị bất hoạt không? Giải thích.
Hướng dẫn vận dụng kiến thức:
+ Di truyền: Đột biến gen thay thế nucleotit này bằng nucleotit khác.
+ Hoá sinh: Cấu tạo của hệ gen sinh vật nhân thực: Gen phân mảnh, xen giữa các đoạn mã hoá các axit amin (exon) là các đoạn không mã hoá (intron).
Điều hoà biểu hiện gen ở sinh vật nhân thực: Các enzyme trong nhân tế bào nhân thực có thể biến đổi phân tử tiền mRNA theo một số cách đặc trưng trước khi bản phiên mã di truyền được chuyển ra khỏi tế bào chất. Trong quá trình hoàn thiện mRNA này cả hai đầu của phân tử mRNA tiền thân đều được biến đổi. Ngoài ra trong phần lớn các trường hợp, một số phần bên trong phân tử RNA cũng được cắt bỏ, trong khi các phần còn lại được nối lại với nhau. Kết quả của những biến đổi này tạo ra một phân tử RNA sẵn sàng cho quá trình dịch mã. Gen ở sinh vật nhân thực là gen phân mảnh. Một giai đoạn đáng chú ý trong quá trình hoàn thiện mRNA trong nhân của sinh vật nhân thực là việc loại bỏ đi một phần lớn các đoạn bên trong phân tử mRNA tiền thân. Chiều dài trung bình của một đơn vị phiên mã dọc theo phân tử DNA của người gồm khoảng 27.000 cặp base, vì vậy, phân tử mRNA tiền thân thường có chiều dài tương ứng. Tuy vậy, để mã hoá một phân tử protein có kích thước trung bình gồm 400 amino acid, chỉ cần một phân tử RNA có kích thước gồm 1200 nucleotit (mỗi amino acid được mã hoá bởi một bộ ba nucleotit). Điều này có nghĩa là phần lớn các gen ở sinh vật nhân thực và các bản phiên mã RNA tiền thân của chúng chứa các đoạn dài không mã hoá, đây là những đoạn không được dịch mã. Những đoạn này thường nằm xen kẽ giữa các đoạn mã hoá của gen và tương ứng là giữa các đoạn mã hoá trên tiền mRNA. Nói cách khác, trình tự các nucleotit DNA mã hoá cho một chuỗi polipeptit thường không liên tục, chúng được phân tán thành các đoạn mã hoá (exon) và đoạn không mã hoá (intron). Để tạo ra một phiên bản tiền thân từ một gen, RNA polimeraza ban đầu tiến hành phiên mã toàn bộ gen, bao gồm cả các đoạn exon và intron. Tuy vậy phân tử mRNA đi vào tế bào chất là phân tử đã được cắt ngắn. Các intron được cắt khỏi phân tử, các exon được nối lại với nhau để hình thành nên một phân tử mRNA mang trình tự mã hoá liên tục. Quá trình này được gọi là sự cắt nối RNA. Sự cắt nối RNA được diễn ra nhờ các tín hiệu, chúng là các trình tự nucleotit ngắn ở hai đầu intron. Các hạt có tên là các ribonucleotitprotein nhân kích thước nhỏ (snRNP) có thể nhận ra các vị trí cắt nối này. Như tên gọi của chúng các snRNP có trong nhân tế bào và có thành phần cấu tạo gồm các phân tử RNA và protein. Các RNA có trong các snRNP là các RNA nhân kích thước nhỏ (snRNA), mỗi phân tử chỉ dài khoảng 150 nucleotit. Một số loại snRNP kết hợp với nhau và với một số protein bổ sung khác hình thành nên bộ máy cắt nối RNA và được gọi là spliceosome (hay thể cắt nối), chúng có kích thước lớn tương đương ribosome. Spliceosome tương tác với những vị
OFFICIAL
DẠYKÈMQUYNHƠN
96
trí nhất định trên intron, giải phóng intron và nối hai exon ở hai đầu của mỗi intron, giải phóng intron và nối hai exon ở hai đầu của mỗi intron lại với nhau. Một số bằng chứng cho thấy, các snRNA, ngoài là thành phần của bộ máy spliceosome và nhận biết các vị trí cắt nối, còn có vai trò trực tiếp xúc tác các phản ứng cắt nối RNA.
Vai trò xúc tác của snRNA bắt nguồn từ việc phát hiện ra các ribozim, đó là các phân tử RNA có chức năng giống như các enzyme. Ở một số sinh vật, sự cắt nối RNA ở một số gen có thể diễn ra mà không cần có bất cứ một loại protein hay thậm chí một loại RNA bổ sung nào khác. Cac đoạn intron của RNA có chức năng như một loại ribozyme và có khả năng tự xúc tác quá trình cắt-nối. RNA có ba thuộc tính giúp nó có thể biểu hiện chức năng như các enzyme. Thứ nhất, do RNA có cấu trúc mạch đơn nên một vùng trên phân tử có thể bắt cặp bổ sung với một vùng khác trên cùng phân tử đó, điều này giúp cho RNA có cấu trúc không gian đặc thù. Một cấu trúc không gian đặc thù là điều kiện tiên quyết để có chức năng xúc tác của ribosome, cũng giống như ở các enzyme là protein vậy. Thứ hai, giống với một số amino acid trong các enzyme là protein, một số base nucleotit của RNA mang các nhóm chức có thể tham gia vào các hoạt động xúc tác. Thứ ba, các RNA có khả năng hình thành liên kết hydrogen với các phân tử acid khác (RNA hoặc DNA), điều này làm tăng tính đặc hiệu trong quá trình xúc tác của nó. Chẳng hạn như, sự bắt cặp bổ sung giữa các base trên phân tử tiền mRNA giúp định vị chính xác vị trí mà các ribozim sẽ xúc tác phản ứng cắt nối RNA. Vậy câu hỏi đặt ra là chức năng sinh học của các intron và sự cắt nối RNA là gì? Phần lớn các intron hiện nay chưa xác định được rõ chức năng sinh học cụ thể, một số intron đã biết sẽ chứa các trình tự tham gia điều hoà hoạt động của gen. Một trong những hậu quả của việc gen có intron là một gen duy nhất có thể mã hoá cho nhiều hơn một loại chuỗi polypeptit. Đến nay, chúng ta đã biết nhiều gen có thể mã hoá cho hai hay nhiều chuỗi polipeptit khác nhua tuỳ thuộc vào việc những đoạn nào được chọn là exon trong quá trình hoàn thiện mRNA, quá trình này được gọi là sự cắt nối RNA thay thế. Nhờ cơ chế này, số loại sản phẩm protein có thể tạo ra có thể lớn hơn rất nhiều so với lượng gen mà cơ thể đó có. Các protein thường có cấu tạo dạng modun gồm nhiều vùng cấu trúc và chức năng riêng biệt, được gọi là các miền. Chẳng hạn như, một miền của một enzyme có bản chất protein chứa vị trí xúc tác, trong khi một miền khác của nó làm nhiệm vụ liên kết protein với màng tế bào. Trong một số các trường hợp, các exon khác nhau mã hoá cho các miền khác nhau của cùng một protein. Các intron trong gen có thể thúc đẩy sự tiến hoá nhanh của các protein có tiềm năng mới nhờ quá trình được gọi là sự xáo trộn exon. Các intron làm tăng xác suất trao đổi chéo giữa các exon thuộc các gen alen với nhau - đơn giản bởi vì cũng cung cấp thêm “nền” cho sự trao đổi chéo mà không làm gián đoạn các trình tự Đột biến điểm có thể ảnh hưởng đến cấu trúc và chức năng của protein. Đột biến sẽ gây ra những biến đổi trong thông tin di truyền, gây nên các ảnh hưởng về kiểu hình, cũng chính là nguyên nhân dẫn đến sự đa dạng, phong phú của các gen ở mọi loài sinh vật. Đột biến chính là nguồn tạo ra mọi gen mới. Chúng ta xem xét đến các đột biến điểm, tức là những thay đổi hoá học xảy ra ở một cặp base nucleotide duy
OFFICIAL
DẠYKÈMQUYNHƠN
97
nhất của gen. Nếu đột biến điểm xuất hiện trong các tế bào giao tử hoặc các tế bào phát sinh giao tử thì nó có thể được truyền cho thế hệ con và các thế hệ con cháu sau này. Các kiểu đột biến điểm bao gồm hai nhóm lớn: thay thế cặp base và mất hoặc thêm cặp base. Các đột biến thay thế cặp base là những đột biến mà ở đó một cặp base này được thay thế bằng một cặp nucleotit khác. Một số dạng thay thế được gọi là các đột biến yên lặng, bởi vì do tính thoái hoá của mã di truyền, chúng không gây ảnh hưởng đến kiểu hình và biểu hiện chức năng của protein do gen mã hoá. Nói cách khác, sự thay đổi một cặp base có thể chuyển bộ ba mã hoá này thành bộ ba mã hoá khác, nhưng cả hai bộ ba đều mã hoá chung một axit amin. Các đột biến thay thế cũng có thể dẫn đến các đột biến sai nghĩa. Trường hợp như vậy có thể chỉ gây ảnh hưởng ít đến protein, nếu như amino acid mới có các thuộc tính giống với amino acid mà nó thay thế, hoặc khi nó nằm trong miền cấu trúc ít có tính quyết định đến hoạt động chức năng của protein. Những đột biến được quan tâm hơn cả là các đột biến thay thế cặp base làm thay đổi lớn ở protein. Thay đổi một amino acid trong các miền quan trọng của protein - chẳng hạn như trong phần cấu trúc của hemoglobin hoặc ở vị trí trung tâm hoạt động của enzyme - sẽ làm thay đổi hoạt tính protein một cách đáng kể. Trong một số trường hợp, những đột biến như vậy có thể dẫn đến sự tăng cường hoạt tính hoặc tăng thêm khả năng hoạt động của protein; nhung trong phần lớn các trường hợp, chúng có tác động gây hại, thường làm giảm hoặc mất hoạt tính của protein dẫn đến những sai hỏng trong biểu hiện chức năng của tế bào. Các đột biến thay thế thường là các đột biến sai nghĩa, nghĩa là bộ ba mã hoá bị thay đổi vẫn mã hoá cho một amino axit và vì vậy nó vẫn có nghĩa, nhưng nghĩa của nó “không còn đúng” nữa. Nhưng một đột biến điểm cũng có thể làm thay đổi một bộ ba mã hoá amino acid thành một bộ ba kết thúc dịch mã. Trường hợp này, được gọi là đột biến vô nghĩa, và nó dẫn đến sự kết thúc dịch mã sớm, chuỗi polipeptit được tạo ra thường ngắn hơn chuỗi polipeptit do gen bình thường mã hoá. Hầu hết các đột biến vô nghĩa đều dẫn đến các protein mất chức năng. Các đột biến thêm và mất nucleotit là sự bổ sung thêm vào hoặc mất đi một cặp nucleotit trong gen. Những đột biến này thường gây ảnh hưởng lớn hơn nhiều đến sản phẩm protein do gen mã hoá so với các đột biến thay thế nucleotit. Thêm và mất các nucleotit có thể làm thay đổi khung đọc của một thông điệp di truyền, do các bộ ba mã hoá bị sắp xếp lại trong quá trình dịch mã. Những đột biến như vậy được gọi là đột biến dịch khung, xuất hiện bất cứ khi nào số nucleotit được thêm vào hay mất đi không phải là bội số của ba. Tất cả các nucleotit nằm xuôi dòng sau vị trí đột biến đều bị xếp vào các nhóm bộ ba mã hoá không đúng, dẫn đến kết quả là gen được dịch mã sai nghĩa trầm trọng, ngoài ra, nó thường được kết thúc dịch mã sớm hơn hoặc muộn hơn dạng đột biên vô nghĩa. Trừ trường hợp, khung đọc bị thay đổi xuất hiện ở rất gần đầu cuối của gen, còn trong phần lớn các trường hợp đột biến dịch khung, protein tạo ra mất chức năng. Hướng dẫn trả lời a. Đột biến thay thế nucleotit này bằng nucleotit khác xảy ra trong vùng intron của gen nhưng lại làm cho phân tử mRNA trưởng thành tổng hợp từ gen đột biến ngắn
OFFICIAL
DẠYKÈMQUYNHƠN
98
hơn phân tử mRNA trưởng thành của gen bình thường 173 nucleotit, chứng tỏ đột biến trên đã xảy ra ở vùng nhận biết và cắt intron làm cho quá trình cắt intron bị biến đổi.
Thay vì chỉ cắt các trình tự intron thì tế bào đã cắt một trình tự gồm 1 đoạn exon xen kẽ 2 đoạn intron và đoạn exon này dài 173 nucleotit nên phân tử mRNA trưởng thành của gen đột biến kém phân từ mRNA trưởng thành của gen bình thường 173 nucleotit.
b. Đoạn exon bị mất dài 173 nucleotit. Đây là một số không chia hết cho 3, có nghĩa là exon này có nucleotit kết hợp với nucleotit của exon khác để tạo thành một bộ ba hoàn chỉnh.
Khi đoạn exon này bị mất sẽ gây ra hiện tượng dịch khung đọc đối với toàn bộ trình tự nucleotit phía sau exon này, nên phân tử protein tổng hợp từ gen đột biến sẽ mất đoạn axit amin do 173 nucleotit mã hóa đồng thời bị thay đồi toàn bộ trình tự axit amin ở đoạn peptide phía sau, làm cho protein bị mất chức năng (bất hoạt).
OFFICIAL
c. Sản phẩm protein tạo ra vẫn bị bất hoạt vì plasmid tái tổ hợp tạo ra từ gen mã hóa proiein X từ người bình thường mang cả đoạn intron. Đoạn trình tự này vẫn được phiên mã và giải mã bình thường trong cơ thể vi khuẩn. Vì thế, phân tử protein tạo ra có trình tự dài hơn hoặc ngắn hơn trình tự axit amin của protein X. Mặt khác, trình tự axit amin của sản phẩm protein tạo ra sẽ khác vài trình tự các axit amin của protein X.
Câu 12 (Trích đề HSG 2016 ngày 2)
a. Một bệnh nhân nhi là con đẻ cùa một cặp bố mẹ hôn nhân cận huyết mắc bệnh chậm phải triển không rõ nguyên nhân gây bệnh. Xét nghiệm hóa sinh cho thấy bệnh nhân này bị thiểu năng do bất hoạt 4 enzyme ở lizoxom. Hãy nêu các cơ chế để một đột biến lặn trên nhiễm sắc thể thường duy nhất có thể làm giảm hoạt tính hoặc giảm chức năng của 4 enzyme trên.
b. Tại sao các đột biến gen thường là đột biến lặn và nằm trên nhiễm sắc thể thường.
Hướng dẫn vận dụng kiến thức:
Hoá sinh: Cấu trúc và hoạt tính của enzyme: Enzyme là một đại phân tử hoạt động như một chất xúc tác, một tác nhân hoá học làm thay đổi tốc độ phản ứng nhưng không bị phản ứng tiêu thụ. Các enzyme chủ yếu có bản chất là protein. Khi thiếu enzyme thì các phản ứng hoá học trong các con đường chuyển hoá sẽ trở nên bị đình trệ nghiêm trọng do nhiều phản ứng hoá học sẽ tốn nhiều thời gian. Mỗi enzyme có cấu trúc không gian đặc thù, đặc biệt là vùng được gọi là trung tâm hoạt động. Vùng này được cấu tạo bởi một số các axit amin đặc thù làm cho trung tâm có cấu hình không gian đặc thù phù hợp với cơ chất mà enzyme tác động. Hình thù không gian của trung tâm hoạt động có thể bị thay đổi, ví dụ do đột biến sẽ làm thay đổi chức năng của enzyme. Nhiều enzyme, ngoài trung tâm hoạt động còn có thêm phần phụ được gọi là trung tâm điều chỉnh có tác dụng điều chỉnh hình thù của trung tâm hoạt động.
DẠYKÈMQUYNHƠN
99
Đối với một số enzyme, ngoài thành phần protein còn có một số chất khác tham gia (được gọi là cofactor ví dụ như một số ion kim loại như sắt, đồng, mangan, kẽm, niken, hoặc các chất hữu cơ như vitamin được gọi là coenzyme...). Cofactor thường liên kết cố định hoặc tạm thời với trung tâm hoạt động của enzyme vầ rất cần thiết cho hoạt động xúc tác. Cấu hình không gian của enzyme có liên quan chặt chẽ đến chức năng của nó. Các rối loạn hoá học sẽ là hậu quả tất yếu nếu tất cả các con đường chuyển hoá của tế bào hoạt động cùng lúc. Bản chất nội tại của quá trình sống là khả năng của tế bào có thể điều hoà một cách chặt chẽ các con đường chuyển hoá thông qua quá trình điều tiết các enzyme khác nhau hoạt động khi nào và ở đâu. Để làm được điều đó, tế bào hoặc đóng mở các gen mã hoá các protein đặc hiệu thông qua điều hoà hoạt động của các enzyme ngay khi chúng được tạo ra.
OFFICIAL
+ Lizoxom là một bào quan ở tế bào động vật (trừ tế bào hồng cầu), có dạng túi hoặc bóng được giới hạn bởi màng lipoprotein và chứa các enzyme thuỷ phân (hydraza). Lizoxom gồm hai dạng: Lizoxom cấp 1 và lizoxom cấp 2. Lizoxom cấp 1 là lizoxom mới được tạo thành chưa tham gia vào hoạt động phân giải. Lizoxom cấp 2 là lizoxom đang tham gia hoạt động phân giải, bao gồm hai loại: hêtrolizoxom xuất hiện do kết quả kết hợp của lizoxom cấp 1 với phagoxom. Otolizoxom được tạo thành do sự kết hợp của lizoxom cấp 1 với otophagoxom. Những bệnh liên quan đến lizoxom thường xảy ra do sự bất bình thường trong cấu trúc màng hoặc hệ enzyme của lizoxom. Sự phá huỷ màng lizoxom sẽ làm cho các enzyme trong lizoxom giải phóng gây tiêu huỷ tế bào hoặc giải phóng vi khuẩn vào các tế bào khác gây ra bệnh nhiễm trùng. Màng lizoxom cũng có thể bị sai lệch di truyền dẫn đến biến đổi tính thấm. Sự sai lệch trong hệ enzyme của lizoxom như thiếu một hoặc nhiều loại enzyme, nguyên nhân có thể do di truyền như thiếu hoặc sai lệch gen chịu trách nhiệm tổng hợp enzyme. Sự tích luỹ nhiều chất trong lizoxom do thiếu enzyme phân giải chúng, do nguyên nhân di truyền còn dẫn tới nhiều bệnh khác liên quan đến hệ thần kinh, tim mạch, thận, ... + Di truyền: đột biến gen Hướng dẫn trả lời a. - 4 enzyme này cùng dùng chung một co-enzyme và việc tổng hợp hoặc vận chuyển coenzyme này bị ảnh hưởng do đột biến gen mã hóa enzyme tổng hợp hoặc protein vận chuyển
- 4 enzyme này cùng được cấu tạo từ một tiểu phần (chuỗi polypeptit tiền thân) chung. Đột biến gen tổng hợp chuỗi polypeptit tiền thân đã gây ra sự sai khác của 4 enzyme được hình thành từ đoạn polypeptit này.
- 4 enzyme này đều được hoàn thiện (có dạng tiền thân không hoạt tính thành dạng có hoạt tính) bởi một enzyme chung-> đột biến gen này sẽ làm ảnh hưởng tới quá trình hoàn thiện 4 enzyme trên.
DẠYKÈMQUYNHƠN
100
- Bình thường cả 4 enzyme đều định vị tại một bào quan (lizoxom) nhưng sai hỏng trong quá trình hoạt động của bào quan đã ảnh hưởng đồng thời hoạt tính của 4 enzyme (ví dụ chúng đều không được vận chuyển vào trong bào quan và bị phân hủy trong tế bào chất)
b.
- Lý do phần lớn đột biến liên quan đến enzyme thiết yếu là đột biến mất chức năng và đều có tính lặn (ngược lại đột biến thêm chức năng là tính trội). Mặt khác, các enzyme thiết yếu được mã hóa bởi các gen đang hoạt động nên dễ bị đột biến hơn các gen không hoặc chưa hoạt động.
- Phần lớn các gen nằm trên nhiễm sắc thể thường, vì thế đột biến lặn trên nhiễm sắc thể thường là phổ biến nhất trong các đột biến mất chức năng của các enzyme thiết yếu.
Câu 13 (trích đề thi HSGQG 2016 ngày 2)
OFFICIAL
a. Giải thích vì sao phân tử DNA mạch kép có thể tạo phức hợp với protein histon để hình thành nucleoxom?
b. Những đột biến gen nào dẫn đến các cặp nhiễm sắc thể tương đồng ớ kỳ sau của nguyên phân không phân ly bình thường về hai cực của tế bào? Giải thích. Hướng dẫn vận dụng kiến thức:
Hoá sinh: cấu trúc DNA - Cấu trúc mạch đơn phân tử DNA: Mỗi nucleotit đơn phân chứa một base nitrogen (A, T, G hoặc C), đường deoxy ribozo và một nhóm photphat. Nhóm photphat của nucleotit này liên kết với đường của nucleotit tiếp theo tạo nên “cột sống” phân tử gồm các nhóm photphat và đường luân phiên, từ đó có các base nhô ra. Mạch poly nucleotit có tính định hướng từ đầu 5’ (với nhóm phosphate) tới đầu 3’ (với nhóm -OH). 5’ và 3’ là các số chỉ các nguyên tử carbon nằm trên cấu trúc vòng của phần đường. - Mô hình cấu trúc không gian: Chuỗi xoắn kép bao gồm 2 mạch đơn DNA xoắn song song ngược chiều nhau và xoắn về phía bên phải “xoắn phải” theo hướng đi lên. Hai mạch chuỗi xoắn được giữ lại với nhau qua các liên kết hidro hình thành giữa các base nito kết thành từng cặp bên trong chuỗi xoắn. Liên kết cộng hoá trị mạnh làm nhiệm vụ nối các nucleotit trên một mạch với nhau, trong khi hai mạch đơn được liên kết với nhau bởi liên kết yếu - liên kết hidro. Các cặp base xếp chồng lên nhau và hình thành giữa chúng là lực hấp dẫn Van de Waals - yếu tố chính giúp giữ toàn bộ phân tử với nhau. Mỗi NST ở sinh vật nhân thực đều chứa một phân tử DNA xoắn kép mạch thẳng duy nhất được đóng gói cùng với các phân tử protein; ở người, kích thước trung bình vào khoảng 1,5 x 108 cặp nucleotit. Lượng DNA là lớn hơn nhiều so với chiều dài NST khi co xoắn cực đại. Nếu duỗi thẳng, mỗi phân tử DNA ở hệ gen nhân ngừoi có
DẠYKÈMQUYNHƠN
101
chiều dài trung bình hơn 4 cm, tức là dài hơn hàng nghìn lần so với đường kính của nhân tế bào - dó là chưa kể đến 45 NST khác còn lại đồng thời có mặt trong nhân tế bào. Trong tế bào, DNA của sinh vật nhân thực kết hợp chính xác với một lượng lớn protein. Phức hợp DNA với proten được gọi là chất nhiễm sắc, có thể gói gọn vào trong nhân tế bào nhờ hệ thống đóng gói DNA ở nhiều cấp độ khác nhau.
OFFICIAL
Trong chu kì tế bào, NST phải trải qua những thay đổi về cấp độ đóng gói. Khi tế bào chuẩn bị nguyên phân, chất nhiễm sắc cuộn xoắn (cô đặc), cuối cùng ở kì giữa hình thành nên một số lượng đặc trưng các NST có kích thước ngắn và dày có thể phân biệt được bằng kính hiển vi quang học. NST là một cấu trúc năng động, có thể cô đặc, dãn xoắn, biến đổi thậm chí thay đổi cấu hình theo yêu cầu của các quá trình khác nhau trong tế bào ví dụ như nguyên phân, giảm phân và quá trình biểu hiện của các gen. Các protein histone không chỉ đơn thuần là các lõi cuộn chỉ để DNA có thể quấn quanh trong cấu trúc chất nhiễm sắc. Sự biến đổi hoá học của các protein có vai trò trực tiếp làm thay đổi mức độ tổ chức của chất nhiễm sắc và tham gia điều hoà sự biểu hiện của các gen. Terry Orr - Weaver cùng với cộng sự của mình đã tiến hành các nghiên cứu ở Drosophila và chỉ ra rằng sự photphoryl hoá của một số amino acid đặc thù trong vùng đuôi histone có vai trò quyết định động thái của NST trong kỳ đầu Giảm phân I. Sự photphoryl hoá các biến đổi hoá học của các histone có nhiều tác động đến sự hoạt động của các gen
Các biến đổi của histone
Vùng đầu N của histone (đuôi histone) trong mỗi nucleosome thường lòi ra ngoài nucleosome. Phần đuôi này có thể được tiếp cận và bị biến đổi bởi một số enzyme đặc biệt, chúng xúc tác cho việc bổ sung hoặc loại bỏ một số gốc hoá học đặc thù nào đó. Trong hiện tượng acetyl hoá histone, gốc (-COCH3) được gắn vào các các amino acid ở phần đuôi histone, trong khi đó hiện tượng khử acetyl là hiện tượng loại bỏ những gốc acetyl này. Khi lysine được acetyl hoá, điện tích dương của nó được trung hoà, làm cho đuôi histone không còn liên kết chặt với các nucleosome ở gần nữa (chính sự liên két chặt của đuôi histone vào nucleosome thúc đẩy sự cuộn xoắn của chất nhiễm sắc thành dạng cấu trúc kết đặc hơn). Một số gốc hoá học khác cũng có thể được gắn thêm vào hoặc loại bỏ khỏi các amino acid thuộc đuôi histone, như các gốc metyl và các gốc photphat. Việc bổ sung gốc methyl (-CH3) vào đuôi histone (methyl hoá) có thể thúc đẩy sự kết đặc hơn của các chất nhiễm sắc. Trong khi đó, việc bổ sung một gốc photphat vào một amino acid (phosphoryl hoá) gần amino acid bị methyl hoá sẽ gây ra hiệu ứng ngược lại.
Di truyền: Diễn biến kỳ sau Nguyên phân: đây là kì ngắn nhất của nguyên phân, chỉ diễn ra trong vài phút. Kỳ sau được bắt đầu khi các protein cohensin tách nhau ra. Sự kiện đó cho phép các NST chị em của mỗi cặp đột ngột tách nhau ra. Mỗi nhiễm sắc tử trở thành một NST đầy đủ, hai nhiễm thể con đã tách nhau ra đều di chuyển về hai cực đối
DẠYKÈMQUYNHƠN
102
lập của tế bào khi các vi ống thể động ngắn lại. Do các vi ống này gắn vào vùng tâm động, vùng tâm động sẽ di chuyển trước tiên. Tế bào dài ra khi các vi ống không thể động dài ra. Vào cuối kì sau, hai cực của tế bào có hai bộ NST hoàn chỉnh và tương đương nhau.
Hướng dẫn trả lời:
a. DNA liên kết với protein histon để hình thành nucleoxom:
- Gốc photphat phân bố dọc khung phân tử DNA làm cho phần ngoài phân tử tích điện âm suốt dọc chiều dài phân tử, tạo thuận lợi cho sự hình thành liên kết với các protein histon.
- Các axit amin tích điện dương như lizin hoặc arginin, chiếm hơn 1/5 tổng số các axit amin có trong protein histon giúp hình thành liên kết với gốc photphat trên phân tử DNA
OFFICIAL
- Có 14 điểm tương tác khác nhau giữa DNA với protein histon lõi. Ở mỗi tiếp điểm, khe phụ của DNA ở vị trí trực diện với lõi 8 phân tử histon (octamer) có khả năng hình thành gần 140 liên kết hidro với nhau.
b. Các đột biến làm các NST trong cặp tương đồng không phân ly bình thường về 2 cực tế bào trong kỳ sau của phân bào nguyên phân:
- Đột biến gen mã hóa các protein thể động (kinetochore) gắn kết tâm động của nhiễm sắc thể với thoi phân bào làm cho thoi phân bào không gắn được với nhiễm sắc thể.
- Đột biến gen mã hóa protein động cơ dịch chuyển các nhiễm sắc thể dọc theo thoi phân bào về hai cực của tế bào.
- Đột biến gen mã hóa protein cohensin gắn kết giữa hai nhiễm sắc tử của nhiễm sắc thể để hình thành nhiễm sắc thể kép, làm thay đổi cấu trúc, từ đó enzyme phân giải protein cohensin ở đầu kỳ sau không nhận diện được hoặc đột biến gen mã hóa enzyme phân giải protein cohensin làm cho các nhiễm sắc tử không tách ra khỏi nhiễm sắc thể kép đi về 2 cực của tế bào.
Câu 14 (Trích đề HSGQG 2016 ngày 2) Đa số vi khuẩn không chuyển hóa được xylytol để tạo năng lượng. Người ta tiến hành thí nghiệm chuyển một gen mã hóa enzyme phân giải xylitol vào E. Coli. Một dòng plasmid làm thể truyền được biển đổi để có một gen kháng ampicilin (ampR) và một gen mã hóa β galactozidaza có chứa trình tự nhận biết của enzyme cắt giới hạn EcoRI (β galactozidaza có khả năng phân giải X- gal từ không màu thành sản phẩm màu xanh dương).
Sau khi đoạn DNA chứa gen mã hóa enzyme phân giải xylitol và thể truvền được xử lý riêng rẽ với EcoRI, chúng được trộn với nhau để tái tổ hợp ngẫu nhiên.
DẠYKÈMQUYNHƠN
103
Hỗn hợp DNA này lại tiếp tục được cho biến nạp vào một chủng E coli đã bị
đột biến bất hoạt gen Z trong operon Lac. Sau đó đem cấy trải trên môi trường thạch tối thiểu thu được 3 dòng A, B và C. Tiếp tục nuôi cấy riêng rẽ 3 dòng A, B, C trên môi trường thạch tối thiểu có bổ sung thêm ampiclin và X-gal thu được kết quả như sau:
Dòng A: Xuất hiện khuẩn lạc và không thay đổi màu
Dòng B: Xuất hiện khuẩn lạc và vùng xung quanh khuẩn lạc chuyển sang màu xanh dương
Dòng C: Không xuất hiện khuẩn lạc.
a. Giải thích kết quả thí nghiệm.
b. Nếu cả 3 dòng A, B, C được nuôi cấy riêng rẽ trong môi trường chỉ chứa xylitol làm nguồn cacbon duy nhất thì khả năng phát triển của mỗi dòng sẽ như thế nào? Giải thích?
OFFICIAL
Hướng đẫn vận dụng kiến thức
Kĩ thuật di truyền: Kĩ thuật nhân dòng gen bằng plasmid vi khuẩn: Các phân tử plasmid gốc được gọi là các vector nhân dòng, chúng được định nghĩa là các phân tử DNA có thể mang DNA ngoại lai vào tế bào chủ và sao chép ở đó. Các plasmid vi khuẩn được dùng làm vector nhân dòng vì một số nguyên nhân. Chúng có thể dễ dàng được phân lập từ các tế bào vì khuẩn, được thao tác để tạo nên các plasmid tái tổ hợp bằng việc cài đoạn DNA ngoại lai trong điều kiện invitro, sau đó được đưa trở lại các tế bào vi khuẩn. Hơn nữa các plasmid vi khuẩn tái tổ hợp (và đoạn DNA ngoại lai mà chúng mang) có thể nhân lên nhanh chóng nhờ tốc độ sinh sản cao của các tế bào chủ. Ứng dụng nhân dòng gen là quá trình tạo ra nhiều bản sao của một gen được quan tâm. Những bản sao này có thể được dùng trong giải trình tự gen, sản xuất các prtein do gen mã hoá hoặc trong các nghiên cứu cơ bản và ứng dụng khác. Ví dụ, các gen mã háo enzyme phân giải xylitol được cài vào plasmid có nguồn gốc từ E. coli. Kĩ thuật được tiến hành như sau:
1 - Phân lập DNA plasmid từ tế bào vi khuẩn và DNA mã hoá protein phân giải xylitol. Dòng plasmid làm thể truyền được biển đổi để có một gen kháng ampicilin (ampR) và một gen mã hóa β galactozidaza có chứa trình tự nhận biết của enzyme cắt giới hạn EcoRI (β galactozidaza có khả năng phân giải X- gal từ không màu thành sản phẩm màu xanh dương).
2 - Cắt cả hai mẫu DNA bởi cùng một enzyme giới hạn (trong trường hợp này là EcoRI)
3 - Trộn các plasmid đã được mở vòng với các phân đoạn DNA từ gen mã hoá enzym phân giải xylitol. Một số đoạn nối vứoi nhau bởi sự kết cặp giữa các base, DNA ligase nối chúng với nhau. Sản phẩm là các plasmid tái tổ hợp và nhiều plasmid không tái tổ hợp
DẠYKÈMQUYNHƠN
104
4 - Trộn DNA với các tế bào vi khuẩn có đột biến ở gen β galactozidaza của riêng nó. Một số tế bào tiếp nhận plasmid tái tổ hợp hoặc phân tử DNA khác qua biến nạp.
5 - Cấy rải vi khuẩn trên môi trường agar chứa ampicillin và X-gal. Nuôi vi khuẩn cho đến khi khuẩn lạc hình thành
Kết quả: Chỉ các tế bào tiếp nhận plasmid mang gen ampR mới có thể sinh sản và hình thành khuẩn lạc. Các khuẩn lạc mang plasmid không tái tổ hợp sẽ có màu xanh, các khuẩn lạc mang plasmid tái tổ hợp có gen β galactozidaza bị phá vỡ sẽ có màu trắng vì chúng không phân huỷ được X-gal.
Hướng dẫn trả lời: a. Giải thích kết quả thí nghiệm:
- Dòng A phát triển được trên môi trường có ampicilin => có plasmid chứa ampR. Khi nuôi trên X-gal thì màu của môi trường không đổi => gen β galactozidaza không được biểu hiện => có hiện tượng biến nạp plasmid tái tổ hợp.
- Dòng B phát triển được trên môi trường có ampicilin và chuyển hóa được Xgal làm môi trường chuyển sang màu xanh => có hiện tượng biến nạp plasmid không tái tổ hợp.
- Dòng C không phát triển được trên môi trường có ampicilin => không có hiện tượng biến nạp.
b. Khả năng phát triển của 3 dòng khi nuôi cấy trên môi trường có xylitol làm nguồn cacbon duy nhất:
- Dòng A có biến nạp plasmid tái tổ hợp tuy nhiên không thể chắc chắn plasmid tái tổ hợp này có gen chuyển hóa xylitol. Do đó:
+ Dòng A có thể phát triển được trên môi trường có xylitol nếu plasmid tái tổ hợp có chứa gen chuyển hóa xylitol hoàn chỉnh.
+ Dòng A sẽ không phát triển được trên môi trường chỉ chứa xylitol nếu plasmid tái tổ hợp không chứa gen chuyển hoá xylitol hoàn chỉnh.
- Dòng B có khả năng sử dụng lactozo (do có gen β galactozidaza trên plasmid hoạt động) nhưng không có khả năng sử dụng xylitol nên không phát triển được trên môi trường chi chứa xilitol.
- Dòng C không có biến nạp => không chuyển hóa được xylitol => không phát triển được trên môi trường có chửa xylitol.
Câu 15 (Trích đề thi IBO năm 2015)
Ở nấm mốc, sự sinh tổng hợp axit amin arginine cần bước chuyển hóa tiền chất thành ornithine; chất này được chuyển hóa tiếp thành citruline là tiền chất trực
DẠYKÈMQUYNHƠN
OFFICIAL 105
tiếp được chuyển hóa thành arginine. Mỗi phản ứng trong 3 bước này được xúc tác bởi một enzym riêng rẽ; mỗi enzym được mã hóa bởi một gen (xem hình)
OFFICIAL
A: Con đường sinh tổng hợp arginine ở nấm mốc. B: Thiết kế thí nghiệm để xác định chuyển hóa: dải màu nâu đen chỉ Nấm mốc sinh trưởng. Chủng kiểu dại mọc trên môi trường tối thiểu, trong khi các chủng đột biến chỉ mọc trên các môi trường được bổ sung (+) chất dinh dưỡng đặc thù.
Precursor: tiền chất
Ornithine: Ornithine
Citrulline: Citrulline
Arginine: Arginine
Enzyme: enzyme
Gene: Gen Wild type: Kiểu dại (WT)
Class I mutants: Các đột biến lớp I
Class II mutants: Các đột biến lớp II
Class III mutants: Các đột biến lớp III
+ Ornithine: + Ornithine: + Citrulline: + Citrulline: + Arginine: + Arginine
Mỗi phát biểu dưới đây là đúng hay sai?

DẠYKÈMQUYNHƠN
106
a, Các chủng đột biến lớp III có thể mang đột biến ở nhiều hơn 1 gen liên quan đến con đường sinh hóa này.
b, Các chủng đột biến lớp I thiếu cả 3 enzym.
c, Các thể đột biến thiếu hai enzym A và C có thể mọc nếu môi trường được bổ sung đồng thời Orthnithine và Citruline - (F, thiếu C thì ko mọc được trên môi trường có citruline)
OFFICIAL
d, Giả sử một chất ức chế enzym B được bổ sung vào môi trường nuôi chủng kiểu dại, gen B sẽ bị bất hoạt. (Bổ sung chất sau đột biến => chủng vi khuẩn sống được, bổ sung chất trước đột biến, không chuyển hoá được => vi khuẩn không sống được) Thứ tự đột biến: O -> C -> A Hướng dẫn vận dụng kiến thức: Mối quan hệ giữa gen và enzyme: mối quan hệ này được làm sáng tỏ bởi Beadle và Edward Tatum nghiên cứu ở nấm mốc Neurospora crassa. Trên cơ sở các phương pháp gây tạo đột bién được tìm ra từ những năm 1920, các nhà khoa học đã dùng tia X “bắn phá” các chúng Neurospora để tạo nên các chủng đột biến có nhu cầu dinh dưỡng khác nhau so với kiểu dại. Các chủng nấm mốc Neurospora kiểu dại có nhu cầu dinh dưỡng đơn giản. Chúng có thể dễ dàng sống trên môi trường thạch (agar) được bổ sung một số muối vô cơ, đường glucose và vitamin biotin. Từ môi trường tối thiểu này, các tế bào nấm men có thể dùng các con đường chuyển hoá của chúng để tạo nên tất cả các phân tử cần thiết cho sự sinh trưởng và phát triển của mình. Beadle và Tatum đã xác định được rằng nhiều chủng đột biến không có khả năng sống trên môi trường tối thiểu do mất khả năng tổng hợp một chất thiết yếu nào đó. Để có thể nuôi các chúng đột biến dinh dưỡng này, Beadle và Tatum phải nuôi chúng trong môi trường đủ, gồm các thành phần của môi trường tối thiểu, được bổ sung thêm 20 loại axit amin và một số chất dinh dưỡng khác. Trong môi trường đủ, mọi thể đột biến đều có khả năng sống dù chúng không có khả năng tổng hợp một chất nào đó. Để phân tích đặc điểm của các dạng sai hỏng chuyển hoá ở các chủng đột biến dinh dưỡng (thể đột biến khuyết dưỡng) Beadle và Tatum đã tiến hành lấy mẫu từ quần thể tế bào đột biến được nuôi trong môi trường đủ, rồi cho các thể đột biến vào các ống nghiệm khác nhau. Trong mỗi ống nghiệm, ngoài môi trường tối thiểu, họ cho thêm một chất dinh dưỡng nhất định. Chất dinh dưỡng bổ sung đặc thù này cho phép nấm mốc đột biến có thể sinh trưởng được chứng tỏ sai hỏng chuyển hoá có liên quan đến chất này. Ví dụ, nếu chủng đột biến được tìm thấy có khả năng phát triển trong môi trường bổ sung amino acid arginine, thì các nghiên cứu kết luận rằng thể đột biến đó bị sai hỏng trong con đường chuyển hoá tổng hợp arginine.
Beadle và Tatum sau đó tiếp tục xác định tính đặc thù của mỗi thể đột biến
DẠYKÈMQUYNHƠN
107
Thí nghiệm kiểm tra liệu các gen riêng rẽ quy định các enzyme xúc tác cho các phản ứng trong một con đường hoá sinh? Thí nghiệm được nghiên cứu ở Neurospora crassa, Geogre Beadle và Edward Tatum tại đại học Stanford đã phân lập được các thể đột biến cần bổ sung arginne vào môi trường sinh trưởng của chúng. Các nhà nghiên cứu thấy rằng các đột biến này chia thành 3 nhóm, mỗi nhóm sai hỏng một gen khác nhau. Cân nhắc trên các dữ liệu thí nghiệm, họ dự đoán con đường sinh tổng hợp arginine liên quan đến một tiền chất trong môi trường sinh dưỡng và các phân tử trung gian là ornithine và citrulline. Thí nghiệm nổi tiếng của họ được minh hoạ chứng minh cho giải thiết một gen - một enzyme đồng thời xác nhận con đường tổng hợp arginine. Thí nghiệm được tiến hành bằng cách nuôi ba nhóm thể đột biến nấm mốc trong 4 điều kiện môi trường khác nhau như hình minh hoạ. Trong thí nghiệm, họ đã sử dụng môi trường tối thiểu (MM) làm đối chứng do môi trường này các tế bào kiểu dại có thể sinh trưởng, trong khi các tế bào đột biến thì không Kết quả thu được: Chúng kiểu dại có khả năng sinh trưởng trong tất cả các điều kiện thí nghiệm khác nhau, chỉ đòi hỏi môi trường tối thiểu. Trong khi đó, ba nhóm thể đột biến đều cần bổ sung những chất dinh dưỡng đặc thù cho mỗi nhóm. Ví dụ các thể đột biến nhóm II không sinh trưởng được trong môi trường chỉ bổ sung ornithine, mà sinh trưởng trong các môi trường bổ sung citrulline hay arginine. Kết luận: Từ những yêu cầu về nguồn dinh dưỡng của các thể đột biến, Beadle và Tatum đã suy luận ra rằng mỗi nhóm thể đột biến không thể thực hiện được một bước trong con đường sinh tổng hợp arginine, mà theo giả thiết là do chúng thiếu những enzyme đặc thù. Do mỗi nhóm thể đột biến bị đột biến ở một gen duy nhất, họ kết luận rằng mỗi gen bình thường quy định việc tế bào sản xuất một enzyme. Kết quả nghiên cứu ủng hộ cho giả thiết một gen - một enzyme và đồng thời cũng xác nhận con đường chuyển hoá tổng hợp arginine (chú ý trong phần kết quả là các thể đột biến chỉ sinh trưởng được trong các môi trường bổ sung một hợp chất hình thành sau bước sai hỏng của quá trình chuyển hoá, vì điều này mới có thể giúp khắc phục sai hỏng)
OFFICIAL
Câu 16 (Trích đề thi HSGQG 2017 - ngày 1)
Nấm men kiểu dại có khả năng phân giải glucose thành etanol và khí cacbonic trong điều kiện thiếu oxi. Khi xử lý đột biến, người ta thu được chủng nấm men mang đột bi
DẠYKÈMQUYNHƠN
108
n
nghệ
Ở nấm men
ấ
Sau
ến suy giảm hô hấp do thiếu xitocrom oxidaza - một thành phần của chuỗi vận chuyển điệ
tử. Việc sử dụng chủng nấm men này có ưu thế gì so với chủng kiểu dại trong công
lên men rượu? Giải thích?
m
t khả năng lên men, đường phân có thể diễn ra trong điều kiện thiếu oxi không? Tại sao?
đây là hai phản ứng thuộc quá trình đường phân: Glyxeraldehit-3-photphat + NAD+ + Pi → 1,3-Bisphotphoglixerat + NADH 1,3 Bisphotphoglixerat + ADP → 3-Photphoglixerat + ATP
Photphat vô cơ (Pi) có vai trò thiết yếu trong quá trình lên men. Khi nguồn cung cấp Pi cạn kiệt, sự lên men bị dừng lại kể cả khi môi trường có glucose. Asenat (AsO4 3-) tương đồng với photphat (PO4 3-) về cấu trúc hóa học và có thể làm cơ chất thay thế photphat. Este asenat không bền nên dễ thủy phân ngay khi vừa hình thành. Giải thích tại sao asenat gây độc đối với tế bào?
Hướng dẫn vận dụng kiến thức:
Hoá sinh: quá trình đường phân phân giải glucose
Vi sinh: Dị hoá ở nấm men
Di truyền: biến dị ở vi sinh vật nhân thực
Hướng dẫn trả lời:
Việc sử dụng chủng nấm men đột biến có ưu thế trong việc đơn giản hóa điều kiện lên men vì không cần phải duy trì điều kiện kị khí như đối với nấm men kiểu dại
OFFICIAL
- Nấm men là vi sinh vật kị khí không bắt buộc. Trong điều kiện thiếu O2, nấm men sẽ lên men rượu. Trong điều kiện có O2, nấm men sẽ tiến hành hô hấp hiếu khí. Do đó, phải duy trì điều kiện kị khí để tiến hành lên men. Trong công nghệ lên men rượu, việc duy trì điều kiện kị khí đòi hỏi chi phí thục hiện.
- Xitocrom oxidaza là một thành phần của chuỗi vận chuyển điện tử. Nếu thiếu enzyme này chuỗi vận chuyển điện tử bị ngừng trệ. Chu trình Crep cũng bị ngừng do thiếu NAD+ từ chuỗi vận chuyển điện tử. Do đó, nấm men sẽ chuyển sang lên men rượu ngay cả khi có O2.
b) Quá trình đường phân sẽ không diễn ra ở nấm men mất khả năng lên men trong điều kiện thiếu O2. Vì quá trình đường phân tạo nên một lượng lớn axit pyruvic và NADH làm giảm tỉ lệ [NADH]/[NAD+]. Trong điều kiện thiếu O2, chuỗi vận chuyển điện tử bị ức chế nên không tạo ra NAD+ . Nếu không có quá trình lên men, lượng NAD+ không được tái tạo dẫn đến quá trình đường phân không thể diễn ra.
c) Khi có asenat, 1-asenat-3-photphoglixerat (este asenat) được hình thành thay cho bisphotphoglixerat. Khi đó, este asenat bị thủy phân thành 3-photphoglixerat.
(1-asenat-3-photphoglixerat + H2O → 3-photphoglixerat + AsO4 3-)
Phân tử 3-photphoglixerat vẫn được tạo thành như trong quá trình đường phân nhưng không kèm theo sự tổng hợp ATP dẫn đến sự giảm năng lượng tạo thành trong các phản ứng tương tự. Vì vậy, asenat độc đối với tế bào.
Câu 17 (Trích đề HSG 2017 ngày 1)
Virut cúm A/H5N1 lây truyền bệnh ở người và gia cầm, còn virut cúm A/H3N2 chỉ lây truyền bệnh ở người. Giả sử, người ta tạo được virut lai bằng cách tách hệ gen
DẠYKÈMQUYNHƠN
109
(RNA) của virut cúm A/H5N1 ra khỏi vỏ capsit của nó, rồi chuyển vào đó hệ gen (RNA) của virut A/H3N2.
Trình bày giai đoạn sinh tổng hợp (nhân lên) của virut lai vừa tạo ra (thế hệ 0) sau khi xâm nhập vào tế bào người. Biết rằng virut cúm A có hệ gen RNA (-) và phiên mã tổng hợp mRNA từ khuôn RNA hệ gen của nó.
Virut lai thế hệ 1 có khả năng lây truyền bệnh ở gia cầm không? Giải thích Nếu như gen mã hóa gai glycoprotein H (hemagglutinin) bị đột biến ở chủng gốc A/H5N1 thì phần lớn virut lai vừa tạo ra (thế hệ 0) sẽ thay đổi khả năng lây nhiễm ở người như thế nào? Giải thích? Hướng dẫn vận dụng kiến thức: Cấu trúc virut: Virut không có cấu trúc tế bào, cấu tạo đơn giản chỉ gồm vật chất di truyền (DNA hoặc RNA: sợi đơn hoặc sợi kép) được bao bọc bởi một vỏ protein. Trong một số trường hợp có thêm vỏ bọc bên ngoài ...
Vật chất di truyền ở virut RNA: RNA là vật chất di truyền ở một số virut. Mặc dù phage và phần lớn virut thực vật là các virut RNA, nhưng dạng biến thể đa dạng nhất của hệ gen RNA được tìm thấy ở các virut lây nhiễm động vật. Trong ba loại hệ gen RNA mạch đơn được tìm thấy ở các virut động vật, các hệ gen là RNA mạch đơn (ssRNA-RNA+) có thể dùng trực tiếp như mRNA, tức là nó có thể được dùng trực tiếp để dịch mã ngay sau khi lây nhiễm. Một số virut khác hệ gen cũng là phân tử RNA mạch đơn (ssARRN- RNA-) nhưng hệ gen đó RNA của nó được dùng làm khuôn để tổng hợp nên mRNA. Hệ gen này được dùng để phiên mã thành mạch RNA bổ sung; mạch RNA bổ sung này vừa được dùng như mRNA, vừa được dùng làm khuôn để tổng hợp các bản sao RNA mới của virut. Tất cả các virut cần quá trình tổng hợp RNA -> RNA để tạo nên mRNA đều được sử dụng một enzyme của virut để thực hiện quá trình này; không có những enzyme như vậy trong phần lớn các tế bào chủ. Các enzyme của virut được đóng gói cùng với hệ gen bên trong lớp vỏ capsid. Các virut RNA ở động vật có chu kỳ sinh sản phức tạp nhất là các retrovirus. Những virus này được trang bị một enzyme có tên là enzyme phiên mã ngược (hay reverse trancriptase); enzyme này có thể phiên mã mạch khuôn RNA thành DNA, tạo nên dòng thông tin RNA, ngược chiều với thông thường.
Hướng dẫn trả lời:
Virut cúm sử dụng RNA polymerase của nó và nguyên liệu của tế bào chủ để (phiên mã) tổng hợp mRNA (RNA +) trên khuôn RNA của nó (RNA -).
Các mRNA (RNA +) mớiđược tổng hợp được dùng làm khuôn để tổng hợp các RNA hệ gen mới (RNA -) của virut, đồng thời được dùng làm khuôn để tổng hợp (dịch mã) protein vỏ capsit và vỏ ngoài để lắp ráp thành virut mới.
Virut lai thế hệ 1 không lây truyền bệnh ở gia cầm
DẠYKÈMQUYNHƠN
OFFICIAL 110
Vì, hệ gen của virut lai thế hệ 0 là từ virut cúm A/H3N2 nên sẽ tạo ra thế hệ 1 là A/H3N2 không lây truyền bệnh ở gia cầm (trừ trường hợp đột biến xảy ra ngay trong lần tái sinh virut thế hệ 0)
Nếu gen mã hóa cho gai H bị đột biến thì phần lớn virut lai không lây nhiễm (hoặc giảm) ở người
Vì virut không có khả năng đính kết không có khả năng đính kết lên tế bào chủ (qua thụ thể) nên không xâm nhập được vào tế bào vật chủ.
Câu 18 (Trích đề thi HSGQG 2018 - ngày 1)
Khi một enzyme có mặt ở một loài vi khuẩn, thì con đường chuyển hoá mà enzyme đó tham gia thường tồn tại trong loài vi khuẩn này. Bảng 1.1 là tên enzyme và phản ứng mà enzyme xúc tác được sử dụng làm chỉ thị cho sự xuất hiện của các con đường chuyển hóa mà nó tham gia. Bảng 1.2 thể hiện sự có mặt hay vắng mặt của một số enzyme ở bốn loài vi khuẩn khác nhau 1,2, 3 và 4.
OFFICIAL
Bảng 1.1. Enzyme và phản ứng xúc tác tương ứng
Tên enzyme Phản ứng xúc tác Lactat đêhiđrôgenaza (LDH)
Alcohol đêhiđrôgenaza (ADH)
Xitôcrôm C oxidaza
ATP sintetaza
Axit piruvic + NADH → axit lactic 4NAD+
Axêtanđêhit 4- NADH → Êtanol + NAD+
Vận chuyển electron từ xitôcrôm C tới xitôcrôm a
Vận chuyển H+ qua màng tạo ATP từ ADP và Pi
Xitrat sintetaza
Axit oxalo axetic + Axetyl coA -> axit xitric
Bảng 1.2. Sự có mặt (+) và vắng mặt (-) của mỗi loại enzyme trong từng loài vi khuẩn
DẠYKÈMQUYNHƠN
111
Hãy cho biết:
a) Loài vi khuẩn nào không thể thực hiện được hô hấp hiếu khí? Giải thích.
b) Các sản phẩm chính mỗi loài vi khuẩn tạo ra sau quá trình chuyển hóa glucozo?
Tên enzyme
Loài vi khuẩn
LD H ADH Xitô crôm c oxidaza
Loài 1 - + - + -
Loài 2 + - - + -
Loài 3 + - + + -
OFFICIAL
ATP sintetaza Xitrat sintetaza
Loài 4 - + + + +
Hướng dẫn vận dụng kiến thức: Các giai đoạn của quá trình hô hấp tế bào: Đường phân: xảy ra trong bào tương, bắt đầu quá trình phân giải nhờ bẻ gẫy gluocse hình thành hai phân tử có tên là pyruvate.
Chuyển hoá saccharide: Chu trình axit citric xảy ra bên trong chất nền ti thể của tế bào nhân thực hay đơn giản trong bào tương của tế bào nhân sơ, hoàn thành sự phân giải gluocse nhờ oxi hoá một dẫn xuất của pyruvate thành carbon dioxide. Do đó CO2 tạo ra do hô hấp là mảnh vỡ của các phân tử hữu cơ bị oxi hoá. Một số bước của đường phân và chu trình axit citric là các phản ứng oxi hoá khử trong đó dehydrogenaza chuyển electron từ cơ chất đến NAD+ để tạo NADH.
Hướng dẫn trả lời a)
- Các vi khuẩn không thể thực hiện được hô hấp hiếu khí gồm: loài 1, loài 2, loài 3.
- Loài 1 và loài 2 thiếu xitocrom c oxidaza là enzyme chính trong thành phần của quá trình hô hấp hiếu khí (enzym trong chuỗi truyền điện tử).
- Loài 3 thiếu enzyme citrat sintetaza của chu trình Crep b)
- Loài 1 tạo rượu etanol, CO2 và ATP.
- Loài 2 tạo axit lactic, ATP.
DẠYKÈMQUYNHƠN
112
- Loài 3 tạo axit lactic, ATP.
- Loài 4 khi có mặt oxi tạo CO2, H2O và ATP; khi không có mặt oxi tạo rượu etanol, CO2 và ATP.
Câu 19: Một nhà khoa học tiến hành nuôi cấy nấm men rượu (Saccharomyces cerevisiae) trong một dung dịch dinh dưỡng đơn giản, dùng glucose đánh dấu 14C làm nguồn và năng lượng duy nhất. Cô ta thấy rằng cứ lmol glucose bị oxy hóa hoàn toàn thì tế bào lại tiêu thụ 6mol oxi, và tạo ra 32ATP (1NADH = 2.5 ATP và 1FADH2 = 1.5 ATP).
a, Cô ta đã đo lượng 14C của hợp chất này để có thể nói rằng glucose đã bị oxy hóa hoàn toàn? Tên của quá trình cô ta nghiên cứu?
OFFICIAL
b, Khi chuyển dung dịch nuôi cấy trên sang môi trường yếm khí và tiếp tục nghiên cứu xem điều gì xảy ra vói glucose đánh dấu phóng xạ, cô ta nhận thây rằng các tế bào tiếp tục sinh trưởng nhưng không tiêu thụ oxi? Theo bạn, quá trình cô ta nghiên cứu đó là quá trình gì? Quá trình này tạo ra bao nhiêu ATP? Cô ấy sẽ đánh dấu 14C trong những hợp chất nào để nghiên cứu quá trình này?
c, So sánh năng lượng của hai quá trình kể trên và giải thích lý do tại sao có sự khác biệt đó?
Hướng dẫn trả lời
a, Hô hấp hiếu khí ở tế bào. Quá trình này diễn ra trong điều kiện hiếu khí. Chất cho electron là glucose và chất nhận electron cuối cùng là O2 để tạo H2O. Tổng số lượng ATP tạo ra là 32ATP với hiệu suất ~ 40%.
b, Khi đưa sang muôi trường yếm khí, các chủng nấm men này sẽ thực hiện quá trình lên men tạo các sản phẩm hữu cơ. Quá trình này tạo chỉ 2ATP từ đường phân. Cô ấy nên đánh dấu vào 14C vào các phân tử hữu cơ như lactacte hoặc ethanol. c, Năng lượng (sô ATP/glucose)
Yếm khí 32 2 Giải thích
Hiếu khí
Trong điều kiện hiếu khí, nấm men sẽ thực hiện chu trình Krebs. Năng lượng được tích lũy dưới dạng cơ chất (10NADH, 2FADH2) và được vận chuyển đến chuỗi truyền
Trong điều kiện kị khí, chất vận chuyên điện tử (NADH) sẽ được sử dụng để tạo lactate từ pyruvate nhờ enzyme lactate dehydrogenase
DẠYKÈMQUYNHƠN
113
electron. Sự giải phóng e làm động lực vận chuyên H+ từ chất nền ra xoang sẽ tạo sự chênh lệch H+ giữa hai bên màng. Khi có sự chênh lệch, H+ được quay trở lại chất nền thông qua phức ATP synthase và tổng hợp năng lượng ATP.
cũng có thể là ethanol nhờ alcohol dehydrogenase. Vì thế nên năng lượng chỉ tạo 2ATP hoặc 1 ATP/lglucose.

Câu 20: Hình dưới đây là thí nghiệm mà các nhà khoa học dựa trên giả thuyết cho rằng giữa sự vận chuyển electron từ NADH tới O2 có mối quan hệ với sự vận chuyển proton qua màng ty thể. Dựa vào biểu đổ với sự thay đổi độ pH trong khoảng thời gian (s) để chứng minh cho giả thuyết trên là đúng?
Hướng dẫn trả lời: Nếu NADH được đưa từ dịch huyền phù chứa ty thể thiếu oxy NADH sẽ không bị oxy hóa. Khi một lượng nhỏ oxy được thêm vào thí nghiệm, nồng độ proton trong môi trường quanh ty thể tăng đột ngột (pH giảm). Do đó sự oxy hóa NADH bằng oxy được kết họp với chuyển động của proton ra ngoài chất nền. Khi oxy hết, lượng proton dư thừa bên ngoài từ từ quay lại ty thể (cung cấp năng lượng tổng hợp ATP) và pH của môi trường bên ngoài trở về giá trị ban đầu. Điều đó chứng tỏ sự vận chuyển electron từ NADH tới oxy được cặp với vận chuyển proton qua màng ty thể.
Câu 21: Một liposome nhân tạo là điều kiện lý tưởng để nghiên cứu sự di chuyển electron trong chuỗi truyền điện tử thay vì sử dụng ty thể. Khi một chất cho và một
DẠYKÈMQUYNHƠN
OFFICIAL 114
chất nhận electron phù hợp được cho vào liposome, cùng với phức hệ IV (cytochrome c oxidase) gắn trên màng với mục đích nghiên cứu sự vận chuyển electron từ cytochrome c dạng khử đến O2. K+ gắn với valinomycin được đưa vào với mục đích cân bằng điện thế giữa màng trong và ngoài (K+ thường không thẩm thấu qua màng trong, nhưng valinomycin là một chất vận chuyển ion giúp mang K+ đi qua màng).
OFFICIAL
Khi thêm O2 vào bên trong, chất nào được tạo ra? Nêu cơ chế của quá trình đó.
Dựa vào đồ thị ở hình (b), giải thích tại sao khi lượng oxy được đưa vào thì có sự thay đổi pH như vậy?
Chất độc được dùng như vũ khí hóa học, để tự tử khi gián điệp phát hiện, để xử tử tù bằng hơi gas, được Đức Quốc Xã dùng để giết hành loạt người Do Thái, Chúng bám vào heme cq của cytochrome c oxidase. Giải thích tại sao chúng gây độc?
Hướng dẫn trả lời:
Khi thêm oxy sẽ được nhận electron từ quá trình khử cyt c2+ thành cyt C xúc tác hình thành H2O. PTHH: 2H+ y2O2 H2O
Dựa vào đồ thị ta thấy, lượng oxy khi được đưa vào làm độ pH giảm mạnh vì cytochrome c ở dạng khử (cyt c2+) được oxy hóa thành dạng oxy hóa (cyt c3+), electron được đưa đến oxy để tạo nước. Electron được vận chuyển vào thì đồng thời proton được đưa ra ngoài môi trường làm cho pH giảm mạnh.
Khi cytochrome dạng khử được oxy hóa hoàn toàn, proton lại trở về bên trong túi làm pH dung môi quay trở lại giá trị ban đầu.
Cyanide khi được đưa vào sẽ ngăn chặn vận chuyển electron, quá trình phosphoryl hóa - oxy hóa bị ngăn cản và làm ngừng trệ việc tổng hợp ATP.

Câu 22
Một số vi khuẩn sống trong điều kiện môi trường kiềm (pH = 10) và duy trì được môi trường nội bào trung tính (pH = 7).
Tại sao các vi khuẩn này không thể tận dụng sự chênh lệch về nồng độ ion H+ giữa hai bên màng tế bào cho ATP synthase tổng hợp ATP? Giải thích.
DẠYKÈMQUYNHƠN
115
Về lý thuyết, có thể thay đổi cơ chế hoạt động của rotor, trục bên trong và núm xúc tác trong ATP synthase (hình) như thế nào để tổng hợp ATP? Giải thích.

OFFICIAL
Hướng dẫn trả lời:
Sự chênh lệch nồng độ ion H+ giữa hai bên màng tế bào dẫn đến ion H+ đi từ trong ra ngoài. ATP synthase chỉ tổng hợp ATP khi ion H+ đi từ ngoài vào trong. Do đó, ATP không được tổng hợp.
Khi H+ đi từ ngoài vào, rotor làm trục quay ngược chiều kim đồng hồ (nhìn từ phía tế bào chất) làm núm xúc tác tổng hợp ATP. Do đó, về lý thuyết, có thể thiết kế rotor làm trục vẫn quay ngược chiều kim đồng hồ khi ion H+ đi từ trong ra ngoài để núm xúc tác tổng hợp ATP. Khi ion H+ đi từ trong ra ngoài, trục quay theo chiều kim đồng hồ, ATP bị phân giải. Do đó, thiết kế cơ chế hoạt động của núm xúc tác khi trục quay theo chiều kim đồng hồ vẫn tổng hợp được ATP.
Câu 23: Tính toán hiệu suất năng lượng trên số nguyên tử carbon giữa glucose và acid palmitic (16C). So sánh hiệu suất chuyển hóa năng lượng với glucose dựa trên số carbon. Acid béo là nguồn dự trữ năng lượng to lớn và hiệu quả của cơ thể. Chúng có gì đặc biệt khi được lựa chọn là nguồn dự trữ mà không phải chất hữu cơ khác? Hướng dẫn trả lời: Số vòng oxy hóa cần thiết để oxy hóa hoàn toàn một phân tử acid béo no có n nguyên tử carbon sẽ là: (n/2)-l. Palmitic (16C) sẽ có 7 vòng, phương trình tổng quát quá trình phân giải hoàn toàn một palmitic là: Acetyl CoA + CoA + FAD+ + NAD+ + H2O-> Cn 2- acetyl Co A + acetyl - CoA + FADH2+ NADH + H+
DẠYKÈMQUYNHƠN
116
H+, H+, H+
Stator
Số lượng ATP được tạo thành qua sự oxy hóa hoàn toàn một phần tử palmitic (16C) Giai đoạn phản úng Số coenzyme khử Số ATP tạo thành
Beta-oxi hoá 7 FADH2 10,5 7 NADH 17,5 Oxy hoá acetylCoA qua chu trình citric 8 FADH2 12 24 NADH 60 8
Hoạt hoá axit béo -2 Tổng cộng 106 Như vậy, quá trình oxy hóa acid béo đã tạo ra một số năng lượng lớn cho tế bào. Nếu tính hiệu suất năng lượng trên số carbon thì quá trình oxy hóa acid béo tạo ra nhiều năng lượng hơn so với quá trình oxy.
Câu 24:
Những trẻ sơ sinh với triệu chứng co bản như giảm đường huyết, kèm theo yếu cơ và chuột rút là dấu hiệu của bệnh do sự khiếm khuyết trong sinh tổng hợp cRNAitine, rối loạn vận chuyển vào tế bào hay bài tiết quá mức ở thận. Dựa vào những kiến thức bạn đã tìm hiểu ở trên, hãy đưa ra một giải thích ngắn gọn cho tình trạng này?
Hướng dẫn trả lời
Sự thiếu cRNAitine xảy ra do khiếm khuyết trong sinh tổng hợp cRNAitine, rối loạn vận chuyển vào tế bào hay sự bài tiết quá mức ở thận. Bệnh này thường xảy ra ở trẻ sơ sinh, đặc biệt là trẻ thiếu tháng. Đây là kết quả của sự suy giảm oxy hóa acid béo khi cRNAitine không đáp ứng, nguồn cung câp năng lượng suy giảm. Đồng thời, quá trình này cũng kéo theo việc lipid tích lũy nhiều làm yếu cơ và chuột rút. Câu 25: Cấu trúc của một lipoprotein đều bao gồm: một vỏ lưỡng vùng chứa một lớp phospholipid đơn (phospholipid), cholesterol, protein và một lõi kỵ nước chủ yếu là cholesterol ester hay triacylglyceride hoặc cả hai nhưng với lượng nhỏ các châ't béo trung tính. Hình dưới là mô hình lipoprotein mật độ thấp (LDL).
DẠYKÈMQUYNHƠN OFFICIAL 117
Thí nghiệm đánh dấu phóng xạ thể hiện mối quan hệ giữa tiền tố và sản phẩm trong quá trình hấp thu LDL của tế bào.
Để tạo điều kiện thuận lợi cho việc chuyển giao khối lượng của chất béo giữa các tế bào, các loài động vật đã tiến hóa một cách hiệu quả để gói hàng trăm đến hàng ngàn phân tử lipid trong một phương tiện vận chuyển đại phân tử hòa tan trong nước là lipoprotein. Cấu trúc của phần tử phù hợp như thế nào với vai trò vận chuyển chất béo?
Phương pháp nghiên cứu thực nghiệm đưa các hạt LDL vào tế bào bằng cách đánh dấu nguyên tử phóng xạ 125I bằng liên kết cộng hóa trị vào chuỗi bên của phân tử tyrosine trong apoB-100 trên bề mặt hạt LDL. Sau khi tế bào nuôi cấy được ủ nhiều giờ với các hạt LDL được đánh dấu, chúng ta có thể tính được số lượng các hạt LDL bám vào bề mặt tế bào, số hạt được lấy vào trong và thành phần apoB-100 của LDL bị tiêu enzyme thủy phân thành acid amin. Dựa vào đó, bạn hãy trình bày những sự kiện thay đổi trong quá trình nghiên cứu để chứng minh rằng sự kiện đó diễn ra theo một thứ tự: LDL liên kết với bề mặt tếbào và được lấy vào trong tế bào sau đó bị thủy phân.
Hướng dẫn trả lời Các lipoprotein này có lóp vỏ chứa apoprotein B (thường là B100) đảm nhận vai trò thụ thể giúp vận chuyển phân tử cholesterol vào trong tế bào.

Lớp vỏ lưỡng cực, mặt ngoài ưa nước làm cho các hạt hòa tan trong nước và bê' mặt bên trong kỵ nước.
Tiếp giáp với bề mặt kỵ nước là lõi của chất béo trung tính chủ yếu chứa cholesteron este, triacylglyceride cung cap cho tế bào thực hiện các nhiệm vụ khác nhau (tổng hợp steroid, năng lượng, thụ thể, …)
b. Nhìn vào sơ đồ ta thấy sự di chuyển của các phân tử LDL trong khoảng thời gian nhất định. Ban đầu, LDL liên kết trên bề mặt tế bào nhờ thụ thể là apoprotein B và di chuyển vào bên trong qua kênh vận chuyển. Tuy nhiên, sau khoảng 15-20 phút, thành phần của phân tử LDL bị thủy phân, trong đó apoprotein B bị enzyme thủy phân thành acid amin và được phát hiện bằng số lượng 125I. Sau khi apoprotein B bị tách ra
DẠYKÈMQUYNHƠN
118
OFFICIAL
khỏi cholesterol, các phân tử cholesterol di chuyển thực hiện chức năng sinh học của mình.
Câu 26.
a) Cơ chế gây đột biến tự phát? Tại sao tần số đột biến tự phát lại thấp? b) Các thể đột biến 1,2,3 được lai với các chủng có mất đoạn a và b, người ta chọn được một số thể tái tổ hợp kiểu dại. Dựa trên kết quả dưới đây, hãy xác định vị trí của mỗi đột biến (+ thể tái tổ hợp kiểu dại; - thể tái tổ hợp đột biến)?
Thể đột biến 1
Thể đột biến 2 Thể đột biến 3
Chủng mất đoạn a + - +
Chủng mất đoạn b - + +
Hướng dẫn vận dụng kiến thức: biến dị di truyền, cơ chế biến dị tự nhiên (trạng thái bazo nito, hoạt động tự sửa sai, yếu tố di truyền vận động, trao đổi chéo không cân, …)
Hướng dẫn trả lời
a) Cơ chế gây đột biến tự phát:
- Sự bắt cặp sai của các bazonito hiếm
- Phản ứng của các bazo, do các gốc tự do có tính oxi hóa mạnh
- Do bộ máy di truyền sửa sai
- Do yếu tố di truyền vận động
- Do trao đổi chéo không cân…
Tần số đột biến tự phát lại thấp vì:
- Đặc tính của DNA bền vững, cấu trúc ổn định và có cơ chế duy trì cấu trúc
- Do có quá trình sữa chữa đột biến trong quá trình tái bản và khi DNA bị tổn thương.
- Enzyme DNA polimeraza hoạt động rất chính xác.
b)
- Đột biến 1 không sinh ra kiểu dại với mất đoạn b, vì vậy nó phải nằm bên trong vùng tương ứng với mất đoạn b.
DẠYKÈMQUYNHƠN
OFFICIAL 119
- Đột biến 2 không sinh ra kiểu dại với mất đoạn a, vì vậy nó phải nằm trong vùng tướng ứng với mất đoạn a
- Đột biến 3 cho các kiểu dại với cả hai mất đoạn nên nó phải nằm ngoài cả hai đột biến mất đoạn.
Câu 27
Cho 3 chất dưới đây:
- Chất A có khả năng kháng khuẩn bằng cách ức chế các RNA polymerase trong tế bào vi khuẩn, do đó ức chế sự phiên mã dẫn đến prôtêin không được tổng hợp.
- Chất B là enzym glycoside hydrolase có khả năng phân giải thành peptidoglycan của tế bào vi khuẩn nên gây tan tế bào.
- Chất C ức chế sự sinh trưởng và phát triển của vi khuẩn do tác động vào quá trình tổng hợp axit folic.
OFFICIAL
Hình dưới đây biểu diễn đường sinh trưởng của một chủng vi khuẩn được nuôi cấy trong 3 bình chứa môi trường dinh dưỡng dạng lỏng trước và sau khi bổ sung một trong 3 chất A, B, C nói trên tại các thời điểm được thể hiện trên hình (vị trí mũi tên). Đường nét liền biểu diễn số tế bào sống đếm được; đường nét đứt biểu hiện tổng số tế bào chết và sống đếm được.
Bình 1. Bình 2. Bình 3.
Dựa vào đường sinh trưởng của vi khuẩn, hãy xác định chất nào đã được bổ sung vào môi trường nuôi cấy? Giải thích? Hướng dẫn vận dụng kiến thức: Hoá sinh tế bào vi sinh vật, cấu trúc tế bào vi khuẩn và sự mẫn cảm của thành tế bào với enzim glycoside hydrolase
Hướng dẫn trả lời: Bình 1 C Bình 2. A Bình 3. B Giải thích: Bình 1: số lượng t

DẠYKÈMQUYNHƠN
120
ế bào sống tương
tổng số lượng tế bào
ố
và chết chứng tỏ trường hợp
tế
ị chết
chỉ
ị ứ
trưởng. Vậy bình 1 là bỏ C
đương
s
ng
này các
bào không b
mà
b
c chế sinh
vào, không có folic nên vi khuẩn không sinh trưởng được.
Bình 2: số lượng vi khuẩn chết khá nhiều, nhưng khi đếm tổng số tế bào sống và chết thì không đổi, do các tế bào chế không bị tan ra nên vẫn đếm được, là do bỏ thêm A, không tổng hợp được prôtêin nên vi khuẩn bị chế nhiều.
Bình 3: số lượng tế bào sống giảm nhanh, cũng không đếm được số lượng tế bào chết, chúng tỏ tế bào đã bị tan, do bỏ B vào nên thành bị hòa tan, làm cho vi khuẩn bị tan luôn.
Câu 28: Hình sau mô tả các thí nghiệm của F. Griffith và Chase trên Streptococcus pneumoniae:
OFFICIAL
Trình bày vắ Bằng cách nào có thể xác định được vật chất di truyền trong các thí nghiệm trên là DNA chứ không phải là RNA hay protein?

Trong kĩ thuật di truyền, hiện tượng xảy ra ở thí nghiệm 4 được ứng dụng để làm gì? Em hãy nêu vắn tắt hạn chế của việc ứng dụng hiện tượng này?
Hướng dẫn vận dụng kiến thức: di truyền vi khuẩn - hiện tượng biến nạp
Hướng dẫn trả lời:
* Nội dung thí nghiệm:
- Thí nghiệm 1: Tiêm vi khuẩn R sống vào chuột => chuột sống.
- Thí nghiệm 2: Tiêm vi khuẩn S sống vào chuột => chuột chết.
- Thí nghiệm 3: Tiêm vi khuẩn S đã bị giết bởi nhiệt vào chuột => Chuột sống
- Thí nghiệm 4: Trộn vi khuẩn S chết với R sống tiêm vào chuột => Chuột chết => Phân lập được vi khuẩn S.
* Giải thích:
- Vi khuẩn R không có màng nhầy, không gây bệnh ở chuột trong khi vi khuẩn S có.
- Vi khuẩn S bị giết bởi nhiệt có vật chất di truyền đã truyền vào vi khuẩn R qua con đường biến nạp, biến R thành S và làm chuột chết.
DẠYKÈMQUYNHƠN
121
Xử lí hỗn hợp vi khuẩn S chết và R sống ở thí nghiệm 4 bằng DNAase, proteinase, RNAase thì thấy chỉ có thỉ nghiệm được xử lí bằng DNAase mới khử được hiệu quả của biến nạp.
- Hiện tượng biến nạp được ứng dụng để chuyển DNA tái tổ hợp vào trong tế bào nhận.
- Hạn chế: DNA tái tổ hợp đi qua các lỗ thủng trên màng tế bào nên hiệu quả biến nạp phụ thuộc vào kích thước DNA tái tổ hợp và kích thước lỗ thủng => Ảnh hưởng tới tỉ lệ sống của tế bào sau biến nạp.
Câu 29: Allopurinol một chất ức chế xanthine oxydase được tìm ra bởi hai nhà khoa học Gertrude Elion (1918-1999) và George Hitchings (1905-1998), nó sử dụng để điều trị bệnh gout (gút) mãn tính. Giải thích cơ sở hóa sinh cho điều trị bệnh này.
OFFICIAL
Allopurinol Oxypurinol
Hướng dẫn trả lời: Gout là bệnh về khớp do nồng độ uric trong máu và mô tăng cao. Khi bị Gout, khớp trở nên viêm, đau do lắng đọng một cách không bình thường các tinh thể urate natri.
Allopurinol là một chất tương tự purine; nó là một đồng phân cấu trúc của hypoxanthine (một purine tự nhiên trong cơ thê) và là một chất ức chế cạnh tranh với enzyme xanthine oxidase. Xanthine oxidase chịu trách nhiệm cho quá trình oxy hóa liên tiếp của hypoxanthine và xanthine, dẫn đến sản xuất acid uric, sản phẩm chuyển hóa purine của con người. Ngoài việc ngăn chặn sự sản xuất axit uric, sự ức chế của xanthine oxidase làm tăng hypoxanthine và xanthine. Khi hypoxanthine và xanthine

DẠYKÈMQUYNHƠN
122
l
ớn, chúng có thể ức chế tổng hợp hoặc chuyển vào tạo adenosine và guanosine monophosphate. Do đó, Allopurinol làm giảm sự hình thành acid uric và cũng có thể ức chế tổng hợp purine. Gout được điều trị hiệu quả bằng kết hợp giữa thuốc và dinh dưỡng. Các thực phẩm giàu nucleic và nucleotide được loại khỏi bữa ăn, kết hợp với việc sử dụng thuốc allopurinol.
Câu 30:
Trong một thử nghiệm được thực hiện vào năm 1962, một cysteine gắn với tRNA được thay thế bằng alanine. Những tRNA "lai" sau đó được thêm vào một hệ thống dich mã, đồng thời loại bỏ các cysteine-trNA. Khi kết quả phân tích protein được theo dõi, alanine đã được chèn vào mọi điểm trong chuỗi polypeptide nơi cysteine được cho là có mặt. Thông qua thử nghiệm này, cho biết vai trò của aminoacyl tRNA synthetases trong quá trình dịch mã bình thường?
OFFICIAL
Hướng dẫn giải Thử nghiệm này chứng minh rằng ribosome không kiểm tra acid amin được gắn vào tRNA. Khi một acid amin đã được kết họp với một tRNA, ribosome sẽ "tự do" kết hợp acid amin đó vào theo vị trí liên kết codon và anticodon. Do đó, có thể kết luận rằng một phần của việc đọc chính xác mã di truyền, là kết hợp của một codon trong một mRNA với đúng amino acid, được thực hiện bởi các enzyme synthetase một cách chính xác phù hợp với tRNA
Câu 31: Phép lai giữa các tế bào his+, leu+, thr+, pro+, mẫn cảm với str và các tế bào his-, leu-, thr-, pro-, kháng str, kéo dài 25 phút. Khi ngừng tiếp hợp, các kiểu gen có tái tổ hợp được xác định. Kết quả thu được ở bảng dưới đây. Hãy xác định các gen đầu tiên và trật tự có thể của các gen. Kiểu gen Số khuẩn lạc his+ 0 leu+ 12 thr+ 27 pro+ 6 Hướng dẫn vận dụng kiến thức: Quá trình giao nạ
ng dẫn trả lời: Chúng ta thấy rằng các tế bào thr+ nhiều nhất. Tần số đứt gãy ống tiếp hợp tăng với sự tăng thời gian tiếp hợp. Vì vậy các gen ở càng xa điểm khởi đầu truyền gen sẽ xuất hiện với tần số càng nhỏ. Chúng ta có thể sắp xếp các gen một cách tương đối dựa trên tần số của các kiểu gen phát hiện được. Trật tự đó là thr leu pro his. Vì không thấy
DẠYKÈMQUYNHƠN
123
p (tiếp hợp) ở vi
ẩn Trong quá trình tiếp hợp, một
ầ
ằ
khởi đầu quá trình truyền
Hướ
khu
gen có t
n số truyền gen cao phải n
m gần với điểm
gen.